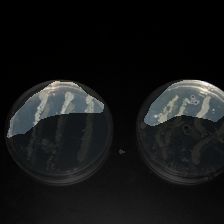
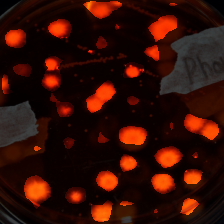
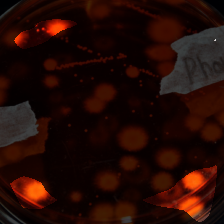
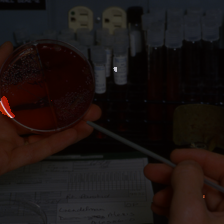
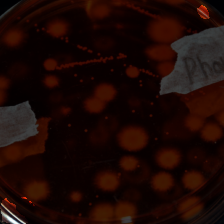

layer3-226
human annotations
- a person wearing a facemask
- wool, stairs and other patterned objects
- areas with repetitive patterns
layer2-117
human annotations
- points on a refrigerator, spaces on top of a shirt
- brown dogs
- blue areas in pictures
layer3-521
human annotations
- animal eyes or the corners of books and signs
- eyes and objects that resemble them
- eyes
layer3-906
human annotations
- spots of objects with lines
- light reflections
- dark dogs
layer4-854
human annotations
- animals and water
- human hands
- people and dogs and animals
layer4-1335
human annotations
- chains, poles and animals
- long, thin objects
- brown snakes
layer2-303
human annotations
- trees and animal parts
- areas with a line through them
- nature, statue
layer2-137
human annotations
- yellow, red, and orange colors
- orange objects
- orange areas in picture
layer2-278
human annotations
- spots of the color white and orange
- metal objects
- the lipsticks and cupcakes are in groups
layer3-892
human annotations
- screens and electronics
- monitors for different devices
- text in them
layer4-611
human annotations
- buildings, vehicles and clothes
- rooftops
- edges of objects
layer2-163
human annotations
- objects bordering the color blue
- birds
- brighter areas in objects
layer4-235
human annotations
- ties and cones
- include items that are on top of other objects
- animal, person, collar, food
layer4-301
human annotations
- animals and sticks
- birds
- show two items that are connected
layer4-1474
human annotations
- a tractor, a cup of coffee, a house, a cup of beer, a golf cart
- circular objects
- animals, insect, nature
layer4-1475
human annotations
- dogs going down the road, a cross on a wall. leaf
- tan and textured
- items with straight features
conv1-13
human annotations
- a clock
- nothing
- clothing, animals, athletes, and instruments are all displayed
layer2-139
human annotations
- the eyes of people and animals
- a fox staring forward, a dog posing for a photo, aquatic life, a group of kids playing basketball. a couple kids on a canoe
- brighter areas in objects
layer4-365
human annotations
- gray objects with multiple lines
- vertical legs, ropes and columns
- grill looking things
layer4-585
human annotations
- fountains, water towers, and balls
- fountains and water
- water and sky and fire
layer4-2041
human annotations
- faces of people, a cup, a lizard
- people, animals and yellow objects
- two items that are connected
layer4-1974
human annotations
- this people, shells, furniture and bells
- hat like things
- areas with curved features
layer3-441
human annotations
- necks of different birds
- things that look like wheel spokes
- spots of color
layer3-982
human annotations
- the color white and edges
- curve fruit, clothes and poles
- curvatures of different objects
layer4-1216
human annotations
- yellow objects and vehicles
- yellow objects
- objects with patterns or texture
layer3-737
human annotations
- walls, round and designs
- white spots
- logo, radio, socks, pavement
layer4-1473
human annotations
- monument, child
- animals, books, rafts and toys
- items with straight features
layer4-1696
human annotations
- people holding cameras and animals
- dogs posing for photos, people taking pictures
- items that are connected
layer2-202
human annotations
- the color yellow and black dots
- small dots of different colors
- brighter areas in objects
layer3-455
human annotations
- dots on animals and flooring
- dogs
- brighter areas in objects
layer4-435
human annotations
- feathers, dresses and animals
- multi-colored accessories
- pictures. similar color
layer4-332
human annotations
- satellite dish, stand at the tracks, steps
- animals, towers and stairs
- animals or have a triangular structure
layer4-1651
human annotations
- animals and things with black dots
- items or dogs that have black spots or eyes on them
- chair, person, toaster, cooking tinsel
layer4-1846
human annotations
- a person by a swimming pool, a dog in the grass
- animals and people
- items on other items
layer1-142
human annotations
- aquatic life and the ocean
- blank spots with color
- sign, animal, logo
layer2-260
human annotations
- edges and corners of images
- dots on animals and phones
- around living things
layer3-144
human annotations
- branches and the tan color
- mushrooms
- a ragged texture to them
layer4-966
human annotations
- boxes and electronics
- electronic devices with keyboards
- keys
layer4-626
human annotations
- animals and corners
- long, thin objects
- hands of people
layer4-1783
human annotations
- a keyboard, a hog, a matress, a crab
- animals, laptops, and domes
- items with curved items
layer4-1891
human annotations
- birds standing up
- long, thin items
- vertical line patterns
layer3-298
human annotations
- cell phones
- areas that look like keys on a keyboard
- the front of objects
layer3-451
human annotations
- the sky at the top of an image
- part of the area above an object
- region above subject
layer3-811
human annotations
- animal eyes and noses
- eyes of animals
- eyes of animals
layer4-497
human annotations
- shirts
- jacket being worn by person
- red coats and tops
layer4-1406
human annotations
- a person in camo, food on a plate
- people, grass, food and water
- person, food, bridge
layer4-2016
human annotations
- a dog on the grass, a statue on a roof
- animals and shelves
- the sky, animal
layer2-405
human annotations
- a bird walks through a grass, cat
- pink
- various red objects
layer3-374
human annotations
- pale spots
- straps of shirts
- shows light images that are curved
layer4-170
human annotations
- arms, legs, and sticks
- skinny poles
- area where action is taking place by an animal or human
layer4-751
human annotations
- animals, electronics, and food
- small animals and hands
- edges of objects
layer4-957
human annotations
- vehicles, animals and circular objects
- vehicles, animals and circles
- furry animals
layer4-1390
human annotations
- a bus in the distance, a tractor, a dog laying down, hyena, a snake
- animals and vehicles
- items with angles
layer2-134
human annotations
- turtles on the ground, birds on the ground, mama's
- yellow objects
- the front of the image
layer2-171
human annotations
- dotted material
- patterned fabric
- long bumpy and rounded textures
layer4-446
human annotations
- windows and tents
- object composed of lines
- square edges
layer4-297
human annotations
- walls
- red and orange objects
- thick lines through them
layer4-2023
human annotations
- people on the grass, crutches, baby. cat on a monitor
- babies, animals and bottle shaped things
- people, logo, sewer grate
layer4-1679
human annotations
- airplane in the sky, a person doing tricks on a bike, a hole in the ground
- long thin objects attached to larger objects
- long, thin items
conv1-27
human annotations
- a row of slot machines
- blue and red objects
- blue areas in pictures
layer3-460
human annotations
- objects that are in pairs
- the edge of two round things next to each other
- two of the same object next to each other
layer4-49
human annotations
- hands and bricks
- human hands
- items that are held
layer4-340
human annotations
- towers, legs and boxes
- white vertical structures
- grassy areas
layer4-804
human annotations
- a cross on the front of a church, a front of a building, a greenhouse with a dog standing in front, a group of students in a classroom
- lamps, menus,, buildings and walls
- rock walls
layer4-1888
human annotations
- animals with fur
- a star fish, a soldier in a old photo, a kit, a dog
- animals and objects that resemble them
layer3-352
human annotations
- spaces on the left and right side of a bag
- rounded corners of objects
- netting material
layer3-693
human annotations
- skin of white people
- arms and shiny metal objects
- white skin
layer4-402
human annotations
- animals and grass
- dirt areas
- this region contains edges where two items meet
layer4-718
human annotations
- animals, pens and fruit
- items that are connected
- insect, flag
layer4-1091
human annotations
- shelves, paths and things on shelves
- rows of shoes
- clothing
layer1-6
human annotations
- tree branches
- pale spots
- areas in the middle of objects
layer3-14
human annotations
- square corners
- vehicle grilles
- corner or edges of things
layer2-271
human annotations
- dots outlining a animal
- pale areas around a dark object
- rounded areas in them or something sticking out
layer4-573
human annotations
- pyramid shaped objects and tools
- poles and furniture
- two objects that come to a point that almost form a triangle
layer4-616
human annotations
- a bandaid, a barrel, a old mill
- windows, ships, and circular objects
- cylinders
layer4-2002
human annotations
- a sign in the sand, a tatoo on a arm, a toy a dog is playing with, space on the left side of a dog, bird, remote
- animals, remotes, and cups
- items on other objects
layer4-1729
human annotations
- chests and necks of people
- a face of dog, faces of people, a light pole
- areas with lines
layer3-1
human annotations
- woolen objects
- yarn and rope
- colorful objects
layer3-110
human annotations
- the color or lettering on the side of vehicles
- trucks
- horizontal lines on cars
layer3-757
human annotations
- the cheeks of faces
- buttons, people and wheels
- faces and letters and numbers
layer4-1155
human annotations
- animals and square objects
- light switches
- cubed objects
layer4-1749
human annotations
- animals and poles
- a object sticking up from the base
- lighter areas in pictures
layer1-253
human annotations
- boarder of a photo
- white backgrounds, text
- around pictures
layer3-241
human annotations
- a face mask, a old iron
- edges
- the space side a bed
layer4-256
human annotations
- animals
- heads of brown dogs
- animals in the foreground and background
layer3-818
human annotations
- walls
- white walls and dogs
- walls with different colors
layer4-1310
human annotations
- spots of fur and edges of objects
- the corner outlines
- above an object
layer4-1026
human annotations
- food objects and grass
- animals and food
- people holding items
layer3-192
human annotations
- eyes and green plants
- parts of brightly colored things
- person
layer3-246
human annotations
- an ambulance
- outlines of animals, people and vehicles
- animal
layer4-81
human annotations
- shirts, cars, fences and animals
- dogs
- person, animal, insect, car, railing
layer3-539
human annotations
- dog mouths and legs and telescopes
- mouths of dogs
- parts of dogs and people
layer4-1195
human annotations
- vehicles and white objects
- areas with straight edges
- white objects
layer4-878
human annotations
- animals and lighting
- textured objects
- shaggy brown dogs
layer2-499
human annotations
- fruits and vegetables, monkeys from trees, animals on the ground
- dots on the background or in apples
- monkeys
layer3-61
human annotations
- corners of food and plates
- bowls, plates and area around animals
- food
layer3-694
human annotations
- bodies of animals
- regions with curved areas
- animal
layer4-419
human annotations
- people and animals
- faces and objects that resemble them
- dark dogs
layer4-1984
human annotations
- a lego truck, a school bus going down the street, a dog laying down, wheels of a car
- legs and wheels
- brown legs of dogs and vehicles
layer4-1614
human annotations
- homes, animals and switches
- straight features
- window, person, animal
layer1-192
human annotations
- shoes and dogs
- portions of white areas
- shoes, animals, person, labels
layer2-62
human annotations
- stripes patterns
- striped objects
- the shapes of these have spokes throught
layer4-108
human annotations
- animal heads and objects that resemble them
- faces of dogs and other animals
- nature, animal
layer4-288
human annotations
- dogs and trains
- the bottoms of objects
- train, truck, barrel, dog, food
layer4-1022
human annotations
- backgrounds mostly in white or green
- green and white colors
- animal, person, fence
layer1-108
human annotations
- aquatic life, jewelry, my player
- colorful dots mostly of red and green
- red stripes and designs
layer3-482
human annotations
- patches of black and red
- spots of the color white
- similar patterns
layer3-888
human annotations
- vehicles, pans, things with different colors
- tips and corners of objects
- edges of objects
layer4-748
human annotations
- animals and cookware
- bugs
- animal, mountain, insect
layer4-1398
human annotations
- instruments, bugs, food and carts
- objects with red and yellow hues
- people, nature, wine
layer4-1724
human annotations
- a tractor in the distance, camera, a kid playing a harmonica, a man holding a gun
- people, vehicles, and switches
- angles
layer2-76
human annotations
- horizontal lines
- outlines of green objects
- green areas in picture
layer2-28
human annotations
- dark objects surrounded by background
- the tips of black points
- edges of objects
layer4-443
human annotations
- tilted rectangular surfaces
- food
- the region shows the tops of objects
layer3-880
human annotations
- animal heads
- human hair
- head of baby human or animal
layer4-1109
human annotations
- a girl pushing around a toy lawnmower, a a face mask, clothing items, furniture, nature
- ropes, poles and furniture
- person, helmet, chair, nature
layer4-1561
human annotations
- things that stick up from the bottle and locks
- curved objects and bottle caps
- bottle
layer2-384
human annotations
- contrasting colors
- a spiral stair's railing, design of a can
- stairs, logo, person
layer2-238
human annotations
- dots on circles or grids
- bits of black marks in them
- brighter areas in objects
layer3-804
human annotations
- water and windows and other reflective surfaces
- grey areas
- bodies of water
layer4-745
human annotations
- animal heads
- brown dog faces
- lots of heads and eyes of various mammals, fish, birds, and reptiles, also lipstick, a sink, and a guitar
layer4-900
human annotations
- animals, vehicles and buildings
- objects with red and brown hues
- orange objects
layer4-1718
human annotations
- canon, race car, right and left side of a person
- items with straight features
- edges of objects
layer2-198
human annotations
- the color blue
- the color blue
- blue areas in pictures
layer3-381
human annotations
- buttons and keys
- buttons on safes
- buttons and strings
layer3-951
human annotations
- indented areas on objects
- bottles
- truck, musical instrument, swing, bell
layer4-984
human annotations
- animals and water
- animals and statues of animals
- dog, animal
layer4-1759
human annotations
- the right and left side of an animal, two friends hair
- the background
- hair and the ocean
layer2-184
human annotations
- pale spots
- sharks
- lighter areas
layer4-200
human annotations
- things shaped like an arch
- arches
- structures by trees outside and human activity
layer4-1214
human annotations
- water, poles, and animals
- bridges
- vertical patterns
layer4-844
human annotations
- kids in a classroom, graphic on a bottle, women's hair, a battle on the proud, a flag flying high
- animals and blue objects
- blue objects
layer4-1470
human annotations
- tables, cases ,laptops, carts and animals
- brown and black animals
- carriage, animal, keyboard
layer1-189
human annotations
- a salad on a plate, a musical on stage, a rim of a car, points of a spider web
- yellow and white areas
- little bits of light color
layer2-164
human annotations
- the color orange
- glowing orange or yellow in them
- orange areas in picture
layer3-659
human annotations
- bows and buttons
- area where object is indented
- contain things that are fused together
layer3-931
human annotations
- box and noses
- the area around bow shaped accessories
- noses or bow shaped places
layer4-1721
human annotations
- feet of objects or animals, a piggy bank
- objects with legs or stems
- long, thin items
layer4-2015
human annotations
- a bird flying in the sky, a strawberry, two friends posing for a photo
- animals, one person and one strawberry
- two items that are connected
layer1-29
human annotations
- an my player, a flower in the grass
- the outlines of objects
- plane, animal, person, flower
layer1-82
human annotations
- a cat in water
- colorful stripes and animals
- the parts that connect 2 contrasting colors
layer3-564
human annotations
- fruit, ceramics and metal objects
- metal objects
- the curved lines in subject
layer3-774
human annotations
- backgrounds and neck outlines
- necks of animals
- area below and above head
layer4-627
human annotations
- animals and hats
- animals and people
- things outside
layer4-1072
human annotations
- curved black lines
- poles, heels, grass and sticks
- flag, shoes, shovel, tools
layer3-236
human annotations
- animals outside or inside!
- animal legs and tails
- animal
layer2-64
human annotations
- mainly patches of white
- single color objects and edges of electronics
- outlines of electronics, animals and poles
layer4-43
human annotations
- water, screens and windows
- monitors
- television and computer screens
layer3-707
human annotations
- dots and curved items
- bowl, hand, food, animal, fruit
- rounded edges in pictures
layer4-1262
human annotations
- a girl holding a scarf, a star fish, a giant crab, a hanger for clothes, a dog in a bed, a bandaid on a man's face
- objects with lines and texture
- sea animals
layer4-1975
human annotations
- junk box, motorcycle wheel, dishwashing stand on the cabinet
- handles, poles and musical instruments
- person, nature, stove
layer2-420
human annotations
- a white background
- space above an animal in wild, space above a mushroom, space above a monkey in tree, space above fruit, space above a forest
- the backgrounds around animals
layer2-23
human annotations
- food, insects, safety equipment
- outlines of circles, legs and sticks
- bugs
layer4-196
human annotations
- faces of dogs
- animals and poles
- green grass and dogs
layer4-1244
human annotations
- animals, speakers and circular objects
- brown dogs
- rounded edges in pictures
layer4-1379
human annotations
- animals, tables and flowers
- items on other items
- similar color patterns
layer3-83
human annotations
- edges between object and background
- sea animals
- two colors connecting to each other
layer3-751
human annotations
- human hands engaged in activity
- human arms
- hair spray, instrument, animal
layer4-1754
human annotations
- snake in the grass, tail end of car, bowl, vegetables
- animals and a car
- items with designs
layer2-13
human annotations
- monkey, meerkat, posing for photo, space animals in a photo, space above plant life
- the color white
- negative space above an abject
layer3-288
human annotations
- light and fire
- lighthouse in the distance, candle on a table
- fire in pictures
layer4-423
human annotations
- people, produce and electronics
- include appendages
- people doing things
layer4-209
human annotations
- animals, ropes and balls
- brown dogs
- similar patterns
layer4-1433
human annotations
- animals and circular objects
- dogs holding onto objects
- person, lawn mower, ball, nature
layer4-1304
human annotations
- dogs and birds
- dogs and handles
- dogs
layer1-19
human annotations
- fried rice on a plate
- bits of yellow things
- animal, nature, person
layer3-399
human annotations
- stripes of symmetry on different objects
- red and other colorful stripes
- similar patterns
layer3-120
human annotations
- windows, eyes and homes
- spots containing grey features
- eyes of animals
layer3-910
human annotations
- striped objects or animals
- dogs
- lines through them
layer4-1237
human annotations
- animals, pens and lights
- objects with red in them
- round red object
layer4-1615
human annotations
- boats on the water, flute, flute
- items with patterns
- long things
layer2-15
human annotations
- sunlight highlighted area
- objects with ridges
- similar patterns
layer3-456
human annotations
- rooftops
- lines and edges
- corners of things
layer3-909
human annotations
- white, square features
- ipods
- safe, screen, electronic, wall, insects, painting
layer4-661
human annotations
- animals, food, and wooden objects
- dogs
- things with hair
layer4-741
human annotations
- birds and animals with fur
- animals, food, and handles
- black and white birds
layer4-1677
human annotations
- a man holding bowl, a kid kicking a ball, a tennis ball a kid is holding, a speaker
- circular objects
- items that are rounded
layer3-93
human annotations
- spots of red boundaries
- small pieces of fabric that are on people
- edges of objects
layer4-407
human annotations
- }these are balloons, locks, animals and pottery
- objects with line patterns
- hot air balloons
layer4-546
human annotations
- animals and counters
- dogs
- tops of objects
layer4-1050
human annotations
- black birds and dogs
- animals, vehicles, and tables
- animals and objects with lines or texture
layer4-1519
human annotations
- text around a memorial, dog's color, dog, mouse
- animals and towers and railings
- items with straight features
layer3-0
human annotations
- vertical lines
- a thin line in them
- vertical lines
layer3-981
human annotations
- spots of beige color
- tan food items
- edges of objects
layer3-758
human annotations
- faces of animals
- animals and brushes
- faces of dogs
layer4-320
human annotations
- bugs and ships
- textured areas
- bugs
layer4-1951
human annotations
- animals, accordion, pens
- animals, fruit, instruments and pens
- people, nature, food
layer4-1536
human annotations
- areas with brown or yellow hues
- items that are on other objects
- green areas in picture
layer1-173
human annotations
- space on the boarder and text of a sign, chefur of a skunk, lines of a bottle, a dog holding a bone
- white spots
- animals
layer1-86
human annotations
- a wolf pup, a snake on the ground
- white areas in nature
- parts of white areas
layer3-656
human annotations
- small, round, dots
- green and blue dots
- small blue dots
layer4-141
human annotations
- food, animals and pens
- animals and objects that contain the color red
- animal, insect, music instrument, food, water
layer4-739
human annotations
- basket, food
- animals, tires and stone
- textured surfaces
layer4-1300
human annotations
- animals and furniture
- two items that are connected
- people, nature, animal
layer3-197
human annotations
- a jar of food, a pitcher
- glass bottles and pitchers
- the middle of objects
layer2-300
human annotations
- points on a clock
- person, clock, screws, bug, numbers
- the canisters are striped with different colors
layer3-778
human annotations
- vehicles
- bottom of windows
- the bottom edge of objects including window ledges, computer monitors, a child's coat and a seat belt buckle
layer3-88
human annotations
- lights and animals
- bodies of dogs
- brighter areas in objects
layer4-1215
human annotations
- poles and roads
- railings
- similar color patterns
layer4-1058
human annotations
- bear, bear, dog
- animals and doorways
- animals
layer2-192
human annotations
- spots of the color white and repeating lines
- small birds
- tips of things
layer3-979
human annotations
- lampshades and other rounded objects
- objects that hold things
- brighter areas and shoulders of objects
layer4-483
human annotations
- bridges and poles
- lines and wires
- blue skies
layer4-586
human annotations
- curved lines and objects with jagged lines
- shovel on the gravel, text on a bed, ship ,pan
- handles and protruding objects
layer4-2008
human annotations
- a man holding a piece of pizza, a group of kids posing for a photo, a women in a dress
- clothes and bugs
- pink outfits
layer4-1523
human annotations
- vehicles, dishes and blinds
- sides of items
- things outside
layer2-428
human annotations
- spots of the color white and borders of lines and objects
- a crockpot
- edges of the object
layer3-345
human annotations
- pedals of a flower
- flowers
- flowers, fabrics and strawberries
layer3-788
human annotations
- circular objects and sticks
- rounded tops
- various objects that contain liquids
layer3-837
human annotations
- metal objects, bottle tops and poles
- objects with lines
- wooden stands
layer4-1308
human annotations
- animals with beaks, metal objects, animals that live in the water, animals that are furry
- animals, instruments and cases
- people holding objects
layer4-2003
human annotations
- animals, oceans and food
- small animals and fruits
- items connected to other items
layer2-312
human annotations
- mammals in their habitat
- animal
- the sky is blue and white in color
layer2-1
human annotations
- spots of orange color
- horizontal outlines of colorful objects
- dots
layer3-689
human annotations
- piles or rocks or piles of things that look like rocks, dog feet and wheels of vehicles
- rocks, pills, ties and dogs
- colorful balls
layer3-928
human annotations
- shiny and plaid objects
- checkered pattern
- fabric that is plaid in color
layer4-1745
human annotations
- crowd of people, man's shirt, clothing on the floor, man kneeling next to a bunch of toilet paper
- white objects
- person
layer4-1976
human annotations
- people and sunglasses
- sunglasses
- person, sunglasses
layer3-194
human annotations
- a hand strums a guitar
- feet and spatulas
- patterns
layer3-228
human annotations
- a statue sits atop a base, a animal stands on the ground a sea otter swims to shore, a person poses for a photo
- animals, bottles and statues
- nature, people, structure, animal
layer3-126
human annotations
- the color beige
- tan animals
- yellow areas in pictures
layer4-67
human annotations
- animals and circular objects
- round objects
- logo, animal, spider
layer4-975
human annotations
- dog, women's shirt, pole in the sky, left side of a man
- musical instruments, animals and the sky
- animal, nature
layer4-2040
human annotations
- a bull, a snake, a dog
- animals
- regions with items connected to each other
layer4-1921
human annotations
- faces of people
- items with curved features
- rounded edges in pictures
layer2-311
human annotations
- the end of a dogs nose, a panda's ear
- animal
- the animals are outside laying on the grass
layer1-63
human annotations
- a dog sitting on a sofa
- colours in the picture
- person, electronics, clock, needle, car
layer4-253
human annotations
- animals, food and water
- food
- animal, food
layer4-133
human annotations
- faces
- face area of humans
- touch a body part of a living thing
layer4-2033
human annotations
- crosses and diagonal lines
- a squirrel, a light post, a sign on the side of a barn
- items with straight features
layer4-929
human annotations
- objects that have hair
- hair, frit and bridges
- fur, hair and other textures
layer1-110
human annotations
- stripes on a zebra
- aquatic life
- what areas in between black lines
layer3-36
human annotations
- objects with lines and repeating gaps
- clothing, kitchen
- similar patterns
layer4-371
human annotations
- fences and sails
- white fencing
- planes and fences
layer4-412
human annotations
- people and tower items
- faces and lampshades
- similiar color
layer4-1346
human annotations
- a women applying makeup, wolf, sheep, a man playing an instrument
- dogs, vehicles and circular objects
- objects with texture or patterns
layer4-1457
human annotations
- babies and people's hands
- furniture, rates, kids and computers
- person, food, vehicle, nature
layer2-325
human annotations
- wings of a hawk
- a curved dark circle in them like an eye
- small dots
layer2-418
human annotations
- spots of the color white
- window, nature
- similar patterns
layer3-469
human annotations
- the backs of brown animals
- fur areas
- butts of animals
layer3-565
human annotations
- animals and produce
- smooth, rounded objects
- rounded edges in pictures
layer4-619
human annotations
- animals and rounded objects
- small balls
- things that can be held
layer4-896
human annotations
- animals and circular objects
- objects with brown hues
- faces of dogs
layer4-1843
human annotations
- dog's face, boots, flag
- items that are connected
- similar color patterns
layer2-33
human annotations
- a dog and his ball, windows on a front of a building, laundry basket, the top ridges of a gun
- stripes, checkers and scales
- black striped items
layer3-350
human annotations
- cylindrical objects
- older phones
- regions with creases
layer4-438
human annotations
- nature in the background
- textured areas
- grassy areas and blue skies
layer3-673
human annotations
- animals, curved objects and a suit
- land animals
- spotted patterns on them
layer4-1132
human annotations
- an alligator, a dog walking in the snow, a piece of bread, a camping bag, a puzzle of a cat
- animals and bottles
- edges of objects
layer4-1544
human annotations
- animals, curved objects and tables
- rounded areas with a variegated pattern to them
- person, food, statue, nature
layer2-3
human annotations
- dots on points
- beaks of birds
- white dots of color
layer3-405
human annotations
- water as a background
- shows backgrounds behind a being
- backgrounds in pictures
layer3-698
human annotations
- poles, arrows and similarly shaped items
- decals on clothing
- include yellow
layer3-916
human annotations
- the sky or walls
- sky
- monkeys and dogs
layer4-727
human annotations
- people holding objects and metal items
- reflected surfaces and clothes
- black objects
layer4-1471
human annotations
- food, hat
- red and orange objects
- orange or tan
layer1-198
human annotations
- birds and animals roaming the grass or rocks
- birds
- nothing
layer3-992
human annotations
- cages and fences
- cages
- similar patterns
layer3-824
human annotations
- orange objects
- red and orange objects
- side area of an animal or object
layer4-584
human annotations
- animals and blimps
- brown dogs
- ears on dogs and other animals
layer4-965
human annotations
- square objects being held by humans
- cases, carts, laptops ad black items
- rectangular objects
layer4-1630
human annotations
- text around four corners of a design, sock, cloth, star fish
- backgrounds
- wooden flooring and doors
layer1-178
human annotations
- spots of the color white
- dogs or other animals posing for a photo, piece of an ice cream, birds, trees
- cat, dog, flower, popsicle
layer1-211
human annotations
- dogs on a bed
- aquatic animals and dogs
- animals
layer4-166
human annotations
- plants and trees
- faces of brown dogs
- areas around a central item or thing
layer4-680
human annotations
- wildlife and objects on grass
- stairs, water, and green grass and animals
- green grass
layer4-897
human annotations
- objects to fit on your hand and clothes
- dirt areas
- items with corners
layer4-1828
human annotations
- masks a person is wearing a tractor, a ape, sunglasses a a person is wearing
- animals
- openings
layer1-193
human annotations
- puppy
- yellow and red
- the space above animal
layer4-18
human annotations
- dead fish and people grabbing things
- arms of humans
- instruments
layer4-109
human annotations
- vehicles, floors and water
- vehicles
- people in extreme sporting events or motorized items
layer4-571
human annotations
- furry animals
- animals and grass
- red or brown objects
layer4-1023
human annotations
- white lines and edges
- white lines and water
- areas with lines
layer4-1821
human annotations
- a searchlight, light in a room, food on a plate
- lights
- light sources
layer1-199
human annotations
- watermarks
- spirals and sharks
- corner of pictures
layer4-173
human annotations
- animals and textured objects
- book, animal, nature
- necks of things
layer3-629
human annotations
- the outlines of animals and vehicles and towers
- pale areas around an object
- dog ears
layer4-664
human annotations
- animals, tools and vehicles
- metal objects
- items with long, thin straight lines
layer4-726
human annotations
- object with red hues
- human hands
- hat, animal, food
layer3-11
human annotations
- the right side of curved objects
- spots that contain color changes
- light sources
layer2-245
human annotations
- things that are red
- red white and blue borders
- similar patterns
layer3-904
human annotations
- animal mouths
- dogs and dog-like animals
- contain the sides of faces
layer4-759
human annotations
- animals and chains
- dogs, an insect and birds
- eagle birds and dogs
layer4-1609
human annotations
- animals, vehicles and pens
- images containing red or brown hues
- numerous vehicles
layer4-1743
human annotations
- animals, castles, rules, vehicles and random things
- have two items connected
- brighter areas on objects
layer3-178
human annotations
- edges of blue and green
- animal walking or laying
- knees and boats
layer1-190
human annotations
- mammals in the water
- sharks
- written text
layer3-78
human annotations
- red parts of objects
- red things
- red areas in picture
layer4-152
human annotations
- textured areas
- metal objects
- a stick or ramekin like object
layer4-478
human annotations
- furniture and sweaters
- backgrounds
- people and dogs and their hair and fur
layer4-1081
human annotations
- bird, insect
- animals
- two items that are connected
layer4-1728
human annotations
- pole woman are dancing around, a stick a dog has, a wallet, lock
- poles, pencils, and gas cans
- items that have straight features
layer3-257
human annotations
- a snowmobile going in the snow
- dogs
- the ground
layer2-83
human annotations
- sharks in the water, a bird walking on a porch, fish in the ater
- sharks
- zig-zag shapes in them
layer3-592
human annotations
- birds, mountains and bridges
- triangular features
- pictures of animal
layer4-230
human annotations
- animals and wildlife
- animals and vehicles
- birds and dogs
layer4-688
human annotations
- animals, boas, and grass
- fur or fabric
- fluffy animals
layer4-1075
human annotations
- objects with fur and tires
- wheels, plaques and animals
- gears and wheels and objects that resemble them
layer2-186
human annotations
- contrasting stripes
- person, animal, fan, mask
- stripe patterns
layer2-169
human annotations
- striped objects
- ridged pieces of different structures
- specific patterns
layer4-746
human annotations
- people, bottles and furniture
- people, animals and man made objects
- necks and dogs
layer4-306
human annotations
- fruits and faces of animals
- things with dots and animal heads
- faces of animals
layer4-1448
human annotations
- barber pole outside of a hair salon, a sign to a memorial, a tent in the snow, a graduation student
- people and things with red stripes
- colorful stripes or patterns
layer3-511
human annotations
- computer screens
- small spots made up of small pattern
- rope, keyboard, lighthouse, structure
layer3-430
human annotations
- water with ripples in it
- images with water
- the water around animals
layer4-663
human annotations
- objects that are green, blue, brown, yellow, red, white and black
- animals, boxes and balls
- green objects
layer3-721
human annotations
- clock, tool, shirt
- handles, walls and the sky
- lighter colored border areas
layer4-1670
human annotations
- birdhouse, flower, dog wearing a hat, store with the sign on the front, barn in the background
- wooden buildings, hats and fences
- roofs
layer4-2025
human annotations
- chair, dog, man's shirt
- brown dogs
- items on other items
layer3-417
human annotations
- black and white text
- logos on objects
- words in pictures
layer4-14
human annotations
- fur and feathers of animals
- areas of connection with other objects
- animals and fur like qualities
layer4-530
human annotations
- snow a person is shoveling, a bus going down the road, a frog
- animals, trains, and auditoriums
- items with straight lines
layer4-644
human annotations
- animals and pens
- animals, people and dark objects
- things outside
layer4-1452
human annotations
- people holding objects
- items of central focus
- animals, people, nature, food
layer4-1501
human annotations
- objects with red hues
- items that are curved
- brighter areas on objects
conv1-10
human annotations
- flower pedals
- the flowers, people, and birds are colorful and are all in action
- birds flying a sky
layer4-37
human annotations
- storage boxes, furniture and animals
- land animals
- black and white
layer4-30
human annotations
- hands of people
- rectangular objects in them
- long, rectangular features
layer4-1253
human annotations
- shelves and the hands of people
- animals, buttons, and shelves
- dog faces and green grass
layer4-1178
human annotations
- a stage in a room, a side of a truck, curtains in ar oom, side of a building
- homes and animals
- angles
layer4-1681
human annotations
- man's face, a baby, a dog,a soccer ball
- items with angles
- front of objects
layer2-105
human annotations
- yellow objects
- yellow and red objects
- orange areas in picture
layer2-44
human annotations
- along the ridges of animals, people, and objects
- the ears of land animals
- brighter areas in objects
layer3-706
human annotations
- a cup, a chainlink fence, a fish, a pan
- dots and holes
- small black and brown sticks
layer4-578
human annotations
- animals and grates
- object with stripes or other patterns
- balls and radiators
layer4-1330
human annotations
- a mouse playing with cheese, a person reading, graphic on a box, a dog in a enclosure, na package
- animals and beauty products
- black dogs
layer4-1569
human annotations
- animals, vehicles and objects with circles
- objects with round features
- green trees
layer1-62
human annotations
- black lettering and perfume bottles
- a dark shape
- animal, logo
layer1-97
human annotations
- a snake, a fox yawning, a deer in the light, a beer in the dar i
- objects of whiskers and legs
- animals
layer3-599
human annotations
- reflected things
- noses of people and dogs
- window, mirror, sky, person, cell phone
layer3-595
human annotations
- legs and poles
- bodies of different bugs
- thick, rounded regions
layer4-634
human annotations
- windows
- glass ceilings and walls
- vertical line patterns
layer4-1566
human annotations
- curved lines and edges
- snakes and sticks and similarly shaped items
- person, lamp, remote, nature
layer2-387
human annotations
- a suv with rims
- parts of white thin areas
- white spots of different areas
layer2-485
human annotations
- tips of ears
- the ears of land animals
- edges of the object
layer3-145
human annotations
- shiny objects
- chests of different people
- i-shaped areas
layer4-294
human annotations
- animals, vehicles and stages
- dogs and yellow objects
- dogs and horses and people and trucks and animals
layer4-1302
human annotations
- a soccer ball someone is holding, people at a supermarket, person's hands, person in the water
- animals, people and water and sky
- cloudy skies
layer4-1418
human annotations
- animals and feet
- appendages
- insect, person, foot
layer3-253
human annotations
- the front face of a fox or another animal, kitchen untinsels, bug on a leaf
- dogs eyes and noses
- dog noses and things that look like them
layer3-454
human annotations
- triangular objects
- triangular features on objects and structures
- triangular objects
layer3-551
human annotations
- vehicles, bugs and lawnmowers
- vehicles
- abdomen area of bug
layer4-337
human annotations
- plaques, clocks and electronics
- screens and surfaces with text
- rounded edges in pictures
layer4-1265
human annotations
- animals and curved edges
- animals, masks, vehicles and appliances
- things outside
layer4-1809
human annotations
- plants, cookware and lights
- green or brown objects
- green areas in picture
conv1-61
human annotations
- a radio with its trim
- white outlines of objects
- bug, radio, person, bench
layer2-306
human annotations
- dots on a butterfly, a space on a sign
- colour of the comics
- circles and round shapes
layer3-587
human annotations
- walls and doors
- cabinets and doors
- doors
layer3-520
human annotations
- blue objects
- blue materials, objects, and fur on birds
- blue birds and denim
layer4-800
human annotations
- animals and circular objects
- curved object
- objects close to the mouth
layer4-1180
human annotations
- animals
- shaggy dogs
- pictures of animal
layer4-1923
human annotations
- animals, cup
- areas with pointed objects
- curved items
layer3-57
human annotations
- people wearing hats
- person wearing a hat
- hats on peoples head
layer2-444
human annotations
- a helicopter, a taxi going down the road
- outlines of eyes, dots and other pointed areas
- sharks and eyes
layer4-428
human annotations
- floor and grass
- sand and gravel
- animal, golf ball, parking lot, van
layer3-851
human annotations
- animal eyes and noses, and objects that resemble them
- eyes of birds
- round nose of a animal
layer4-1511
human annotations
- animals and floors
- curved items
- lighter areas in pictures
layer4-1024
human annotations
- yellow objects and glasses
- the are shaped like sunglasses
- person, food, vehicle, nature
layer3-357
human annotations
- the sky or solid color background
- blue skies and white walls
- flat color areas around sitting objects
layer4-10
human annotations
- insects and snails
- black bugs
- bugs and animals
layer4-331
human annotations
- animals and balls
- shoulders of humans
- animal, nature, person
layer4-640
human annotations
- people
- baby faces
- human faces
layer4-1360
human annotations
- wooden tables and shelves
- areas with multiple lines
- wooden furniture
layer4-2046
human annotations
- left side of a man's shirt, an axe, a mushroom, a nail, a man parachuting
- tools, animals and parachutes
- long, thin objects with a thicker point
layer3-219
human annotations
- a dog's ears
- dog heads
- dog faces and ears
layer3-250
human annotations
- space above a dog
- blue skies and dogs
- part of the top part of the sky
layer3-527
human annotations
- bottom of lamps, cups and legs
- the things that look like wine glass stems
- the base of the glass is wide, then narrow as you move up
layer4-132
human annotations
- fur of animals and edges of objects
- clothes and benches
- person, nature, animal
layer4-1013
human annotations
- insects and animals
- animals, food, and a apron
- brown bugs
layer4-1032
human annotations
- animals and screens
- brown dogs
- items with corners
layer2-455
human annotations
- chainlink fence, symmetry of a design of nature or manmade object, a bird sitting on a rock, a dog looking through a gate, a group of people riding a dirt bike
- letters, grids and scales
- a criss cross or honeycomb like design
layer3-28
human annotations
- spots of the color white
- boarders
- brighter areas in objects
layer4-388
human annotations
- objects and animals with curved lines
- plants, animals and a plaque
- snakes
layer4-903
human annotations
- animals and circular objects
- faces and necks
- two items that are connected
layer4-1084
human annotations
- dog, a bunny
- animals
- breeds of dogs, one bear and one rabbit
layer3-72
human annotations
- outreaching lines in a fan shape
- heads of bugs
- the photographs represent the lines found in objects both alive and innate
layer3-1020
human annotations
- white and brown edges
- rock, wall
- rounded edges in pictures
layer3-956
human annotations
- the sky and trees
- sky and grass
- nature
layer4-1194
human annotations
- animals, dresses, and columns
- brown objects
- rounded objects in pictures
layer4-1683
human annotations
- red and blue objects
- areas with red hues
- curved items
layer4-1768
human annotations
- a woman holding a camera, an owl, a bison, a man with a green shirt, a cat, a man holding a guitar pick
- faces and objects that resemble them
- two items that are connected
layer2-392
human annotations
- space above a boys hair
- backgrounds that are fuzzy
- nature
layer3-29
human annotations
- edges of objects and tables
- the color white on instruments, and backgrounds of animals
- rounded edges
layer4-177
human annotations
- pills and remotes
- small pellets
- pills, game board, person, hand, food
layer4-1011
human annotations
- animals and circular objects
- perforated white objects
- items with circular features
layer4-1299
human annotations
- a bird flying in the sky, a person with keyboard and mouse, a gas pump, an old rusted wheel barrel
- animals and cords
- tails of animals
conv1-47
human annotations
- a crockpot, spaces on the edges of a butterfly
- white dots on butterflies
- the space along the edges of the object
layer3-429
human annotations
- dog legs
- legs of animals
- the animals' legs are furry
layer3-573
human annotations
- birds with wings extended
- animals, brushes and mushrooms
- wings, brushes or things shaped like that
layer3-722
human annotations
- animals, circular objects and cassettes
- textured areas
- birds and bugs
layer4-1492
human annotations
- dogs, crutch on the sand, remote
- animals, remotes, crutches and pens
- items with straight features
layer4-1482
human annotations
- pets, toilet paper, a vaccum, a lizard
- animals and things with holes
- objects with eyes or holes
layer2-500
human annotations
- dots on the background
- dogs
- corners of things
layer3-506
human annotations
- backs of dogs
- curved parts of objects
- animal, mop, vegetable
layer3-697
human annotations
- grass and water
- green pastures
- area of road
layer4-498
human annotations
- shiny appliances and fabric
- containers and clothing
- people and trash cans and appliances
layer4-934
human annotations
- people who are sitting or near pools
- person, turtles in a body of water, fire truck on water, pool table
- people, pools, water and chains
layer4-1907
human annotations
- insects and orange objects
- insects, food, a dress, a deer drinking water
- items that are connected
layer1-235
human annotations
- the color blue
- sharks in the ocean, air, a woman's blue shirt, a mouse on a desk
- sharks and the ocean
layer3-464
human annotations
- bottles and chains
- logos from objects
- labels that are on toys and food items
layer3-820
human annotations
- eyes of frogs and other animals
- animal eyes
- frog eyes
layer4-504
human annotations
- things that look like wood
- tan, textured objects
- human hands
layer4-1605
human annotations
- kids in a field, a radio with a tape deck, a dog in a field
- animals, appliances and electronics
- animal, person, fan
layer4-1472
human annotations
- boats, people and cookware
- two items connected
- brighter areas on objects
conv1-3
human annotations
- a guitar player
- red colored objects
- the wine glasses and windmills are bright in color
layer2-469
human annotations
- between two shoes, hot air ballons in the air, flowers in a pasture, the lense of a camera a side of a bus
- striped or dotted objects
- stripes
layer3-128
human annotations
- tails of different dogs
- fur
- the dogs' tails are short or curly
layer4-372
human annotations
- papers, animals and cookware
- piles of clutter
- rounded edges in pictures
layer4-577
human annotations
- legs of people
- clothing
- red and black clothing
layer4-1046
human annotations
- a salade, a binder, a radio. a butterfly
- fences, instruments, furniture, safety pins and butterflies
- person, fence, butterfly
layer4-1707
human annotations
- tiger, a man playing guitar
- hands
- things that are connected
layer3-304
human annotations
- a handle of a cup of coffee, a rose pedal
- circular cylinders
- the space above a stick
layer1-119
human annotations
- repeating black and white lines
- zebras
- thin black stripes on them
layer4-349
human annotations
- animals, towers and furniture
- areas containing lines
- black seating
layer3-667
human annotations
- stripes and dots
- patterns and stripes
- polka dots on them
layer4-1325
human annotations
- yellow and brown objects
- objects with red or brown hues
- yellow and amber objects
layer4-1838
human annotations
- succors, tower, piece of fruit, tower
- railings and muzzles
- items with straight features
layer1-151
human annotations
- diagonal and curved lines
- long thin items
- white and blue dots
layer3-544
human annotations
- shower caps and objects that resemble them
- shower caps
- shower caps
layer4-831
human annotations
- animals, plunger, go cart and circular objects
- red and brown hued objects
- yellow and orange objects
layer4-1938
human annotations
- kids enjoying the outdoors, a woman on a camel, insects, a snake in water, a person parachuting
- two items that are connected
- things outside
layer1-71
human annotations
- black clothing
- the area around a line
- activities
layer1-121
human annotations
- a person holding up a lighter, spaces on the strings of a harp
- small lighting
- background objects
layer4-823
human annotations
- animals and the ground of sky in the background
- black dogs
- person, animal, tower, subway
layer3-861
human annotations
- animal legs and skinny lines
- black bugs
- legs of insects
layer4-1531
human annotations
- green insects
- insects, flowers, sign
- angles
layer4-1726
human annotations
- cylinders, foods, and animals
- on or near
- rounded edges in pictures
layer3-325
human annotations
- arrow on a speedometer
- circular objects and handles
- parts of rounded things
layer2-57
human annotations
- the color green
- fluorescent green objects
- green areas in picture
layer4-263
human annotations
- poles and vehicles
- diagonal lines
- vehicles
layer4-978
human annotations
- animals with fur and straight lines
- objects with lines, grids and texture
- white objects
layer4-1947
human annotations
- a coin in-between petals, a man with a shower cap, a bird on a branch, a bird in the water
- animals, pots, and brown objects
- shower caps
layer2-295
human annotations
- bird on a branch, a person with their foot on a number, leggings in a photo, a group study at a library
- animals and lettering
- bits of skin or other objects
layer3-290
human annotations
- areas in the middle of a spiral
- circular objects and spirals
- gap within object
layer2-267
human annotations
- dots outlining a object
- trees and black animals
- backgrounds in pictures
layer3-858
human annotations
- boats and tusks
- boats
- boats
layer4-488
human annotations
- dogs and circular objects
- heads of brown dogs
- rounded edges in pictures
layer4-1852
human annotations
- two people talking at a table, a dog walking in the snow, a sewing machine, a sunset by a water tower
- area underneath torso or structure
- regions under other objects
layer4-1835
human annotations
- an airplane, a rock in an ocean
- sides
- backgrounds in pictures
layer3-264
human annotations
- the barrel of a long gun windows in an office
- colored circles
- things that get worn down
layer1-230
human annotations
- spaces on the rim of a wheel
- sunglass on objects
- dots of various colors and sizes
layer4-150
human annotations
- areas under animals
- human holding or interacting with animal or object
- multi texture land areas with animals outside of area
layer3-855
human annotations
- birds and curved objects
- objects with red accents
- curved part of object
layer4-906
human annotations
- bottles, blocks and shiny objects
- complex images containing intricate patterns
- rounded clocks
layer4-889
human annotations
- objects left around, incest, a dog about, a bird in trees, a fox playing around, a bird in a tree, a frog , a couple dogs
- circular objects, animals and sign decoration
- red objects that are round and concave
layer1-201
human annotations
- a table outside, a dog on the ground, a girl with a snake around her neck
- fluorescent blue objects
- blue objects
layer3-409
human annotations
- a person playing sports, a person with their gun in tow, a person holding two birds, a person lifting weighs, or playing a game
- yellow balls that are small
- arms of people
layer3-876
human annotations
- brown dogs
- the side edge of objects
- tiny spots and lines and edges
layer4-677
human annotations
- vehicles, furniture and black objects
- tractors
- trucks or are black
layer4-895
human annotations
- animals, clothes and beaches
- areas containing red hues
- bird beak like items
layer3-268
human annotations
- a sign with text, a road with white lines for barriers
- road
- the road outside a tree
layer3-24
human annotations
- white lines
- yellow produce
- words and the color yellow
layer3-795
human annotations
- green objects
- green objects
- green in them
layer4-1175
human annotations
- faces of animals
- animals
- dogs
layer4-1002
human annotations
- areas with stone cliffs
- rocks on a beach, water, rock that a brid is standing on
- cliffs
layer4-1590
human annotations
- dog, bird, rocket engine, speaker
- poles, watches and birds
- animal, nature, pen, speaker
layer1-171
human annotations
- a dog behind a chainlink fence
- dots outlining a object
- white small dots
layer3-362
human annotations
- these re circular objects and stripes
- spots that contain grey hues
- patterns
layer3-789
human annotations
- circular objects and the area under them
- arches
- areas inside of curves
layer4-437
human annotations
- top of a light pole, a lady holding flowers on a web page, outdoors and nature, insects, flowers, needle and yarn
- bugs and flowers
- flowers and bugs
layer4-691
human annotations
- trees and the sky
- vegetation and sky
- trees in the winter
layer4-1589
human annotations
- people in glasses
- sunglasses
- sunglasses
layer3-267
human annotations
- car windows
- car windows and dog eyes
- windows on cars
layer1-238
human annotations
- three people graduating, a shirt someone is wearing, a scarf someone is wearing, a table cloth on a table, shoes on a table, a accordion
- objects with stripes and grates
- striped clothing
layer4-163
human annotations
- animals and machines
- items that are standing upright
- some animals, different paved surfaces, and some grass
layer3-920
human annotations
- blue and red dots
- red objects
- red areas on objects
layer4-892
human annotations
- a makeup pad a girl is using, bathroom fixtures, food
- porcelain and white lines
- similar color patterns
layer4-738
human annotations
- puzzles, sand, rocks and similar items
- textured surfaces
- puzzles
layer4-1608
human annotations
- grass, left and right side of a woman, ship
- sticks, poles and railings
- shrub, bucket, person
layer2-191
human annotations
- many colorful objects
- dog, flower, toaster, screw, fire truck
- edges of objects
layer2-70
human annotations
- repeating circular patterns
- lattice and checkered patterns
- similar patterns
layer4-1209
human annotations
- bowls, food and area behind people
- brown objects
- similar patterns
layer4-605
human annotations
- animals, tools, cups and handles
- amber objects
- rounded edges in pictures
layer4-1688
human annotations
- animals and poles
- people and birds and animals
- blue in them
layer3-299
human annotations
- arches and locks
- arches on objects like locks or bottles
- curved handles of locks
layer2-119
human annotations
- spots of blue and other colors
- pale spots
- brighter areas within objects
layer4-201
human annotations
- sticks, ropes and similarly shaped objects
- skinny twigs and lines
- stick like items or lines
layer4-396
human annotations
- a dog on the ground, a body of water, right side of a person
- bottles, people and fencing
- hands of humans
layer4-1354
human annotations
- animals
- dogs and other animals
- people, nature, animal
layer4-1337
human annotations
- left side of a person, an elephant trunk, beetles on the ground
- nature
- show edges
layer2-364
human annotations
- the color white in small, circular spheres
- pale spots where an object or pattern end
- partial borders around a circle
layer1-31
human annotations
- scarf of a dog
- red fabric with blue lines
- colorful patterns
layer4-85
human annotations
- objects with handles and dog heads
- the top of round on the bottom things like bottles
- bottles, hats, animals
layer3-528
human annotations
- hinges
- corners
- the corners of the objects whether it is a laptop or piano all have a folding piece that curve
layer4-535
human annotations
- instruments, nails, food and circular objects
- musical instruments
- similar color patterns
layer4-509
human annotations
- animals, lipstick, and towers
- red beaks of birds
- tops of items
layer3-559
human annotations
- blue and pink fabric
- knit pink materials
- a ruby texture or pattern
layer3-830
human annotations
- things with rims and edges
- domes of buildings
- connection
layer4-1207
human annotations
- balls
- birds, fruit, toys, and other objects
- rounded items
layer4-1429
human annotations
- bottom of a picture with an owl, fish, a women diving in the water, dog's ear
- sticks, food, and walls
- animal, person
layer2-376
human annotations
- a gas gauge
- the triangular shapes or diagonal lines
- colors of lettering
layer1-233
human annotations
- a cheetah, a bird, a water fountain, a glass of wine with text underneath, a whale in the ocean
- words and blue areas
- white lettering and birds
layer2-456
human annotations
- patches of empty white space
- poles of a umbrella in sand at a beach
- windows and the ocean
layer3-41
human annotations
- tires of cars
- tires on trucks
- rounded areas
layer4-255
human annotations
- shiny objects like cans and bottles
- piggy banks
- pictures of animal
layer3-923
human annotations
- walls
- human arms
- the regions are underneath objects
layer4-1393
human annotations
- kids face
- kids and dogs
- living things
layer4-1521
human annotations
- shelf, table with items, kid and his bubbles, vaccum
- animals, boards and fabric
- two connected items
layer2-374
human annotations
- a soccer ball
- thin rods
- tips of items
layer2-121
human annotations
- grids and fences or roofs
- light spots surrounded by dark lines
- horizontal lines in picture
layer2-244
human annotations
- the color gold and brown
- a gradient of color
- vertical objects and lines
layer4-401
human annotations
- bright yellow items
- green objects
- green objects
layer4-779
human annotations
- birds, counters and tables
- stools and tables
- the tops of items
layer4-1357
human annotations
- objects with pointed tips
- animals, poles, chains and pens
- mouths and instruments
layer1-27
human annotations
- a dog on some grass, a couple helping animal's in a field
- nature, people, structure
- the sunlight is coming in creating horizontal beams in the rooms and objects
layer3-421
human annotations
- keyboards of different electronic devices
- these ar parts of keyboards or things that look like that
- keyboards, tires, truck
layer3-796
human annotations
- sticks, circles and the sky
- pale areas
- twigs of trees
layer3-922
human annotations
- objects with buttons and clocks
- tan areas
- clocks and buttons
layer4-1005
human annotations
- legs of animals
- legs
- dog legs
layer4-1516
human annotations
- animals with fur
- orange peel, dog's snout, logs, dogs
- items with straight features
layer3-306
human annotations
- women's men's or child's hair
- hair
- faces of people
layer3-488
human annotations
- black areas surrounded by white
- it looks like an eye
- dark spots
layer3-886
human annotations
- necks of animals
- striped objects and dogs
- hands of humans
layer4-580
human annotations
- striped orange and black objects
- textured areas
- outdoor activities
layer4-1560
human annotations
- long, thin objects
- birds, snakes, animals, and other various objects
- items with straight features
layer2-379
human annotations
- a monkey looks through a chainlink fence
- monkeys and trees
- nature
layer3-485
human annotations
- cans and mugs and similiar shaped objects
- skinny poles
- rounded edges in pictures
layer4-102
human annotations
- food, coral, and coils
- backside of animal
- objects that create patterns in them
layer4-1151
human annotations
- birds and green objects
- animals and green objects
- brown dogs
layer4-1007
human annotations
- fences, poles and doorways
- patterns of lines or grids
- fencing materials
layer1-5
human annotations
- a person with power tools, a watch, a dog riding a kid's toy
- black and white stripes
- logo, animal, basket
layer1-222
human annotations
- white lines and borders
- dogs
- brighter areas within objects
layer4-146
human annotations
- animals
- animal faces
- animals
layer4-139
human annotations
- barrels and edges of objects
- barrels, clothes and circular objects
- yellow objects
layer4-1196
human annotations
- lines, tiles, a computer and a person
- pools, tables and white surfaces
- brighter areas on objects
layer4-1397
human annotations
- things with grates, pots and vehicles
- human hands
- bus, plant
layer2-146
human annotations
- a bird on a branch, a flute, a hockey player
- different types of birds
- backgrounds in pictures
layer2-264
human annotations
- outlines of brains, sticks and animals
- areas with lumpy texture
- lighter areas
layer3-700
human annotations
- animals
- heads of dogs
- canine ears
layer4-593
human annotations
- balls
- green areas in picture
- yellow-green objects
layer4-1097
human annotations
- a dress a women is wearing, a man's shorts, a hotdog, a gas pump
- people, poles and food
- human hands
layer4-1935
human annotations
- a kid playing with a toy, a dog going for a walk,a panda
- balls and areas with curves
- items that are connected
conv1-9
human annotations
- a stripped zebra
- very small dots and lines
- logos
layer1-85
human annotations
- fluorescent orange mostly found in nature and some words
- orange areas of butterflies and other animals
- the colors orange and red
layer2-419
human annotations
- strings of a guitar, a fox in the snow, a dog, a rock formation a bottle of alcohol
- different colored stripes
- criss-cross like areas
layer3-625
human annotations
- animal parts and rounded objects
- corners of objects
- animal, food, apple, dog, boat
layer3-627
human annotations
- animals
- noses, legs and antennae
- feet of birds
layer4-930
human annotations
- horse, text on a sign, spider, food on a plate
- animals, food, and plaques
- birds
layer4-871
human annotations
- white animals and microphones
- animals, trees and plaques
- fluffy animals
layer1-64
human annotations
- a whale poking it's head up from the sea
- white outlines of animals
- animal
layer1-203
human annotations
- repeating, small lines
- birds
- animal, person, flag
layer4-158
human annotations
- mammals and a boat
- black and white animals
- dogs
layer3-603
human annotations
- circular objects and flowers
- pink flowers
- circles in a group
layer4-1349
human annotations
- aquatic life, a girl in a swimsuit
- people and dogs
- bikini tops or bottoms
layer4-1571
human annotations
- roads and water in the side of an image
- corner of a person, person's i neck
- water and tables
layer3-30
human annotations
- left and right side of a person or object, space below a bridge towards the water, space of a dogs legs
- human arms
- objects with a pronounced rounding
layer3-672
human annotations
- white edges of clothing
- ties and socks
- neckties
layer4-603
human annotations
- linear projections appear in these photos
- bugs and skinny poles
- area where object becomes long and thin
layer4-925
human annotations
- sea turtle, bird on a roof, monkey, kid, dog
- brown dog
- animals, colorful scraps and people of various ages doing things
layer4-1432
human annotations
- dog's face, wheel on a wagon, hot air ballon
- animals and circular objects
- items with rounded features
layer1-206
human annotations
- fish in a pond, a group of cars, space above the pins of a shark
- dots outlining objects
- edges of objects
layer3-278
human annotations
- nails of aperson holding a ice cream cone, buttons of a toaster
- relish objects
- pink and brown objects
layer2-19
human annotations
- white regions surrounding a photo
- white areas in the background
- monkeys
layer4-96
human annotations
- water and cylindrical objects
- text over a background
- metal screws
layer4-356
human annotations
- animals and vehicles
- green grass
- items with flat areas
layer4-719
human annotations
- a insect, a dog walking on the carpet, a dog on carpet, a bird
- animal fur and scales
- brown items
layer4-1140
human annotations
- ship, jug of whiskey, mop, thing of lotion, chair
- handles and subs
- rounded edges in pictures
layer1-3
human annotations
- the top sof bottles
- words
- the bottles, shark, food and landforms are all different shapes
layer1-54
human annotations
- dots outlining a object
- pale areas next to dark spots
- green clothing and animal parts
layer3-507
human annotations
- objects with lines and parallel edges
- muzzles and patterns
- red and white objects
layer4-189
human annotations
- fencing
- background of images of animals and fence shaped objects
- enclosures
layer4-1251
human annotations
- people and animals in the ground
- floating objects
- blue skies and birds
layer4-1312
human annotations
- bags, corkscrews and things with handles
- objects with thin protrusions
- hanging objects
layer4-1919
human annotations
- fur, fabric and textures
- items with curved features
- faces of animals
layer1-161
human annotations
- black lettering and round borders
- text, writing
- specific patterns
layer3-347
human annotations
- chain-link fencing
- animals and objects and people behind or in front of a chainlink fence
- parts of fences
layer4-76
human annotations
- animals, sticks and pucks
- include lines
- inspect, sports, pinwheel
layer3-649
human annotations
- animal heads and hands
- eyes of different animals
- pictures of animal
layer4-538
human annotations
- animals, food and piggy banks
- piggy banks
- pictures of animal
layer4-1133
human annotations
- items that are curved
- animals, people
- similar color patterns
layer3-256
human annotations
- space above a few animals, space above a food item
- circles of color in the sky
- nature
layer3-443
human annotations
- the color red and patches of fur
- black objects on a white background
- rounded edges in pictures
layer3-805
human annotations
- animals and circular objects
- electronics and dog faces
- animals, camera, screws, socks
layer4-574
human annotations
- towers, people and birds
- tapered objects
- towers
layer4-1243
human annotations
- electronics, instruments, and hair
- household electronics
- corners of rectangular objects
layer4-2006
human annotations
- shirt on a person's chest, athlete, pet
- animals
- living things
layer3-209
human annotations
- space on the other side's of a dogs head
- these images all share vegetative greenery
- nature
layer3-426
human annotations
- faces and legs
- faces
- person, animal
layer2-275
human annotations
- dots in the background
- birds
- random spots
layer4-534
human annotations
- animals, cookware, and a guitar neck
- fabric, fur and lines
- scarfs and skirts
layer4-537
human annotations
- animals and picked flowers
- animals, sand and flowers
- dogs and flowers
layer4-1466
human annotations
- bird the grass,women walking down the street
- animals and cylinders
- black
layer4-1861
human annotations
- bird, a rat, a dog walking on the beach, a person atop a pole
- animals
- where two items meet
layer1-52
human annotations
- space above a whale
- skinny lines
- logo, sky, gauge
layer3-548
human annotations
- snakes and lizards
- bends in someone
- the set of photographs all have shoulders of objects both alive and innate
layer3-977
human annotations
- spots that contain blue and grey
- colorful decorations
- nature, pinwheel
layer4-945
human annotations
- dogs and other animals with fur and scales
- animals, smoke and a state
- dogs
layer3-939
human annotations
- dots and holes
- perforated metal objects
- piggy bank, wheel, electronic, person, phone, spatula
layer4-1942
human annotations
- mostly animals, primarily mammals, but also a lizard and a toucan
- living things
- things outside
layer4-1756
human annotations
- dog, candy, toy, eggs, neck
- a central object
- animal, nature, doll
layer3-316
human annotations
- deer in a field
- beaks of birds
- heads of animals
layer3-51
human annotations
- circular objects and round edges
- hands
- clock, hands, person
layer4-117
human annotations
- necks and pottery
- long, vertical objects
- ostriches
layer4-607
human annotations
- animals, grass and honeycombs
- animal body parts
- backgrounds in pictures
layer4-1983
human annotations
- musical on stage, man holding an axe, graphic design on a package, scorpion, bird, flag on a parachute
- mics, tools, and flags
- animal, nature, person, axe
layer2-298
human annotations
- a pool
- parts of striped areas
- columns of slats running in a vertical pattern
layer3-575
human annotations
- circles
- wheels of vehicles
- keyboard, person, logo, rim, icon, numbers
layer3-525
human annotations
- curved lines and beige color
- stripes
- beaks and objects that are similarly pointed like beaks
layer4-827
human annotations
- dogs having fun, a ear of corn on the ground, a star fish washed up, a dogg looking through a door, a dogs feet, a dog on a mave of pavement, hangers
- animals and grass
- brown dogs
layer4-795
human annotations
- animals and things with poles
- objects with lines, fur or hair
- edges of objects
layer1-104
human annotations
- spots of blue on edges of objects
- dogs play outside, kids toys on a table, a my player on a table, underwater photo, disney character meet a dog
- green grass
layer2-157
human annotations
- a white background
- solid color areas over an object
- over objects and animals
layer3-831
human annotations
- poles and bugs
- flies
- two items that were joined by a mutual item
layer4-395
human annotations
- animals
- bugs
- insects, animals, remote
layer4-1061
human annotations
- hands of people holding objects
- electronics, lights and furniture
- object with corners
layer4-1090
human annotations
- face of a person on the beach, birds on a water, line on a road, dog
- vehicles, animals and remotes
- cars, lines or ducks
layer2-128
human annotations
- checkered patterns
- animal, person, watch, building
- lighter areas
layer2-150
human annotations
- the color blue and purple
- dogs
- blue areas in pictures
layer4-442
human annotations
- the are animals and cords
- dogs on leashes
- items that are attached to each other
layer4-286
human annotations
- curved objects and poles
- bird tails
- include sides of objects
layer4-2011
human annotations
- a train track, a lizard on a log, a pan full of desert, a sign on the side of a boat, a truck going down the road
- rooftops
- a blocked design
layer4-1610
human annotations
- person on a web page holding flowers, old building with monuments, bear, water fixtures outside
- animals, statues and flowers
- have something standing up
layer3-189
human annotations
- a lightbulb, an object you can grab with your hands
- handles of objects
- objects that are shaped like spindles
layer2-310
human annotations
- a guitar pick in string
- colour of the products
- spots of color
layer3-159
human annotations
- menus and keyboards
- keyboards on various devices
- keyboards of laptops
layer3-1010
human annotations
- human arms
- hands
- hands of people
layer4-525
human annotations
- red objects and spheres
- red objects
- red areas
layer4-1188
human annotations
- punching pay, a car on a rack, a kids toy
- cylinders and boxes
- cylinder and circle shapes
layer4-1831
human annotations
- a man standing near water, a women playing tennis, a women near water
- people and poles
- dresses wear by human being
layer3-174
human annotations
- a giant coca cola bottle, space above two goats
- upper regions of the sky above some trees and buildings
- sky
layer2-87
human annotations
- spots of the color white
- small white curvatures
- creases within objects
layer3-998
human annotations
- brown animals
- animal parts
- insect, animal, food
layer4-208
human annotations
- white backgrounds
- edges of round objects
- corners
layer4-476
human annotations
- containers and people wearing helmets
- trucks, clocks, towers and cylinders
- rounded objects and helmets
layer4-1130
human annotations
- insect, pet, space round a bird, piece of fruit, snake
- green balls
- animals or grass
layer1-23
human annotations
- dog sitting on the ground
- areas of yellow and green
- animal
layer2-67
human annotations
- bracelets and text
- apple products
- edges of objects
layer2-249
human annotations
- repeating vertical lines
- pale areas on an object
- checkered patterns
layer3-709
human annotations
- objects with curved edges and edges
- sides of blue vehicles
- rounded edges in pictures
layer4-503
human annotations
- animals and boxes
- brown objects and boxes
- similar color
layer4-1586
human annotations
- poles and animals
- straight lines
- person, food, vehicle, nature
layer1-141
human annotations
- musical instruments and sea animals
- white objects
- white areas in picture
layer3-418
human annotations
- handles and objects near water
- handles of mugs
- handles of things
layer3-152
human annotations
- water on an image, side of a brick building, top of a stop watch
- animals heads and sticks
- black birds
layer4-418
human annotations
- faces of animals and birds
- dogs
- pictures of animal
layer4-913
human annotations
- food items and signs
- animals, food and curved objects
- food with red accents
layer4-1633
human annotations
- this animals, food, pinecones and nails
- oval shaped or striped
- animal, nature
layer2-355
human annotations
- tail end of a boat
- a colored line in them
- vertical lines
layer1-242
human annotations
- the color red and white edges
- red, orange and yellow spots
- red accents on objects
layer2-258
human annotations
- grids, spikes, and fins
- thin long objects with a point
- horizontal line
layer3-918
human annotations
- black holes
- contain circular items
- camera, ipod, water bottle, building, logo
layer4-851
human annotations
- a line of hockey pucks on the ice, things people are holding or long objects
- animals and circular objects
- round black objects
layer4-1409
human annotations
- faces of people, a bench, a lighthouse
- people, animals, vehicles and towers
- two items that are connected
layer4-1920
human annotations
- animals and flowers
- vegetation and textured areas
- sides
layer2-48
human annotations
- spots of the color white next to animals
- animal faces
- around the subject
layer2-75
human annotations
- multiple sections of different shades of color
- dog, person, ipod, money
- lighter areas
layer4-281
human annotations
- animals
- black bugs
- brown and molted looking things
layer4-565
human annotations
- shovels in front of grass
- tools, boats and animals
- birds and shovels
layer4-1612
human annotations
- place in the sand, letters a poster, a clock, a newspaper
- balls, furniture and clocks
- items with corners
layer2-305
human annotations
- scrunchie to clean with
- small checkered patterns and mesh
- clothing, animal, insect
layer3-994
human annotations
- bottles and furniture
- tan and yellow objects
- the tops of objects in them
layer3-475
human annotations
- parts of the top
- clouds, white screen, the sky
- above the image
layer4-1163
human annotations
- tennis balls
- balls, bags and mounds
- round objects
layer4-2047
human annotations
- animals or people that are highly contrasted with the background
- items that are connected
- pictures of animal
layer4-1750
human annotations
- a dishwasher, a side of a baby, the face of a man
- animals, circular objects, people and ceramics
- animal, nature, sign
layer3-208
human annotations
- round cylinders
- tapered shapes
- parts on objects
layer3-229
human annotations
- ear of a dog
- hands and ears
- ears, apple, binoculars
layer3-601
human annotations
- the bottom of circular objects
- frogs and snakes
- glossy area of skin
layer3-156
human annotations
- the color red and blue
- the left side of animals and vehicles
- the westside of the subject
layer4-1210
human annotations
- animals and items in the sky
- animals and curved objects
- dogs and birds
layer4-700
human annotations
- bridges and pyramids
- mountain range, dog, tent
- dome and triangle shapes
layer2-328
human annotations
- a bird going through some brush
- the edges of lines
- places in the world
layer3-94
human annotations
- the side edge of objects
- edges of boxes and bowls
- rounded edges in pictures
layer3-658
human annotations
- electronics
- logos of objects
- written text
layer4-814
human annotations
- sticks, poles and snow
- areas with dark and light colors
- birds and poles
layer4-1415
human annotations
- animals and wooden structures
- animals, fences and circular items
- wrinkled
layer4-1725
human annotations
- a church
- animals and ornate buildings and designs
- curved items
layer3-382
human annotations
- water and feathers on birds
- grey and pale spots
- stomachs of birds
layer3-968
human annotations
- the left side outline of a object or the sky
- pale spots
- blue skies
layer4-270
human annotations
- bridges, clothes and chains
- objects containing lines and wires
- bridges
layer4-414
human annotations
- animals, and steel items
- birds
- animal, paint brush, vase, helmet
layer4-1600
human annotations
- a bird on theback, a insect, a keyboard
- rails, legs and chains
- animals
layer4-1795
human annotations
- a memorial, a typewriter, a to in the field, a person playing keyboard
- electronics, buildings, pianos and floors
- old electrical machines and one tombstone
layer2-365
human annotations
- spots of the color white
- space above a man's head
- small lines on a structure
layer1-120
human annotations
- the color pink, red, and purple
- purple objects
- these include red or blue
layer3-574
human annotations
- vases, pumpkins, wheels and birds
- unicycle
- rounded items like duck upper bodies
layer4-346
human annotations
- produce and things with dots or keys
- produce
- bright colored area
layer4-815
human annotations
- animals, keys and screws
- spiked forms of life and pianos
- similar patterns
layer4-872
human annotations
- eyes and neck of people
- sunglasses, crowd of musicians. scarf a person is wearing, baby
- people, dogs, coffee, and lights
layer1-90
human annotations
- fluorescent blue and pink objects
- objects with purple lights
- purple areas
layer2-89
human annotations
- repeating black lines
- black mechanical objects
- objects with lines/ditches in the item
layer4-352
human annotations
- things shaped like bows and shelves
- bookshelves
- this region shows two similar parts that are separated by a third area
layer4-350
human annotations
- animals and wooden objects
- noses and objects that resemble them
- bugs and faces
layer4-1380
human annotations
- the ocean
- ocean waters
- animal, nature, person
layer4-1859
human annotations
- a man holding an alligator, a man dome in the background a bird in a branch a light, a snake
- animals and things shaped like a dome
- circular features
layer3-46
human annotations
- round edges of objects
- ball, striped shirt, wheel, person
- edges of objects
layer4-206
human annotations
- wooden paths and roads
- roads and mirrors
- walkways and roads
layer3-759
human annotations
- trains and vehicles
- train cars
- objects that have a striped nature
layer4-971
human annotations
- faces of people wearing glasses
- faces and circular objects
- heads, and objects that resemble them, against backgrounds
layer4-1124
human annotations
- birds and furniture
- objects with lines
- eagles and leaves
layer2-323
human annotations
- a group of students in a row, a church
- checked or striped
- animal, person
layer1-67
human annotations
- text on the side of a ballon
- the tops of words and curved animals
- nature, people, structure, text
layer2-252
human annotations
- arms and legs
- nature
- edges of objects
layer3-572
human annotations
- dog ears
- eyes of different dogs
- ears
layer4-788
human annotations
- dogs and tower
- arms of people
- similar color
layer4-1359
human annotations
- the ground, piggy banks, and rounded objects
- brown dogs
- dirt
layer2-41
human annotations
- food in a dish or a plate, a motorcycle parked, space above flag flying high, a helmet, a space above a sunset
- areas that contain or reflect light
- sunset and lighting
layer3-497
human annotations
- circular objects and curves
- legs or look like legs
- round objects
layer4-271
human annotations
- electronics, dogs and buses
- radiators
- screen, window, animal
layer4-1157
human annotations
- round objects
- animals and bottles
- birds and toys
layer4-1992
human annotations
- bottom of a statue, pendant on a necklace, drain a kid is playing on, adog's feet
- circular or slatted
- animal, nature, balloon, person
layer3-199
human annotations
- two connecting points
- picket fence behind a dog
- towers and jacket lapels
layer3-349
human annotations
- text on the side fof a car,boat, or other vehicle
- buttons and letters
- black numbers on vehicles
layer4-88
human annotations
- vehicles and furniture
- vehicles
- building, rock, ship, water, tank
layer4-233
human annotations
- animals and buildings
- brown dogs
- sides of objects
layer4-995
human annotations
- sticks, handles, poles and other long thin objects
- long, thin objects
- skinny poles
layer4-1858
human annotations
- black and white birds and animals
- bird, person, whale
- black objects in pictures
layer4-1875
human annotations
- vehicles and people holding objects
- objects being held by people, and various objects
- items with angles
layer2-37
human annotations
- areas under poles and lines
- blue skies
- areas with a gradient of color
layer3-139
human annotations
- backgrounds
- faces of land animals
- nature
layer3-717
human annotations
- things shaped like bottles, legs or dots
- areas that contain multiple objects
- metal tools
layer4-990
human annotations
- faces of people
- people, animals and vans
- faces in humans
layer4-1054
human annotations
- animals and bulbous objects
- black birds
- water tower, animal, person
layer1-28
human annotations
- some sun lotion
- instruments and faces
- very small dots of color
layer2-429
human annotations
- trafic cone, stick bug, space on random points of a motorcycle.
- red and orange dots
- items that have red in them
conv1-59
human annotations
- rim of a car
- white outlines of objects
- insect, logo, needle, gauge
layer3-791
human annotations
- balloon shaped objects
- hot air balloons
- things with fanned out lines
layer4-23
human annotations
- straight lines
- many stick like objects, all near perfect straight lines
- things with long extremities
layer4-716
human annotations
- animals
- grass and textured backgrounds
- black and white animals
layer4-1286
human annotations
- lights, buses, camera, buildings and birds
- dark shapes surrounded by lighter colors
- cameras
layer4-1910
human annotations
- boat, a handbag, insects, a dress
- people, animals, and food
- the sides of objects
layer2-179
human annotations
- the color white in small, circular spheres
- dots outlining a object
- circles of white
layer2-197
human annotations
- white and black borders
- white bars
- specific patterns
layer4-557
human annotations
- floral patterns and white walls
- walls, windows, and pictures
- white objects and screen doors
layer3-739
human annotations
- things on necks and stripes
- ties and collars
- there a bowties on a bunch of people and collars on dogs
layer4-1444
human annotations
- dog, ship at sea, clock, dogs on the snow, text on a sign
- items that are connected
- rounded edges in pictures
layer4-1542
human annotations
- a duck on the water, a baby, a pearl
- circular objects
- circular features
layer2-329
human annotations
- spots of blue bordering objects
- spaces on a tied knot
- small colorful circles
layer1-149
human annotations
- a creature in the ocean, a shark
- oceanside and the ocean
- flower, water, animal
layer3-96
human annotations
- pale color gradients
- bright light shining
- the photograph represent objects with gradients
layer3-552
human annotations
- fluorescent green and red objects
- colored areas that contain red hues
- area where text or glossy design is
layer4-1203
human annotations
- produce, eggs, and toys
- round fruits and balls
- people, animal, fruit
layer4-614
human annotations
- animals and shoreline
- animals and rounded objects
- spotted dogs
layer4-1856
human annotations
- animals
- items that are connected
- skin like surfaces
layer2-453
human annotations
- a bird lands on a stump, a mousetrap with a dollar
- dots on lights
- small spots of glowing color
layer1-65
human annotations
- dog in the park
- green textured things
- negative lighting
layer3-840
human annotations
- white fur on animals and food
- foreheads of brown dogs
- multiple colors in them
layer3-769
human annotations
- body parts of plants and animals
- metal objects
- a curved edge
layer4-994
human annotations
- animals and ships
- areas with several lines or texture
- ships
layer4-1000
human annotations
- phone cords
- coils
- striped features
layer1-11
human annotations
- letters of a clock, letters of a frisbee, leaves of a plant, text on a object
- black lettering on rounded objects
- bits of areas that are black and another color on the edge of things
layer2-14
human annotations
- white text
- white and black lettering
- letters
layer2-274
human annotations
- outlines of objects
- on the sides of objects
- mirror, tuck, person, animal, food
layer3-961
human annotations
- windows and wheels
- white areas surrounded by darker colored areas
- things with gaps
layer4-1202
human annotations
- a mixture of actual or reflected white and reddish-brown coloration
- brown objects
- amber colored objects
layer4-1373
human annotations
- repeating lines and objects
- people, animals, and repeating objects
- repeating objects form a pattern
layer4-1734
human annotations
- animals and knobs
- rounded edges or objects
- rounded edges in pictures
layer4-1793
human annotations
- objects in the sky
- animals, windows and buildings
- items that have straight features
conv1-56
human annotations
- a rooster on a table
- black and white lettering
- the outline edges of objects
layer3-447
human annotations
- single colors and corners
- smooth, plastic surfaces
- corners of things
layer3-537
human annotations
- backgrounds
- land animals
- white areas above object
layer4-434
human annotations
- animals and circular objects
- fur, feathers and other textures
- brown animals
layer4-608
human annotations
- animals and baskets
- objects with appendages
- brown dogs
layer2-494
human annotations
- aquatic life, food, insects, animals, clothing
- lettering
- similar patterns
layer1-243
human annotations
- black and white borders
- a guitar pick in some strings
- striped clothing and objects
layer4-312
human annotations
- balls and animals
- shaggy dogs and tennis balls
- rounded objects and furry animals/objects, and things that look similar to fur but aren't
layer4-224
human annotations
- mountains, flags and flooring
- the mountains
- white structures covering items
layer4-1982
human annotations
- insects, people, dogs, and a cheetah
- grass and plants
- dogs and spiders
layer4-1070
human annotations
- a man in a field kneeling, clothing, dog on the other side of a fence, a broom hanging up
- people holding objects
- angles
layer1-68
human annotations
- space on the barrel of a gun, edge of a table with tools on it
- parts of striated things
- ridges
layer3-333
human annotations
- small holes and screws
- cylinder and circular objects
- round objects
layer4-211
human annotations
- dark areas that contrast with other areas, the dark areas form one or more corners
- electronics, birds and shirts
- silver and black squares
layer3-852
human annotations
- animal fur
- grass and trees
- contain long, thin items
layer4-1324
human annotations
- animals, and diagonal lines
- trucks
- boat, truck, pencil sharper, water
layer4-1372
human annotations
- graphic on a package, holds, cheetah, fox
- animals, tools and instruments
- multiple items that are similar
layer3-380
human annotations
- repeating gray and brown lines
- pieces of metal that are pointed
- specific patterns
layer3-503
human annotations
- the top of buildings and a rocket
- middle eastern style buildings
- top of buildings or signs
layer3-753
human annotations
- sticks, animals and the background
- brown dogs
- the midsection of objects
layer4-474
human annotations
- computer towers and buildings
- backgrounds
- hands and dogs
layer4-1142
human annotations
- bowls and circular items
- clothes, dogs, bowls and sticks
- two items that are connected
layer4-1820
human annotations
- dogs and cylindrical objects
- animals and objects that resemble them
- two items that are connected
layer2-110
human annotations
- collar of a dog, a spider web, strap to an accordion, a fence, a musical playing on the street, a glass pitcher
- horizontal stripes
- black lines
layer3-330
human annotations
- tree, tower, a telephone, a birthday cake
- the background
- blue skies
layer3-734
human annotations
- animals
- human and animal appendages
- monkeys
layer4-289
human annotations
- animals and sticks
- sea creatures and land animals
- long straight items in them
layer4-1993
human annotations
- animals and green objects
- birds
- cactus and other vegetables
layer4-1326
human annotations
- tall objects holding liquid
- bottles, ships, candles and needles
- items that are standing up
layer2-114
human annotations
- fluorescent blue and purple outlines
- purple areas
- pink, purple, and blue areas
layer1-105
human annotations
- speedometer, a heart made of glow sticks, a line going down a gun, a dogs flu with it, a person playing an instrument
- white and black numbers
- a black line in them
layer3-947
human annotations
- jewelry, helmets and metal objects
- food, flower, radio, gun, person
- spots in pictures
layer4-1263
human annotations
- animals and horns
- red hued areas
- faces
layer4-1606
human annotations
- cylinders, animals and instruments
- people holding objects up to their mouths
- two items that are connected
layer4-1825
human annotations
- dog, a vent in a restaurant, a bird on the water, a turtle on the sand, a dog with his toy, a bird
- animals and ceilings
- items with curves
layer3-854
human annotations
- buildings and patterned fabrics
- windows of buildings
- long windows
layer4-324
human annotations
- dogs and red objects
- dogs
- snout looking things
layer4-1042
human annotations
- bookshelf, insect, rocks, dog
- textured areas
- areas with two items connected
layer4-1414
human annotations
- legs of insects and edges of structures
- natural backgrounds
- brown and red objects
layer1-74
human annotations
- a bird on a branch
- pale spots
- small details of animals, images and words
layer2-101
human annotations
- the sky above animals
- foxes and other land animals
- the part of the top area
layer1-155
human annotations
- the color green
- dog standing in grass
- fluorescent blue and green backgrounds
layer3-327
human annotations
- a dog's paw, a bird sitting on the beach
- blurry backgrounds
- pink areas of objects
layer3-563
human annotations
- electronics
- areas that contain dark lines
- a thin line through them
layer3-676
human annotations
layer4-621
human annotations
- circular objects and electronics
- brown dogs
- bugs and animals
layer4-697
human annotations
- edges of objects and skin of white people
- water features, fabric and leaves
- shoulders and arms
layer3-12
human annotations
- circular objects
- pale spots on objects or people
- white dots on objects
layer4-95
human annotations
- animals and ships
- textured areas containing lines
- items that have openings
layer4-453
human annotations
- animals
- objects with white features
- brown dogs
layer4-659
human annotations
- animals and rocks in the ground
- animals, lawns and bridges
- white shirts and greenery
layer4-2027
human annotations
- chain, tower, icecream cone
- objects with zig zag design
- two items together
layer3-458
human annotations
- people rowing boats
- shoes
- rounded edges in pictures
layer3-664
human annotations
- eyes, flower buds and windows
- noses of brown animals
- the patches of white on a person, animal, insect, building, or other object
layer4-339
human annotations
- boxes, lights and animals
- objects containing grey hues
- tones on different rounded structures
layer4-1575
human annotations
- chainsaw, bush, negation in the water, watch someone is wearing
- green objects
- green items
layer4-1533
human annotations
- sticks, screws and animals
- items with patterns
- animals, insect, nature
layer2-427
human annotations
- spots of the color white and blue
- a van, a clock collectable, a van, a ask mask
- noses of animals
layer1-131
human annotations
- sharks in the ocean, a person cutting up some fish, a squirrel eating a pizza slice, a shark in theycan
- animals and aquatic life
- text and living things
layer3-665
human annotations
- things shaped with bumps
- yellow objects
- skin and body parts
layer4-287
human annotations
- yellow objects and flowers
- grass and vegetables.
- green grass
layer4-1350
human annotations
- animals and the ocean
- white dogs
- white or a light color
layer4-731
human annotations
- swirls, dogs and hay
- objects with lines and texture
- metal spirals
layer2-398
human annotations
- bottom of a ball
- pieces of partly blue items
- blue and orange areas
layer2-413
human annotations
- man's face as he speaks through the microphone
- contain hot pink
- red objects
layer3-786
human annotations
- outlines of white objects
- creams
- rounded edges in pictures
layer4-181
human annotations
- objects with curved corners
- corners of buckets
- rounded corners
layer4-1221
human annotations
- animals, bricks, and metal objects
- metal objects
- rounded edges in pictures
layer4-1839
human annotations
- multiple, parallel lines
- areas with lines or grids
- two items that are similar
layer2-409
human annotations
- mushrooms growing in the ground, a dogs leg with space around
- lines and edges
- animal, person
layer2-142
human annotations
- fur, plumage, and hair
- spots of the color white
- white colored spots
layer3-636
human annotations
- the sky and background
- blue skies
- the sky
layer4-492
human annotations
- shiny surfaces and fur
- people, fire escapes, and the beach
- similar color patterns
layer4-838
human annotations
- home appliances and objects with edges
- animals, vehicles, appliances and electronics
- computers and kitchen appliances
layer4-1460
human annotations
- dog, bear, horse
- white dogs
- items that are curved
layer3-254
human annotations
- the front of a moped the front of a van
- tires
- car, bike, person
layer4-83
human annotations
- animals, grates, and crosswords
- crossword puzzles
- crossword puzzles and animals
layer4-1275
human annotations
- spots of objects and animals
- circular objects, plates, and animals
- rounded edges in pictures
layer3-224
human annotations
- pale backgrounds
- keys on a piano that has space
- drawing, person, spoon, animal
layer2-100
human annotations
- areas where light is gleaming
- white spots on clothing and animals
- blue areas
layer3-772
human annotations
- furniture, bird bodies and walls
- wooden tables and desks
- bird, tree, person, food, anima, table
layer4-628
human annotations
- animals
- breeds of dogs
- pictures of animal
layer4-2012
human annotations
- space on the left side of someone's jacket,sapce on a bike trail, space on pond
- trees, poles, sticks and water
- multiple bodies of water
layer1-140
human annotations
- whiskers of a cat, aperson getting ready to aim a weapon, a dog posing for a photo, plant life
- diagonal lines
- lines
layer2-214
human annotations
- white repeating spots
- vehicles
- similar patterns
layer4-55
human annotations
- animals, buses and shirts
- dogs or pocket like areas
- fronts and backs of objects
layer3-962
human annotations
- white and black animals
- objects with patterns
- pictures of animal
layer4-609
human annotations
- animals, grass and clothes
- brown dogs
- pictures of animal
layer4-1690
human annotations
- a person doing laundry, a statue, a soldiers clothing, a statue
- an irregular rounded surface or wrinkles
- the regions have items with folds
layer1-34
human annotations
- white borders around animals and objects
- a dog carrying a stick, a dog posing for a picture with owner, a dog with a hat, a flower
- small black eyes and legs
layer3-37
human annotations
- flowers of a pedal leaf, a watering tool, a compass, a dome ceiling, a musical instrument, wheel above a person playing pingpong
- things shaped like flower petals
- similar patterns
layer3-147
human annotations
- steel and birds
- objects with horizontal lines
- the ridged portion of several different objects
layer3-912
human annotations
- car, train, typewriter, scarf
- blue backgrounds
- blue and white items
layer4-888
human annotations
- hands, balls and bottles
- human hands
- people
layer4-1112
human annotations
- horse, person standing on a whale, a fly, a comic book, a horse
- animals and pictures
- animals
layer3-7
human annotations
- brick walls
- brick walls
- brick pattern
layer2-59
human annotations
- pale areas consisting of tan, grey and white
- objects with different ridges
- bands that look like a screw
layer4-467
human annotations
- animals, water, sticks and grates
- background behind object
- the sides of objects
layer4-1995
human annotations
- ship on sea, a bridge, a insect, place in the sky
- animals, ships and furniture
- these things are brown colored
layer4-1102
human annotations
- balls and dogs
- areas with green or grey
- small balls
layer2-356
human annotations
- the back part of a zebra
- tan skin and black and white stripes
- seat, person, tree, sky
layer2-156
human annotations
- spots of the color white
- pale spots without color
- brighter areas in objects
layer3-513
human annotations
- animals
- noses on dogs
- animal
layer4-404
human annotations
- areas containing lines
- faces of people
- curved items
layer4-857
human annotations
- fruit, a bird, bike tire. adog
- animals, produce and wheels
- textured objects
layer4-1752
human annotations
- objects with strong lines
- items with straight features
- animals, person, plant
layer4-1936
human annotations
- faces of people, dogs, buses, cars
- the insides and outsides of cars
- on the sides of items
layer1-57
human annotations
- top of an alarm clock
- white dots on animals and grates
- plant, pan, pot
layer2-147
human annotations
- the color blue
- land animals
- people, animals, insect
layer4-57
human annotations
- bottles, pens and animals
- bottles
- bottles
layer4-1276
human annotations
- animals, violins and things shaped like amoebas
- a wavy design on them
- items with curved features
layer4-1773
human annotations
- a guitar neck with a pick, a sign with some letters, a girl giving a dog a kiss
- dogs, pens and things shaped like triangles
- animals
layer2-318
human annotations
- a tuscan, a water tower, a taxi
- outlines of curved objects
- a line through them separating color
layer1-129
human annotations
- color purple
- pink and purple objects
- purple lighting
layer3-68
human annotations
- human faces
- shoulders of people and a couple tools
- shoulders of people
layer3-866
human annotations
- animal noses
- brown animals
- circular areas
layer4-1107
human annotations
- fruits and spherical objects
- shovel, chain link fence, a flute, fruit in a basket
- poles, circulars and mouths
layer4-1289
human annotations
- animals and candles
- yellow objects
- animal, nature
layer3-985
human annotations
- white spots and lines on clothing
- clothes
- similar patterns
layer3-738
human annotations
- animals, fruits, and shirts
- faces of animals
- neck of bird
layer4-1478
human annotations
- screwdrivers, dog on the grass
- poles, tools and animals
- a pole like object
layer2-174
human annotations
- where two lines meet to make a cross design
- windows and repeating lines
- pale spots around dark objects
layer2-77
human annotations
- dogs
- stove, instrument, bathroom, insect, animal
- specific patterns
layer4-817
human annotations
- faces and legs
- textures; fur, feathers, fabric, scales and hair
- light haired dogs
layer4-303
human annotations
- land animals
- the backs of animals
- items that are curved
layer4-1748
human annotations
- a man with a bandaid on his head, a mushroom growing, a football player with a helmet, a cat looking through a window
- kids and dots
- bandages and babies
layer4-1632
human annotations
- soldiers hat, duck, a boy and his dog, man and his stack of wood
- people, dogs and the ocean
- living things
layer2-111
human annotations
- black and white text
- white objects or text surrounded by darker colors
- specific patterns
layer2-204
human annotations
- red and white colored areas
- long and thin horizontal rods
- lines and patterns
layer3-713
human annotations
- animals, blue objects and electronics
- object with rounded corners
- colorful toys
layer4-493
human annotations
- people with white skin holding objects
- animals and bottles
- human faces
layer4-1044
human annotations
- a dog on theground, a bus, a dog on the snow, a car
- animal faces and various vehicles
- two items that are connected
layer4-1469
human annotations
- kid, fruit in a cup, dog
- kids and a dog
- living things
layer3-35
human annotations
- tops of objects such as mushrooms and bottles
- red caps and roofs
- specific patterns
layer4-522
human annotations
- animals and poles
- paws of different animals
- pictures of mammals
layer4-1128
human annotations
- a baseball player's outfit, a fish on the ground, a bowl, a cup on a table, a train going down the tracks, an insect
- curved items
- person, food, vehicle, nature
layer1-159
human annotations
- space following the trip of a motorcycle
- white lettering and radios
- white dots
layer3-470
human annotations
- reflective surfaces and water
- shiny and have bends in them
- things with a white color
layer3-547
human annotations
- brown dog legs
- dogs legs or spots in an object
- vertical patterns
layer4-549
human annotations
- produce and animals
- green orbs
- rounded edges in pictures
layer4-689
human annotations
- onions in a field, food on a plate, golf balls
- dots and food
- textures and patterns
layer4-1924
human annotations
- items on top of tables or other surfaces, including games, printed materials, tile samples, and a snake
- areas with multiple objects grouped together
- multiple items that are similar
conv1-19
human annotations
- a guitar pick in some strings
- black and white mechanical objects
- white lines
layer2-205
human annotations
- repeating stripe and dot patterns
- objects with perforations
- similar patterns
layer3-745
human annotations
- legs of people, animals, and chairs
- ground
- chairs
layer4-798
human annotations
- barns, animals and boxes
- barns and grassy plains
- water and sky and houses
layer4-1769
human annotations
- people enjoying the outdoors
- bottles, crutches, vehicles and remotes
- items that can be held
layer2-190
human annotations
- the color white in small, circular spheres
- black patterns on vehicles and buildings
- lighter areas
layer2-263
human annotations
- metal objects
- items with skinny metal lines
- bird, screw, watch, cable wire
layer4-828
human annotations
- balls and animals
- green objects
- on the sides of objects
layer4-506
human annotations
- furniture and ceramics
- objects with lines
- items have lines , designs or edges
layer4-1644
human annotations
- pendant, radiator, shirt a man is wearing, vest a man is wearing
- clothes, animals and pipes
- green and blue objects
layer2-106
human annotations
- black and white corners of objects
- ears of animals
- the tips of objects
layer2-103
human annotations
- an aquatic animal, a guy riding in a truck, people posing for a photo
- pale spots next to dark areas
- letters and numbers that are black and white
layer4-318
human annotations
- poles and straight lines
- human faces
- the sides of objects
layer4-432
human annotations
- small animals with fur
- animals and buckets
- pictures of animal
layer4-1989
human annotations
- aquatic life, bird on a branch, a truck going through the grass, a dog on the pavement
- animals, furniture and vehicles
- angles
layer4-1971
human annotations
- a cat laying on a laptop screen, a fossil, a women wearing a skirt
- food, animals and boas
- colorful accessories and feather boas
layer2-309
human annotations
- a persons fake mustache, space above a zebra
- animals in the forest
- animals in the places
layer3-151
human annotations
- animal necks and poles
- necks of different birds
- necks of animals and tube shaped objects
layer4-806
human annotations
- animals and things with stripes
- animal tails and objects that resemble them
- striped tails
layer2-412
human annotations
- borders and corners
- the corners of curves
- sharks and red objects
layer2-484
human annotations
- black spaces in between lines
- small black dots and sharks
- spots in pictures
layer3-586
human annotations
- plaques, animals and signs
- legs of a bird
- two similar items that are separated
layer3-847
human annotations
- tires and feet
- animal legs and wheels
- feet or bottom area of objects or people
layer4-937
human annotations
- paws of animals and people working
- water and tables
- dogs with collars
layer4-1620
human annotations
- protruding object
- two connected items
- animals
layer2-71
human annotations
- pale spots on various objects
- light colored spots on an image
- lighter areas
layer3-118
human annotations
- pencils, sticks and legs
- the ground or writing utensil parts
- backgrounds in pictures
layer3-747
human annotations
- people and area above curved lines
- birds
- the edges of items
layer4-955
human annotations
- deer, dog, baby, man, adog
- animals
- pictures of animal
layer4-1592
human annotations
- the sky
- grass and trees
- areas around objects
layer4-1506
human annotations
- a insect, a bird in the sky, a snake in the grass, space below a sign
- items with straight features
- animals, people
layer3-799
human annotations
- rounded areas of living things that show shading and have only one light source
- animal faces and torsos
- dogs
layer4-193
human annotations
- fences
- chain-link fence and tile
- a lot of chainlink fencing and some wallpaper with a chainlink pattern
layer4-1232
human annotations
- snakes and other creatures
- items with straight features
- rounded edges in pictures
layer4-996
human annotations
- palm sized objects
- animals
- people holding objects
layer1-184
human annotations
- space through the text of a graphic, people walking down a trail, a instrument on a sofa, animals posing for a photo
- red dots and white dots between words
- very small dots
layer2-425
human annotations
- pedal's on a flower
- bugs and flowers
- nature, car, tuck, animal
layer2-491
human annotations
- the color green
- green areas in nature
- green areas in picture
layer3-34
human annotations
- mouths of animals
- fireworks and whiskers
- spray shapes like a firework
layer4-426
human annotations
- animals and flowers
- food
- similar color patterns
layer4-1189
human annotations
- furniture, tents and other wooden items
- pale, rectangular objects
- things outside
layer4-1355
human annotations
- things with poles and trees
- tapered objects
- animal, crutches, parking meter, water tower
layer4-2000
human annotations
- bison, spider, baby, bird
- animals
- brown animals
layer2-108
human annotations
- a whale diving in the ocean, a group of tall buildings, clothing, people in a group setting
- area where one object ends and another begins
- part textured and part solid color
layer2-74
human annotations
- balls, circles and fruit
- small red objects
- similar patterns
layer4-445
human annotations
- dogs, beaches, and food
- ocean shores
- pictures of animal
layer4-304
human annotations
- jeans and animals
- items that intersect other items
- legs of people
layer4-1375
human annotations
- punching bag, sink, pretzel
- rails, appliances and furniture
- smooth surfaces
layer4-2019
human annotations
- dog, shirt, crossword puzzle
- dogs, cups and crosswords
- angles
layer1-73
human annotations
- buttons on a remote, a dogs ears
- yellow and blue objects
- devices with numbering as well as dogs
layer3-170
human annotations
- semi-circular regions that resemble eyes
- front of a trolley car, a bucket, a tire of an old car
- pink flowers and ears
layer4-89
human annotations
- circular and square objects
- human hands
- regions with squares
layer3-101
human annotations
- eyes and noses
- dog eyes
- the eyes, mouth or ears of dogs
layer4-1017
human annotations
- animals and things that look like flowers
- people upside down
- each region has symmetry
layer4-1233
human annotations
- left and right side of a shirt, a plastic bag, side of a jacket, back of a tractor
- shirts, dogs and vehicles
- areas with a white color
layer4-1730
human annotations
- noses and objects that may resemble them
- objects with holes, children and various animals and stuff animals
- rounded items
layer2-284
human annotations
- outlines or keys, grates and similar objects
- honeycomb patterns and grilles
- car, building, clothing
layer3-420
human annotations
- chins and rounded objects
- round and colorful objects
- yellow areas in pictures
layer4-357
human annotations
- food, animals and pillows
- white shaggy dogs
- regions where two items are touching
layer4-604
human annotations
- sticks, straws, water and feathers
- straw
- rounded edges in pictures
layer4-1763
human annotations
- a memorial sign, a spider in a web, a plunger on some gravel, a later
- ladders, animals and plaques
- multiple items that are similar
layer4-1486
human annotations
- a shovel on the gravel, person's shirt, handle of a bag, dog's snout
- the regions have items with splits
- backgrounds in pictures
layer2-31
human annotations
- orange and yellow food items
- pieces of yellow in them
- food, fruit, instrument
layer3-127
human annotations
- repeating lines and edges of objects
- horizontal lines
- person, food, animal, collar
layer4-550
human annotations
- textured objects
- brown animals
- items with straight edges
layer4-1173
human annotations
- water tower in the sky, a mannequin, round object in the sand, food, a water barrel
- animals and cylindrical
- white objects
layer4-1385
human annotations
- wooden surfaces, animals' plumage, animals fins, and a few animals' heads
- benches, animals, thorns and the ground
- pictures of animal
layer2-319
human annotations
- spots of the color white on borders
- theright side of a dog, a dog eats something off a plate, aperson explore a wreck in the ocean, a scuba diver poses for a photo, a bird sits on a ledge, a person blows bubbles
- white boarders of legs and round edges
layer3-89
human annotations
- pens, tools and woodwind instruments
- the bands on writing utensils or other items like that
- stick like objects
layer4-48
human annotations
- animals
- brown and black animals
- animals in places
layer3-760
human annotations
- dog whiskers
- dog mouths and necks
- shaggy dogs
layer4-595
human annotations
- people and animals
- animals and cassettes
- snakes and brown animals
layer4-2037
human annotations
- wine glass, glass, water, ball
- long and slender objects
- mailbox, logo, water, person
layer4-1732
human annotations
- a bird on a pole, theft of a wheel, a forest during winter, a brick restaurant with an american flag
- textured areas
- where two items connect
layer2-414
human annotations
- toast with cheese or something on it
- words and grids
- a couple of lines in them
layer2-22
human annotations
- spots of the color white and borders
- stripes and patterns
- specific patterns
layer3-787
human annotations
- ears or the shiny areas of object
- string instruments
- musical instrument, ears of animals
layer4-361
human annotations
- people in snow and dogs
- animals, snowmobiles and trees
- dogs
layer4-1218
human annotations
- backgrounds of animals and everyday objects
- textured backgrounds
- white walls
layer4-1629
human annotations
- fur and vegetation
- very small animals are listed
- items that are connected
conv1-49
human annotations
- orange objects and creatures
- nothing
- nothing
layer3-238
human annotations
- two people wearing a dress
- steps, dresses, rocks
- hands or paws
layer2-240
human annotations
- small colorful balls
- plane, ball, building, sign, letters
- lighter areas
layer3-582
human annotations
- light reflections
- ground
- a gritty texture to them
layer4-630
human annotations
- electronics, circular objects and dogs
- electronic devices
- angles
layer4-923
human annotations
- a hunter in the grass, airplane engine, a person lifting weights, a person walking down the street
- animals and vehicles
- green trees and grass
layer4-1740
human annotations
- women's shoulder, feet of a women, insect, man
- have text
- rounded edges in pictures
layer2-20
human annotations
- a fox in the wild, dogs laying in the grass, a church on the inside
- dogs
- living things and non living things
layer2-60
human annotations
- spots of the color white
- dots outlining nature and appliances
- similar patterns
layer3-736
human annotations
- animals
- dogs and other animals
- animal, insect
layer4-785
human annotations
- fences, dogs and bridges
- fur and lined objects
- fencing
layer4-1438
human annotations
- animals and phones
- textured areas
- white animals
layer4-1423
human annotations
- graphics on a sign, food, baseball
- balls, animals, and food
- items with patterns
layer3-346
human annotations
- the color blue and water
- a musical on stage, a sunken boat, a light up water bottle, a sea of fish
- blue light and aquatic life
layer3-974
human annotations
- repeating gray and silver lines
- types metal objects
- things made out of metal
layer4-237
human annotations
- animals, circular objects and produce
- rounded objects and animals
- rounded objects
layer3-733
human annotations
- the snow and flooring
- shoes
- parts of the ground
layer4-1563
human annotations
- legs of people and animals
- animals, pants and boxes
- limbs, torsos, and pill bottles
layer4-1663
human annotations
- marking of object which can be eaten
- green in them
- regions with curved items
layer1-80
human annotations
- airplane with text on the side, a bird with a beak, a dog, tech on a lawn, legs runnig around
- part of areas that straddle two colors
- lighter areas
layer3-472
human annotations
- the spot where the sun is hitting different animals
- fur on animals
- dog noses
layer3-611
human annotations
- animal noses
- noses of birds and animals
- nose and mouth or beak of creatures
layer4-799
human annotations
- animals, coastline and food
- textured areas
- cliffs
layer4-901
human annotations
- insect on a person, side of a table a dog is on, a apple, a light pole, a side of a bed, the floor of a room next to a dog, a bird next to water
- poles, animals and furniture
- human hands
layer4-2039
human annotations
- animals, beaches and the road
- underneath objects
- flat, sand covered ground
layer3-338
human annotations
- the ears and horns of animals
- ears of brown animals
- ears and horns
layer3-997
human annotations
- faces of people
- the nose and the mouth part of something's face
- faces of things
layer4-247
human annotations
- animal heads and metal objects
- faces of white dogs
- animals, lights, building
layer3-740
human annotations
- animals and curved objects
- wings of brown birds
- similar color patterns
layer4-915
human annotations
- objects made up of multiple lines and fabric
- animals and clothes
- person, animal, clothing
layer4-1628
human annotations
- animals and people
- brown dogs
- person, nature
layer2-353
human annotations
- a bird sits a top a branch, text on a object, items on a shelf, ballons in the sky
- text, balloon, ball
- text and logos
layer1-172
human annotations
- spots of the color white
- horizontal lines and dots
- bits of white and yellow pieces
layer3-477
human annotations
- legs
- pants
- the legs of people standing in front of object
layer3-628
human annotations
- reptiles and hands
- popsicles
- person, food, insect, power tools
layer4-1156
human annotations
- a bird on a pole, a object a girl is holding, a feather a boy is holding, a bowl a girl is sitting in, a boy is looking at something, a burst of water going through a hose, a bird walking on the grass
- animals and poles
- smoke in the air
layer4-876
human annotations
- small furry animals
- animals, sticks and vases
- brown animals
layer4-1914
human annotations
- curved lines and edges
- insect, dog, clothing
- rounded edges in pictures
layer2-46
human annotations
- animals
- the edges range from really soft to very hard
- edges of objects
layer3-989
human annotations
- noses of animals
- noses of different dogs
- front of objects
layer4-479
human annotations
- animals
- furry animals and fabric
- furry animals
layer4-425
human annotations
- cylindrical objects
- black objects that are rounded
- vegetables, spoon, mouse
layer4-1125
human annotations
- a person holding a gunn, a dog's snout, a can opener
- metal objects
- person, nature, boat
layer4-1455
human annotations
- dog in the field. rock cliff, person in the pool, meerkat
- brown dogs
- items that are connected
layer3-355
human annotations
- hands and knees
- human hands
- parts of people
layer3-691
human annotations
- striped and poles
- man made objects containing vertical lines
- poles and bridges
layer3-675
human annotations
- noses, columns and moisturizer
- faces of brown monkeys
- building, pencil, animal
layer4-1427
human annotations
- thesea re objects with red or phones
- angles
- mailbox, gas can, lawn mower
layer4-1945
human annotations
- a kid wearing sunglasses, a kid in a swing set, a bench in a sunroom
- people, vehicles, and benches
- surfaces with lines or texture
conv1-55
human annotations
- text and images on a magazine
- the thin yellow edge next to objects
- lines that outline an object
layer2-112
human annotations
- brown dogs
- many black lines in different patterns
- lighter areas
layer3-79
human annotations
- mushrooms and spotted areas
- mushroom caps
- spots or a short line
layer4-241
human annotations
- black objects and birds
- birds and black objects
- tools and instruments and weapons
layer4-1144
human annotations
- animals
- shaggy dogs
- the front of items
layer4-1465
human annotations
- a sign in the sand, an eraser, a pillow on a bed, a microphone
- rectangular objects
- objects with straight lines
layer4-1737
human annotations
- animals and circular objects
- animals
- living things in them
conv1-62
human annotations
- trim of a radio, top of seats, boarders of an animal
- lines of edges of borders of things
- label, washer, vehicle, animal
layer1-101
human annotations
- spots of the color white
- a few divers in the water, a shark, two kids on a bike, a couple snakes
- spotted areas in pictures
layer3-541
human annotations
- windows and dots
- older buildings
- bottle, building, plan, spider, window
layer4-205
human annotations
- holes and hands and matches
- human hands
- hands and plants
layer4-802
human annotations
- animals and vending machines
- wild animals that have brown and grey fur
- pictures of animal
layer4-687
human annotations
- towers, animals and produce
- monuments and towers
- long, tall objects
layer1-81
human annotations
- a gazelle, a goat's horns. a bird
- white dots on animals
- ears and tan animals
layer1-116
human annotations
- spots of the color white
- multicolored dots
- small areas in between items
layer4-111
human annotations
- animals, wooden objects and bikes
- regions with items that are on a surface
- electronics, statue, people, desk
layer3-637
human annotations
- artwork, animals and clothes
- black and white patterns
- various stripped objects
layer4-724
human annotations
- people holding objects and tools
- hands
- hands in them
layer4-1041
human annotations
- yellow and red objects
- poles, animals and candles
- human hands
layer1-241
human annotations
- the eye of a seagull
- grey areas
- eyes of birds
layer2-408
human annotations
- light, pacifier, support wires for a bridge ,spacesa round peoples heads
- industrial objects
- the images are of solid colored objects or people
layer3-680
human annotations
- poles and beaks
- beaks, musical instruments and gun
- instruments
layer4-147
human annotations
- boxes
- parts of boxes or books
- books, snake, case, wine, apple
layer4-1297
human annotations
- animals and stop lights
- dark objects
- birds
layer4-931
human annotations
- animals and office supplies
- metal objects and instruments
- guitars, bandages, limbs, and wings
layer2-321
human annotations
- sunglasses, cloth
- blue dots and snakes
- areas that contains blue
layer1-208
human annotations
- spots of the color white bordering animals
- a bird on a stump, a whale with letter's underneath it
- some of the left edges of things
layer3-501
human annotations
- collars of shirts
- necks of humans
- the bottom half of faces
layer3-626
human annotations
- spots of gray backgrounds
- area between legs or poles in the background
- pale areas of background
layer4-774
human annotations
- electronics, signs and animals
- surfaces with text or texture
- digital clocks
layer4-1967
human annotations
- animals and railings
- shaggy dogs
- animal, person
layer1-144
human annotations
- animals outside
- outlines of animals and flowers
- parts of outlines of objects
layer2-221
human annotations
- fur, hair, exterior of cars and trucks, part of a guitar, food, parts of speaker exterior
- pale spots on object
- vehicles
layer3-167
human annotations
- dog mouths and keyboards
- dog mouths
- canine mouth areas
layer4-342
human annotations
- animals, musical instruments and curved objects
- arched objects
- instrument, toaster, logo, road, cups
layer4-1016
human annotations
- circles with curved edges and gaps
- shoes, oven mitts, shovel, plate
- curved objects
layer4-1537
human annotations
- dogs
- dogs, hourglass and bottles
- areas with straight lines
layer3-234
human annotations
- wheels and tires. also animal faces
- wheels of a tractor
- pale or sunlit areas
layer3-150
human annotations
- animal hair
- dogs
- fur and hair
layer3-526
human annotations
- tan areas
- faces
- human body parts and diffident regions of objects
layer4-862
human annotations
- a cheetah, a old iron, boldtsand washers, meerkat, a dog, a monkey
- animals, tools and wooden objects
- objects with lines in them
layer4-1260
human annotations
- textured surfaces
- rocks that are up against the coast in the ocean
- rocks in pictures
layer4-1817
human annotations
- a shirtless man pushing a lawnmower, a mannequin wearing a skirt, a woman wearing a skirt, a bird on a roof
- items that are connected
- similar color patterns
layer3-351
human annotations
- noses of dogs and necks of birds
- the areas with a darker bottom half
- splitting from one color to the next
layer4-315
human annotations
- animals
- arms and legs, and objects that resemble them
- arms of animals and humans
layer4-1347
human annotations
- white objects
- vehicles, circular objects and animals
- green grass and white bowls
layer2-446
human annotations
- wings of a plane
- bugs
- contain orange-red parts
layer3-401
human annotations
- fur and single colored backgrounds
- orange objects and dogs
- similar colors
layer3-685
human annotations
- dots
- round features on objects
- circular objects
layer3-911
human annotations
- walls and lamps
- green walls
- carriage, grass, animal
layer4-1066
human annotations
- cup or a glass
- trees, cups and cylindrical objects
- alcoholic drinks
layer4-1443
human annotations
- vehicles, jewels, flowers and firearms
- red trucks
- jewelry, person, gun, car
layer1-24
human annotations
- spots of the color white
- a dog on a sofa, a frog
- animal legs
layer3-25
human annotations
- necks of different dogs
- smooth long surfaces of living objects
- light brown color
layer2-259
human annotations
- dots or birds, flags and animals
- black dots in them
- areas of cracks and creases
layer4-787
human annotations
- people holding things
- canes
- angles
layer4-967
human annotations
- holes on objects and people wearing diffrent kinds of glasses
- animals, bones and spikes
- eyes and horn like things sticking up
layer4-1753
human annotations
- wooden plank with a bird on top, women on doing acrobats, left side of boy
- wooden furniture
- two things that are connected
layer1-20
human annotations
- a sharks teeth, a couple divers
- striped with black
- animal, water, logo, text
layer3-394
human annotations
- space surrounding the text of a sign, ancient symbols on a wall, space above a gun someone is holding, a butterfly, baking designs, objects in a display case
- yellow lettering
- yellow areas in pictures
layer3-602
human annotations
- mug handles and a swan
- handles on mugs
- handles of various objects
layer4-279
human annotations
- roads
- small animals and roads
- asphalt
layer4-1284
human annotations
- animals
- black bugs
- bugs and dogs and horses
layer4-1442
human annotations
- dog, bird, pet
- white dogs
- animal, insect
layer4-1916
human annotations
- person holding a bug, person playing a sport on the lawn
- textured surface
- items on surfaces
layer3-983
human annotations
- fur and feathers on animals
- dog tails
- similar patterns
layer3-366
human annotations
- beaks and wind instruments
- animal noses
- mouths of different animals, humans and tools
layer3-944
human annotations
- curving and swirling lines
- noodle shaped objects
- noodle dishes
layer4-439
human annotations
- bottles
- water bottles
- bottles
layer4-1675
human annotations
- pet, man holding balon, lizard, electronic equipment
- dogs and things with holes
- circular items
layer4-1986
human annotations
- a mouse in a cup, a camera, microphone
- animals and circular objects
- dark-colored objects which are longer than they are wide
layer3-986
human annotations
- long haired dogs
- many "tassel" type objects
- string like things
layer3-339
human annotations
- objects surrounded by a single colored background
- hazy
- hands and things you hold
layer4-325
human annotations
- animals and bottles
- hands of humans
- rounded edges in pictures
layer3-725
human annotations
- circular objects and animals
- exteriors of various products and animals
- helmet, rim, respirator, insect, car, sky
layer4-1791
human annotations
- fruit, dog kneeling, dog lying down, chicken walking in a field, lettuce, microwave door
- vehicles, animals and shiny objects
- areas that are curved
layer4-742
human annotations
- stone objects and walk ways
- animals, wheels, and fields
- brown dogs
layer2-464
human annotations
- the feathers of a bird, back of a window, mouth and left side of a pin of a shark, headlight of a car
- birds
- the edges of points
layer3-481
human annotations
- arms and cylindrical objects
- red tips of objects
- things that are long
layer3-873
human annotations
- spots of the color white
- circular objects
- round household objects
layer4-533
human annotations
- windmill farm in the background of a field, food on a tray, a tablet
- green objects and stones
- green objects
layer4-734
human annotations
- red objects and handles
- furniture and cylinders
- fruit, mug, electronic, gas pump
layer4-1488
human annotations
- bread in a pan, food in a mixing pot, boat, turtle in water
- cups, containers and roads
- bins or bugs
layer1-177
human annotations
- a sleeping bag on the ground, heads of two people sailing
- the people on the water skis and the airplanes all look as if they are flying
- head of the people
layer3-489
human annotations
- cartoon faces and repeating circles
- small red designs
- rounded edges in pictures
layer4-826
human annotations
- animals and cords
- long and thin objects
- string like things
layer4-635
human annotations
- boats and objects with edges
- boats, trees, furniture, hats and boxes
- the bottom of boats
layer4-1541
human annotations
- bed, chair
- items with folds
- brighter areas on objects
layer4-1655
human annotations
- ducks on a pond, a mower, a dog
- animals and circular objects
- animals, lawn mower
layer3-218
human annotations
- a dog is chewing on a bone, a down with pasta
- brown walls and food
- sky, wall, vegetable
layer3-181
human annotations
- animals walking outside
- animal heads and horns
- animal
layer4-74
human annotations
- tapered objects
- feet
- spoon or spatula shaped objects
layer3-125
human annotations
- plaid and rounded objects
- bedspreads
- similar patterns
layer4-625
human annotations
- white and red objects
- rectangular object
- rounded edges in pictures
layer4-886
human annotations
- circular objects and speakers
- items with rounded edges
- square objects
layer4-1874
human annotations
- person sitting in a straight jacket in a chair, people in a canoe, people walking down to a building
- wheels and dark, thin objects
- areas that are curved
layer3-375
human annotations
- mittens and borders of curved objects
- pairs of mittens
- gaps of objects
layer2-216
human annotations
- pointy ends of appendages, objects, and structures
- beaks of birds and ears of animals
- dots on sticks, corners and peaks
layer4-258
human annotations
- animals and objects that resemble them
- brown dogs
- animals
layer4-440
human annotations
- animals and circular objects
- central objects
- rounded edges in pictures
layer4-1568
human annotations
- animals, instruments, furniture and toys
- areas with red and brown hues
- red objects
layer4-1751
human annotations
- combination lock on a safe, pot for plants, boy with his phone, teddy bear, food on a plate
- objects with lines, patterns or texture
- items with circular features
layer1-84
human annotations
- a kid with a snake around neck upper left of photo
- aquatic life and the ocean
- blue green color
layer1-180
human annotations
- no highlight
- a pink background
- purple areas
layer4-101
human annotations
- baskets and rails
- animal cages
- long vertical bars in a row
layer4-129
human annotations
- laptops and computers
- electronics and animals
- laptops and dogs
layer4-1384
human annotations
- animals, poles, and pens
- brown objects
- animals, people
layer4-999
human annotations
- metal items and animals
- black objects
- a round tube shape connected to rectangular base
layer2-315
human annotations
- a beer bottle
- red shirts and balls
- yellow, red or blue spots
layer3-392
human annotations
- aquatic life, a kid taking a sip from a cup, island moutain region, computer speakers, birds perching on a branch
- bird wings
- depict the color white or shades similiar
layer3-531
human annotations
- animal noses and beaks
- heads of birds
- noses, beaks or parts of feet
layer3-895
human annotations
- square items
- areas containing lines and text
- buttons and watches
layer4-1183
human annotations
- water and sky
- shaggy dogs
- horizontal line
layer4-1767
human annotations
- a person diving, a man vacuuming, a fly on a tennis ball, a women with a brush
- animals and vehicles
- living things
layer3-286
human annotations
- dots
- small black dots
- spotted areas in pictures
layer1-135
human annotations
- outlines of bows, trains and other diagonal or curved lines
- mugs and animals
- specific patterns
layer4-120
human annotations
- a bottle of water flying through the air, a shoulder of a women, a hat someone is holding, flag on a parachute, a trash bin outside
- people bottles and parachutes
- rounded and cylindrical objects
layer4-394
human annotations
- rounded objects and heads
- hats
- part of round items
layer4-939
human annotations
- spiders, arms and circular objects
- rounded objects
- dog faces or circles
layer4-1557
human annotations
- dogs and clothes
- fur and textures resembling it
- brown dogs
layer4-386
human annotations
- animals
- sea crabs
- animal, person
layer4-793
human annotations
- corners
- lined objects
- similar patterns
layer4-1323
human annotations
- dog, water on a lake
- animals
- long and lean animals
layer4-1760
human annotations
- insects, women standing in front of a giant shar, dog with mop hair
- green objects
- green objects in nature
layer2-495
human annotations
- the color green and the other repeating lines and holes
- the backgrounds or shiny areas of objects
- dogs
layer3-412
human annotations
- contrasting color patterns
- segmented or multiple objects
- yellow and red objects
layer1-168
human annotations
- a women and her giant dog
- birds and dogs
- parts of objects
layer3-368
human annotations
- the eraser, spaces round text, birds sit atop a tree, a dog laying down
- birds, water bottles and objects with letters or buttons
- horizontal lines and birds
layer3-790
human annotations
- fire and lit objects
- candles
- an object which contains fire in it
layer4-244
human annotations
- animals, furniture and vehicles
- textured areas
- things that sick out
layer4-1351
human annotations
- animals, stone structures and water towers
- objects with curves
- animal, rock, person
layer4-1635
human annotations
- feathers of a pen, kid's face, clouds, bus
- canopies, domes and birds
- blue skies and parachutes
layer3-631
human annotations
- objects surrounded by foliage
- animals in the woods
- plants and background scenery
layer4-373
human annotations
- edges of objects and corners
- appliances, poles and cups
- rounded edges
layer4-1345
human annotations
- animals, lights and fire
- sources of light and flame
- person, food, vehicle, nature
layer4-908
human annotations
- animals with fur
- animals and circular objects
- human hands
layer2-439
human annotations
- spots of orange and green
- colorful lighting
- these include areas with smudged color
layer2-462
human annotations
- a printer
- red patterned objects
- specific patterns
layer2-337
human annotations
- a mophead, a dogs muzzle, fur of a dog
- stripes and cheeks
- animal, person, food
layer2-219
human annotations
- spots of pale colors
- parts of animals and backgrounds
- brighter areas in objects
layer3-532
human annotations
- bodies of animals
- animals balls and furniture
- parts of things
layer4-343
human annotations
- animals and plaques
- include sides of items
- lighter areas
layer4-1186
human annotations
- fabric and animals
- people and some animals
- the sides of objects
layer4-1894
human annotations
- helmets, balls, and birds
- have rounded features
- faces of animals
layer2-339
human annotations
layer3-75
human annotations
- wooden and steel arches
- diagonal lines
- rounded edges in pictures
layer4-26
human annotations
- faces of people and armadillos and porcupines
- shaped like a hat
- rounded edges in pictures
layer4-569
human annotations
- green plants
- green plants
- green areas in picture
layer4-695
human annotations
- a lizard on the rocks a a snake on the rocks, flower blooming, a bird on a log, snake moving, a train, a heater
- animals, pipes and stems
- green objects
layer4-1928
human annotations
- measuring cup, to with a ver, radio, a firetruck, monkey
- vehicles. animals and metal objects
- designs
layer1-106
human annotations
- spots on a zebra, a speedometer
- black and white lines
- tiny pieces of objects
layer3-652
human annotations
- eyes
- eyes of different animals
- eyes of animals
layer4-218
human annotations
- animals and circular objects
- round objects
- statue, wheel, dog, flower, animal, bottle caps
layer4-1277
human annotations
- animals and shoes
- animal faces and objects that may resemble them
- shaggy dogs
layer4-1412
human annotations
- a elephant's trunk, a lizard, the back of a tire, a dog's fur, birds on a branch, a snake by a jar, tires of a 4 wheeler
- textured items
- person, nature
layer2-296
human annotations
- animals
- animals and green grass
- around animals
conv1-8
human annotations
- dog
- red balls
- white background
layer3-478
human annotations
- they show empty black space and shadowing
- color gradient in them
- heads of things
layer2-200
human annotations
- helmets and hats that people are wearing
- blanket, mop, vehicle, animal
- orange areas in picture
layer4-567
human annotations
- a helicopter in the sky, a drum set, a chain link fence, a semi truck
- people, furniture, helicopters and circular objects
- items that are curved
layer4-1165
human annotations
- animals and circles
- round objects
- rounded edges in pictures
layer4-1503
human annotations
- birds and animals
- a bird on the beach, a dog next to a kid, crutches on the sand, a dog on the grass
- show two items that are connected
layer4-1686
human annotations
- food items on a shelf
- areas with red hues
- red features
layer3-402
human annotations
- chests of different brown dogs
- shows front of dogs, bottles and trucks
- front of objects
layer3-496
human annotations
- deserts, masks, and circular objects
- parfait desserts
- rounded
layer4-782
human annotations
- fields, the beach, and the sky
- ground and sky backgrounds
- animal legs
layer4-769
human annotations
- circles
- circular objects
- rounded edges in pictures
layer4-1626
human annotations
- tapered objects
- red objects
- two items that are connected
layer4-1893
human annotations
- objects that stick out
- items that are connected
- things outside
layer1-163
human annotations
- space above a gorilla
- items with branches
- brighter areas in objects
layer2-358
human annotations
- they show grated/patterns in objects
- blue areas in pictures
- birds drink a water
layer3-784
human annotations
- animal eyes and wooded fences
- eyes of dogs
- fences or walls and eyes of canines
layer3-129
human annotations
- parts within an object
- textured features on animals and objects
- textured regions
layer4-824
human annotations
- hairy objects, red objects, green hues, concrete and worms
- animals, the sky and the road
- rounded edges in pictures
layer4-894
human annotations
- animals and eyes
- textured objects
- brown dogs
layer4-1939
human annotations
- text of a memorial, a bird in the grass, a man in the water
- fur and textured areas
- living things
layer2-458
human annotations
- spots of the color white
- aquatic life, pier support, graphic on a billboard, musicians on stage, space above thetop of trees
- uneven, black areas at the bottom
layer1-45
human annotations
- natural creature colors
- spots of the color white and red spots
- dogs and birds
layer3-843
human annotations
- the rim of a tire, a corner of a building, feathers of a bird
- white objects
- heads and necks of birds
layer4-61
human annotations
- clocks
- a clock like item
- rounded edges in pictures
layer4-1278
human annotations
- animals, flowers and bottles
- baby faces
- babies and some people and animals
layer4-528
human annotations
- dogs, furniture, cookware and perfume
- brown objects
- furniture
layer1-111
human annotations
- animals in a parade, a dog ignores a soccer ball and table, clothing, an inject
- the color blue
- blue areas in pictures
layer3-800
human annotations
- poles and guitar necks
- guitars
- music instrument
layer4-1972
human annotations
- birds, tools and weights
- shovels
- animals
layer3-221
human annotations
- a person eating an apple
- parts of green areas
- people, food, grass, animal
layer2-148
human annotations
- colorful fabric
- colorful spots in images that are red, blue or tan
- edges of objects
layer3-148
human annotations
- blue objects
- purple flowers and dogs
- light blue objects
layer4-393
human annotations
- the sky, shirts or striped socks
- mountain ranges
- contain areas with straight lines
layer4-602
human annotations
- backgrounds
- background behind object
- green grass
layer4-1505
human annotations
- beach, person sitting in the grass, person sitting at a building
- people, trucks and bottles
- living things
layer1-98
human annotations
- animals with sharp spikes
- mostly about animals and food
- face of animal
layer3-502
human annotations
- the sky above an image
- african animals
- above animals
layer4-368
human annotations
- animals and things with holes
- brown dogs
- those show prominent eye objects or rounded things
layer4-473
human annotations
- animals, clothes and grass
- brown animals
- curved items in them
layer4-1553
human annotations
- monkey on a tree, toilet, car
- rounded features
- rounded edges in pictures
layer3-274
human annotations
- a hockey player, a dog sets a top a table or ride, a person rides a bike, a group of musicians play an instrument, intricate designs of a chair, a mini alligator walks across the grass
- things that look like crosses or animal skins
- animal noses and red decorations
layer3-1015
human annotations
- hats and the tops of vases
- animal, hat, bird feeder, measuring cup
- rounded edges in pictures
layer3-670
human annotations
- orange objects
- on the sides of objects
- orange areas in picture
layer4-1258
human annotations
- objects in front of grass
- dog walking, a bird on a blade of grass, a tie someone is wearing
- legs or ears
layer4-1376
human annotations
- produce, circular objects and rails
- small green balls
- electronic, animal, food
layer4-1539
human annotations
- girl
- areas below items
- backgrounds in pictures
layer2-380
human annotations
- text and the color yellow
- animals and yellow objects
- writing in them or color changes
layer3-307
human annotations
- train going down a track, a bird taking off, a bird taking off, a mushroom
- the sky or bird feather
- the middle of items
layer4-91
human annotations
- building materials
- walls or arches
- concrete structures and people sitting outside
layer4-374
human annotations
- a fake moustache, a bird in the trees, a bug someone is holding, a welcome mat, trees int eh distance,toilet paper
- people holding things and signs
- black animals
layer4-1241
human annotations
- faces and objects that may resemble them
- brown dogs
- rounded edges in pictures
layer4-1394
human annotations
- rock cliff, shirt a person is wearing
- food, the ground and flower buds
- articles of clothing
layer1-137
human annotations
- a sailboat
- things that have pink and purple in them
- the colors purple, pink, and blue
layer2-230
human annotations
- screws
- bands like i screw
- screws, horns, bridge, brain
layer3-535
human annotations
- insects and shells
- bugs
- main body or shell
layer4-559
human annotations
- animals and trees
- plants and furry texture
- the regions contain objects that have multiple items on them that are sticking out
layer4-1187
human annotations
- people, furniture and water
- chairs and skirts
- things with legs
layer4-1933
human annotations
- people and tools and animals
- two items that are connected
- rounded edges in pictures
layer1-25
human annotations
- red spots and objects
- these include red colors
- the pieces are long and horizontal
layer2-251
human annotations
- the color orange
- red areas on animals and bugs
- orange areas in picture
layer4-161
human annotations
- blue objects and birds
- blue jeans
- long, thin features in them
layer4-564
human annotations
- boats, bugs and shoes
- boats
- things that have to do with water
layer4-998
human annotations
- people, roads and animals
- roads
- areas worry a block design
layer4-1813
human annotations
- tennis ball, dog
- balls
- rounded items
layer4-1929
human annotations
- objects with brown or red hues
- items that are similar to one another
- rounded edges in pictures
layer1-4
human annotations
- a guitar, animal
- orange objects including snakes and vehicles
- orange tint scenery
layer3-467
human annotations
- parts of human and animal faces
- books and teeth
- vertical lines
layer3-780
human annotations
- columns, sails and legs
- long thin objects
- nature, building, person, tower
layer4-980
human annotations
- brown dogs
- insect, bottle, needle
- pictures of animal
layer4-1273
human annotations
- circle arch shape on different animals and objects
- birds and circular objects
- curved objects
layer4-1816
human annotations
- two woman on either side of a pole, a bird on a pole, right side of a fish, space on the left arm, a duck on water, a man on a boat, a polar bear, a dog on the grass
- animals, as well as some people
- things outside
layer4-1863
human annotations
- a ferret, a bird in the ocean, a monkey, a microphone
- animals and metal objects
- items that are connected
layer4-1450
human annotations
- animals and remotes
- the regions have two items that are connected
- insect, animal, person
layer2-113
human annotations
- white horizontal lines
- airplanes
- lighter areas
layer2-63
human annotations
- black gaps surrounded by white
- spots where color change occurs
- edges of objects
layer4-264
human annotations
- animals and corners of square items
- bugs and sea creatures
- the edge of rounded areas
layer4-409
human annotations
- balls for sports
- animals, balls and boats
- sports balls
layer4-1598
human annotations
- text on a bottle, cat on a rug
- books, signs, and cylinders
- items with straight features
layer1-99
human annotations
- beak of a bird, a women watching a toucan eat
- tiny spots of color
- a small area of space running up a vertical bar
layer3-439
human annotations
- crowds of people, birds, trees and leaves
- cats and dogs
- rocks and flowers that are outside
layer3-856
human annotations
- spotted feathers of birds
- bright objects and white feathers
- pleated pattern on animals
layer4-531
human annotations
- people, a dog and outdoor locations
- animals, bridges and trees
- human faces
layer4-722
human annotations
- mop, ducks on the water, harness of a dog, a dog's color, a women's hair
- animals and blue objects
- brown dogs
layer4-1674
human annotations
- dog, a statue on the roof, animal in a tree
- animals
- living things
conv1-29
human annotations
- tops of chairs, beams of steal on a structure, a few boats on the water, window seal shades
- horizontal white lines
- bright reflections
layer3-301
human annotations
- mountains
- neck braces and mountains
- lighter areas
layer4-7
human annotations
- animals and birds
- shaggy dogs
- similar patterns
layer3-832
human annotations
- reflective objects
- tops of vehicles
- sloped or rounded
layer4-767
human annotations
- the sky in the back of an image
- statues and mountains
- piles of plants or legs
layer4-665
human annotations
- animals and people
- animals, poles and electronics
- snakes
layer4-1792
human annotations
- tan objects that are rounded with areas of light and dark
- animals and circular objects
- items that are connected
layer3-216
human annotations
- birds mouth above sky
- beaks, mudguards on cars, handle
- car, bridge, person, guitar
layer2-383
human annotations
- shoes on a rack
- blue object
- colorful patterns
layer4-157
human annotations
- animals and trees
- fabric and fur textured areas
- brown animals
layer3-801
human annotations
- orange items
- objects with orange curvatures
- eyes, balls, food
layer4-655
human annotations
- animals and circular objects
- round concave objects
- similar color
layer4-1008
human annotations
- wooden objects and drawers
- roller, toaster, tractor
- red, green and black objects
layer3-358
human annotations
- pictures on a wall, text or graphic on these of a wall or object
- pale areas surrounding objects and text
- labels on objects
layer3-251
human annotations
- words and mazes
- signage
- words and patterns
layer3-933
human annotations
- textured background
- edges of slanted rooftops
- nature
layer3-776
human annotations
- animals and white objects
- screens of devices and rabbits
- parts of white things
layer4-1424
human annotations
- curved objects, including necks of animals including birds and snakes, tails of animals, a firehouse, and curved parts of objects like flowerpots
- elongated items in them
- curved items
layer4-873
human annotations
- bird on the beach, a fish in thewater, a geese, a toaster, a bird on someone's hand, a dog, a syringe
- animals, syringes and appliances
- object with several parts
layer1-39
human annotations
- border of spotted regions
- dotted patterns on clothing
- lines and polka dots
layer3-43
human annotations
- doors of vehicles and cameras
- wheels of vehicles
- brighter areas in objects
layer2-279
human annotations
- corners of photos
- african animals
- animal, food, nature, sky
layer4-456
human annotations
- tables, benches and wooden objects.
- rectangular objects
- wooden objects and puzzles
layer4-1206
human annotations
- animals, plaques and trees
- brown animals
- the sides of objects
layer4-1430
human annotations
- areas that contain rectangles
- green pastures
- nature, people
layer4-1878
human annotations
- tents and household objects
- tan objects
- areas that have items with straight features
layer3-260
human annotations
- a puppy's ears
- birds and dogs
- the bottles, animals and vehicles all have a side
layer1-58
human annotations
- spots of the color white
- a guitar pick in some strings, a my player
- white dots outlining a object
layer3-650
human annotations
- writing, pictures and patterns
- rounded objects and faces
- designs
layer4-82
human annotations
- everything ends in a corner
- the ground and umbrellas
- rounded edges in pictures
layer4-736
human annotations
- a dog laying by a tree, a bird on a nest, a person looking down in the water with hand, tower with bells, left and right side of a basket, a basket full of turtles
- animals and circular objects
- black dogs
layer4-1271
human annotations
- objects and animals with curved lines
- animals, food, boats and small white objects
- snakes and other animals
layer2-345
human annotations
- dots on the bottom of curves
- numbers
- random, small, solid colors
layer3-432
human annotations
- grass and wooden fences
- wooden fencing
- horizontal lines
layer3-775
human annotations
- does and castles
- dogs
- animal, castle, building
layer4-523
human annotations
- centipedes and dogs
- animals and circles
- shaggy brown dogs
layer4-1268
human annotations
- window, lighter, people
- orange and red lighting
- light sources
layer4-1776
human annotations
- things that look like poles
- items with straight features
- water tower, sign, peron
layer1-123
human annotations
- sharks
- only darkness
- nothing
layer3-400
human annotations
- dog tails and ears
- triangular features
- pointed objects
layer4-212
human annotations
- reflections on a bright surface
- gray objects
- slanted rooftops
layer4-273
human annotations
- straight diagonal lines
- people and fences
- parachutes
layer4-1080
human annotations
- bird, dog on the lawn, deer, meerkat
- animal and wheels
- person, nature
layer4-1504
human annotations
- animals pulling an object
- the sides of objects
- pictures of animal
layer3-553
human annotations
- animal stomachs
- the under bodies of animals
- chests of animals
layer3-1018
human annotations
- faces, wheels and towers
- right side of face
- eyes and holes
layer4-623
human annotations
- animals, planes, and produce
- airplanes
- flags, tree roots, white space, fruits, shower curtains, and lamps
layer4-647
human annotations
- water and helmets
- water
- rounded edges in pictures
layer2-368
human annotations
- space on the front of a musician's shirt
- colorful splotches outlining a object
- colors
layer2-320
human annotations
- a snake around a kid's head
- dots outlining a object
- face of the people
layer2-283
human annotations
- person's head
- green grass and faces
- green grass
layer3-1022
human annotations
- the sky or walls
- bands above objects
- above objects
layer3-427
human annotations
- the patterns on snake bodies
- the patterns are very brightly colored and repetitive
- similar patterns on snakes
layer4-555
human annotations
- trucks,, animals, and buildings
- this region has areas with straight lines
- rounded edges in pictures
layer4-316
human annotations
- bugs and eggs
- stone walls and food
- similar patterns
layer4-1772
human annotations
- women's face, dog, knife's sheath, turtle
- fronts
- animal, nature, food
layer4-1659
human annotations
- a group of people in dresses, a crane, a dog
- animals, poles and vehicles
- items with straight features
layer3-321
human annotations
- dog heads and other parts of animals
- dogs mouths
- parts of mammals
layer2-229
human annotations
- diagonal lines
- aquatic life and other animals
- two lines in them
layer4-214
human annotations
- animals and gray objects
- whales
- items that cross other items
layer4-558
human annotations
- animals, flowers and walls
- flowers and dogs
- items on top of other items
layer4-1565
human annotations
- a lighthouse, a dog on the grass, a person at the swimming pool
- animals and things shaped like squash
- a triangular shape
layer4-1930
human annotations
- colorful objects that are yellow or blue and long tubes
- extensions
- brighter areas on objects
layer2-331
human annotations
- the front side of a fire truck
- multicolored rounded objects
- puffy rounded textures like quilting
conv1-44
human annotations
- stripes of a zebra, a spiderweb, a coffeepot, a cassette tape
- white dots outlining a object
- black and white stripes
layer3-69
human annotations
- corners of objects and edges of items
- area where object size changes
- can opener, animal, truck, electronic
layer4-1
human annotations
- people walking in snow
- pumpkins, shacks and walls
- wooden poles
layer4-563
human annotations
- computer
- hinges of objects
- contain squared areas
layer4-652
human annotations
- dogs having fun, a top of a tower, a bird on grass, means of transport, a old telephone
- dog faces
- either red/brown/white inanimate objects or white animals
layer4-1738
human annotations
- a flag with a parachute on it, a baby sitting on the carpet, a person with socks
- areas with red or brown hues
- items on other items
layer2-350
human annotations
- dots over corners and circles
- small white holes
- the edge of black items
layer2-210
human annotations
- white outlines
- white and black lettering
- spotted areas in pictures
layer2-269
human annotations
- spots of bright colors and white
- outlines of vehicles and animals
- red and yellow objects
layer3-752
human annotations
- balls, animals and dots
- round objects
- round objects
layer4-526
human annotations
- benches, fences and floors
- rows and slats
- siding and fencing
layer4-1812
human annotations
- dogs, fences, skies, and water
- background of an image, text and various animals
- pictures of animal
layer4-1844
human annotations
- shelf, bird
- shelves and people and walls
- the sides of objects
layer1-43
human annotations
- a whale in the water, a guitar picker
- white lines next to things
- sign, water, window
layer1-207
human annotations
- spots of the color white
- a person runs along a beach, a fruit tree, a cup of coffee, a clock with numbers, a guitar pick in strings
- parts of white areas next to edges
layer4-155
human annotations
- water and and sky
- towers
- silo shaped
layer3-634
human annotations
- a boy holding an axe, left and right side of a man in mesh armor, stuffed animals mouth, fox's ears
- white areas on animals, handles and the background
- white light
layer4-632
human annotations
- lines and textured objects
- keyboards
- the images presented are all of different objects but all/most contain lines of some sort
layer4-1036
human annotations
- animals, vehicles and shiny objects
- vehicles
- on the sides of objects
layer4-1978
human annotations
- animals and black holes
- musical instruments
- fronts
layer3-272
human annotations
- animal fur
- a monkey, a animal outside
- black hair
layer2-145
human annotations
- round ceilings
- glass windows that are between metal frames
- the area within bordered shapes
layer4-229
human annotations
- striped objects
- line patterns
- bridges and fences
layer4-775
human annotations
- animals, screens and water
- various textures
- snow and blue skies
layer4-1053
human annotations
- animals and planes
- textured surfaces
- brown dogs
layer4-1179
human annotations
- poles, cables and sticks
- vertical skinny poles
- stringed objects
layer4-1999
human annotations
- animals, wheels and musical instruments
- aquatic life
- person, nature
layer4-1698
human annotations
- keys, furniture and stars
- made of blocks or have a star like shape
- numbers and clocks and fish
layer2-333
human annotations
- keys on a keyboard
- the middle areas of jars, buttons and other objects
- little shapes in them
layer2-80
human annotations
- taels of the cap a person graduating is wearing, a cap of a kid they are wearing, a bookshelf, a a duck on the porch
- striped pattern on objects
- blue areas in pictures
layer4-2
human annotations
- animals and frosting
- black creatures in the hand
- small bugs and small animals
layer3-639
human annotations
- cellphones and keyboards
- electronics
- keyboards
layer1-156
human annotations
- small holes and gaps in white backgrounds
- a window on the side of a mansion, a window on these of a train
- lines and edges
conv1-46
human annotations
- people riding a golf cart, a animal with text below, a computer desk, a sign with text around it, football match
- black and white lettering
- golf cart, person, animal, label
layer3-771
human annotations
- brown food and signs
- tiny balls or a texture that is similar
- orange areas in picture
layer3-484
human annotations
- animal noses and beaks
- noses of different animals
- animal
layer4-536
human annotations
- insects and pointy tips of objects
- animals and lights
- bugs
layer4-656
human annotations
- produce and fabric
- fabric and textured surfaces
- red scarves
layer4-1742
human annotations
- the heads of animals, including dogs, birds, a squirrel, and a deer
- animals
- items on surfaces
layer3-190
human annotations
- feet on a dog
- the legs of animals
- legs and hands
layer2-143
human annotations
- curvy lines and their borders
- spots that contain the color red or brown
- circular objects and striped clothing
layer4-587
human annotations
- white balls and the fur of animals
- animals, flowers and bowls
- fur, feathers and flowers
layer4-877
human annotations
- legs and feet of animals
- animals
- brown dogs
layer4-1587
human annotations
- barons in the sky, dog, cabinet with trees
- animals, balloons and cabinets
- animal, person
layer1-61
human annotations
- ship out in the water
- yellow buildings and lights
- yellow areas
layer2-367
human annotations
- web of a plant, fish on the ground, cap of a bottle, aquatic life, a old car
- edges on round objects
- netting, logo, car
layer3-596
human annotations
- furniture, pots and vehicles
- chairs
- shiny parts of objects
layer3-517
human annotations
- stairs and wood work
- fencing and similar shapes
- fencing
layer4-1344
human annotations
- a light switch, a cabinet, a mouse, a diver
- animals, switches and furniture
- fluffy dogs and light switches
layer4-701
human annotations
- animals, clothes and humps
- human hands
- items that are rounded
layer3-242
human annotations
- bowls stacked on a table, pez dispensary's
- three-dimensional a rounded areas
- pottery, doll, person
layer2-36
human annotations
- the area where a color change occurs
- two shades of color connecting in spots
- strings and lines
layer4-46
human annotations
- brown colored things and animal faces
- boxes, fences and animals
- dogs
layer4-366
human annotations
- animals, people and shoes
- human and animal faces and objects that resemble them
- dog muzzles
layer4-868
human annotations
- a fire burning on the ground, cups of fruit on a rack ,three corners of bread, a flag on a parachute. food
- red objects
- red objects
layer2-400
human annotations
- letter's on a plane
- these were made up of small black striped lines
- logo, fencing, bench
layer4-221
human annotations
- water and kitchens
- fountains and water
- splashes of water
layer3-577
human annotations
- words, furs, and feathers
- signage
- similar patterns
layer4-997
human annotations
- a goat in the distance, a chair bird, vase, fruit
- animals
- items with straight features
layer4-912
human annotations
- birds and small animals
- a crab, a possum, a dog, a animal on a branch
- brown and black animals
conv1-25
human annotations
- toilet paper, a man holding a fish
- nothing
- round objects
layer2-282
human annotations
- flowers in a pathway
- white structures
- green colours of flower
layer3-138
human annotations
- diagonal lines
- the things at 90 degree angles
- similar patterns
layer3-510
human annotations
- dog faces
- dog noses
- the faces of dogs
layer4-672
human annotations
- a person holding a camera, a kid wearing sunglasses, a object in the water, an eraser, a stop light turning red
- people, electronics and stop lights
- people holding objects
layer4-502
human annotations
- animals and vehicles
- brown animals
- the area under an object
layer4-1528
human annotations
- snake, a bracelet on a table, eggs in a cage.
- animals, cords, tents and balls
- animals
layer4-1934
human annotations
- animals and the water
- brown areas
- items that are connected
layer2-393
human annotations
- blue areas on everyday objects or the sky
- spots of blue
- person, bottle, logo, sign
layer3-32
human annotations
- area above a tire of a car
- the fenders of a car or truck
- rounded edges in pictures
layer4-56
human annotations
- trees and bedroom furniture
- the tops of objects
- backgrounds in pictures
layer3-708
human annotations
- necks of people
- people and cars
- contain the area around central objects
layer4-703
human annotations
- a person preparing food, a military base
- cookware, fruit and a boat
- food
layer4-1780
human annotations
- crib someone has, ship, swing
- a boat like object
- items with straight features
layer1-46
human annotations
- seaworthy blues
- fish in a pond, a dog in competition
- brighter areas in objects
layer2-79
human annotations
- letters, cords and keys
- pale spots around text or patterns
- fencing, keyboard, food, person
layer4-54
human annotations
- water and sky
- animals in the water
- objects or animals in the water
layer4-606
human annotations
- a bald kit sitting down posing for a photo, aman using a chain saw to cut something, a man cleaning a elephant, aman cooking
- human arms
- the limbs of various living creatures
layer4-1035
human annotations
- elephant on the water, sunset, left and right side of room
- the regions have orange in them
- similar color patterns
layer4-2044
human annotations
- people, towers and straps
- white column shapes
- the regions show the sides of items
layer2-166
human annotations
- blue and red objects as edges
- peacock feathers
- phone booth, drawing, table, grass
layer2-66
human annotations
- the color red and little spots on objects
- these images all share small checker/square patterns
- specific patterns
layer4-612
human annotations
- butterflies and objects in forests
- animals. rock like things and animals
- flies
layer4-328
human annotations
- objects with straight lines and tips
- vehicles and appliances
- wooden brown objects
layer4-1616
human annotations
- object with lines
- animal, nature
- pictures of animal
layer4-1106
human annotations
- balls and signs
- balls
- dogs and balls
layer2-226
human annotations
- lines that create boundaries on backgrounds
- separate color areas
- the photograph represent fiber and texture within an object
layer4-131
human annotations
- round items that are part of a cylinder
- striped objects and masks
- animal, mask, bell, socks, jet, tent
layer4-487
human annotations
- plaques
- objects with lines or texture
- similar patterns
layer4-941
human annotations
- a bird in the water, a spider in the sand, a duck, a dog staring at a keyboard
- brown birds
- woven textures, birds, frogs, spiders, and square geometry
layer4-1885
human annotations
- round objects
- items on other items
- rounded edges in pictures
layer3-188
human annotations
- objects with logos and black lettering
- icon like symbols on objects
- logo
layer2-466
human annotations
- a dog scarf, cars paint, add, sky musician
- fluorescent pink objects
- the colors blue purple and pink
layer3-44
human annotations
- balls, eyes and fluorescent colored objects
- rounded or glowing areas
- brighter areas in objects
layer3-428
human annotations
- mouth of people playing instruments
- human mouths
- peoples mouths
layer4-457
human annotations
- animals, sticks, cups and stoves
- protruding objects and appendages
- birds
layer4-313
human annotations
- faces of people and animals
- animals
- faces of black and white dogs
layer4-1987
human annotations
- text and animals wearing accesories
- long, thin objects
- skinny poles
layer4-1636
human annotations
- frog in the water, rock, chicken, child, chair
- animal
- rounded edges in pictures
layer2-386
human annotations
- yellow and red areas
- the color blue
- bright area on object
layer2-424
human annotations
- jackets
- thin stripes
- daily life accessories
layer4-172
human annotations
- people and domes
- bottles and rooftops
- people outside houses and activities
layer4-73
human annotations
- poles and stripes
- fingerprints
- swirled patterns like a fingerprint
layer4-946
human annotations
- the ground
- grounding
- edges of objects
layer4-1371
human annotations
- trees and objects in the sky
- poles, stocks, and sticks
- skinny poles
layer2-152
human annotations
- eyes of dogs
- pieces of fur that are on various animals
- animal, train, cat, person, ipod, logo
layer2-178
human annotations
- pale areas around text or patterns
- sharks
- rounded edges in pictures
layer4-594
human annotations
- single colored background behind objects
- animals and things with cords
- corners of objects
layer4-755
human annotations
- water
- the tails of boats
- water spraying out in an area
layer4-1637
human annotations
- bird in the sky, guitar, bird in the sky, fence
- animals, shovels, and fences
- bird, shovel, music instrument
layer4-1781
human annotations
- a syringe, a sign a dog
- poles, floors and animals
- items with straight features
layer3-53
human annotations
- tops of vehicles, bags, and boxes
- the top of a man made object
- machines and where you sit
layer3-516
human annotations
- water
- sharks
- blue areas in pictures
layer4-560
human annotations
- animals and water
- animals and people
- brown dogs
layer4-511
human annotations
- animals striped objects
- salamanders that are striped
- similar color patterns
layer4-1447
human annotations
- space on the left side of a women's face, two friends pose for a photo, man at a store
- roads and windows
- the are a rounded edge with a texture
layer1-165
human annotations
- a monkey in the distance
- nature, people, structure, letters
- animals
layer2-182
human annotations
- monkeys
- animals
- above animals
layer3-594
human annotations
- area on an object where the most light hits
- electronic device screens
- electronics, pills, animal
layer3-940
human annotations
- animals and cowls
- food
- the sides of objects
layer4-883
human annotations
- windows, tiles and blankets
- objects with grid line patterns
- tiles
layer4-1497
human annotations
- ceiling glass, athletes shorts
- windows, cases, tables and dads
- square tiles and lines
layer3-232
human annotations
- a dog's face
- the space below text
- animal, sky, screws
layer2-233
human annotations
- flower petals
- red hued areas
- red and yellow vehicles
layer3-568
human annotations
- heads of birds
- areas with a wide different color band
- beaks of birds
layer4-753
human annotations
- body parts and poles
- seatbelts and arms
- brighter areas in objects
layer4-1298
human annotations
- dog, fox
- animals
- a white stripe
layer2-125
human annotations
- spots of the color white
- a speedometer gauge, a to screen
- these include pieces of red
layer3-471
human annotations
- repeating red lines and the sky
- eyebrows of people
- show hats, flags
layer3-952
human annotations
- balls and sectioned items
- areas where corners of squares meet
- soccer balls
layer4-1185
human annotations
- animals
- elephants
- pictures of animal
layer4-1449
human annotations
- pets
- brown dogs
- items on other objects
layer4-1762
human annotations
- a puzzle, a man walking on the beach, a kid running on the sand, a kid standing, a dog, a women at a limo
- shorts of different sizes and colors
- living things
layer3-265
human annotations
- a british soldier's gun
- the bottoms of a object mostly clothes
- the space above people
layer1-221
human annotations
- strings on a guitar
- parts of edges of objects
- lines and string
layer3-798
human annotations
- shiny areas of people, furniture and animals
- birds
- person, animal, trailer
layer4-134
human annotations
- sticks, balls, and animals
- green balls
- tree branches or limbs
layer4-948
human annotations
- water bottle, kid, cat
- animals, kids and white objects
- hands of humans
layer4-1339
human annotations
- the ocean, roads, and plaques
- brown and green grass
- sign, water
layer3-249
human annotations
- shelves and repeating lines
- spirals or stacked items like a bookcase
- vertical patterns
layer2-43
human annotations
- aquatic life, a dog on a ride, speakers, space above a text, can opener, flowers on the side of a bowl
- sharks
- written text
layer4-60
human annotations
- things with handles and poles
- tapered objects
- plungers and household objects
layer3-723
human annotations
- show openings
- building, person, shovel
- arms in pictures
layer4-1329
human annotations
- a car in a drive through,a bunny, a dirt road with a bench, a person holding something, bottom of a statue
- animals, furniture, and circular objects
- fluffy white animals
layer4-1062
human annotations
- faces of animals and bandages
- objects with yellow or brown hues
- bandages
layer1-202
human annotations
- white spots
- a four poster reframe
- brown animals
layer3-536
human annotations
- hands of humans and faces of dogs
- mouths
- animal, person eating food
layer4-202
human annotations
- mouths of animals
- rocks, wheels, and feathers
- textured regions
layer4-1266
human annotations
- animals and kids
- heads and objects that resemble them
- baby faces
layer4-1545
human annotations
- animals and birds
- animals and vehicles
- brown bugs
layer4-1699
human annotations
- fins and colliding edges
- clothing objects, a whale in the ocean
- connected items
layer1-145
human annotations
- a kid eating an ice cream cone
- object with patterns
- the space above icecream
layer4-93
human annotations
- bottles, domes and fountains
- cylindrical objects
- rounded objects
layer3-701
human annotations
- electronics
- pale spots of object surfaces
- cassette tapes
layer4-1230
human annotations
- animals and rocks
- white dogs
- dogs and other animals
layer4-1068
human annotations
- insects, a dog on the grass, water around an island
- animals, mounds and food
- animals and textured surfaces
layer2-403
human annotations
- a duck laying down
- ducks
- happy enjoying the animals and birds
layer2-457
human annotations
- windows of a building that look like a giant whicker basket'
- blue and orange dots
- these images all show small specks of colours throughout
layer3-608
human annotations
- animal parts with stripes
- fluffy animals
- animal, food, person, candle
layer3-883
human annotations
- background of animal photos
- the areas underneath a animal
- fluffy animals
layer4-954
human annotations
- a dog in the sand, a star fish, a crab, a dog outside
- animals, trees and a circle
- sea creatures and dogs
layer4-899
human annotations
- animals and people
- faces and objects that resemble them
- goggles
layer2-32
human annotations
- objects surrounded by the color blue
- sign, a dog sniffing the ground, a kid about to dive, a bird on the father
- rounded edges in pictures
layer3-121
human annotations
- edges of objects
- shadows or legs
- rounded edges in pictures
layer4-384
human annotations
- jewelry and objects surrounded by the sky
- ships, cords and bows
- decorative jewlery
layer4-481
human annotations
- fur of animals and the hands of people in tables
- diagonal lines
- human hands
layer4-1990
human annotations
- a man holding a crab, a man wearing socks, a insect, a bea, a scorpion, a zebra
- animals and things with stripes
- animals, insects
layer4-1543
human annotations
- objects with diagonal lines
- sundial, joystick, bugs
- items with lines
layer4-1833
human annotations
- a iron, sand in a garden
- walls, fields, ground and backgrounds
- nature
layer2-5
human annotations
- blank spaces of uniform color
- white spaces near objects
- edges of objects
layer1-115
human annotations
- the wheels of a car, a camera lense, a couple animals, a snake
- black and white patterns
- narrow black stripes
layer4-248
human annotations
- protruding objects
- bottom clothing
- people, animal
layer4-865
human annotations
- cart someone is pulling, tractor, semi, fence
- fences, furniture and animals
- objects with horizontal lines
layer4-1969
human annotations
- bridges, fences and buildings
- areas with multiple lines
- walkways
layer1-22
human annotations
- a dog riding a ride meant for kids, a spider crawls down a wall
- dogs and bugs
- living objects
layer3-157
human annotations
- the space at the top of an image
- the sky or water
- above animals
layer3-495
human annotations
- bodies of dogs
- parts of bodies or tools, mostly
- necks of things
layer4-874
human annotations
- circular objects and animals
- objects containing red and yellow hues
- animal, nature, fruit
layer4-1169
human annotations
- keys, claws and rims
- areas containing grey or brown
- skinny brown objects
layer4-1824
human annotations
- a blimp, a bird, a satellite, an apple
- animals, grass, water and the sky
- the sides of objects
layer2-136
human annotations
- white space around black holes
- screens of electronic devices and corners
- similar patterns
layer3-806
human annotations
- animal parts
- white skin
- person, animal, hand, food
layer3-901
human annotations
- screens and windows
- electronics and eyes
- screens of devices
layer4-847
human annotations
- curved objects and backgrounds
- objects with lines
- handles
layer4-1996
human annotations
- a spider, brick characters, a dog, a old man, a
- people, animals, hands and feet
- appendages
layer2-498
human annotations
- the color red bordering blue
- red objects
- the images are filled with various vibrant colors and patterns
layer1-102
human annotations
- spots of the color white bordering objects
- aquatic life, space above dogs, a monkey, clothing or camping gear, incest
- the top outlines of animals or people
layer4-344
human annotations
- animals and metal objects
- brown animals
- cylindrical animals and objects
layer4-97
human annotations
- fabric and produce
- tarp
- beds or tent like items
layer4-2013
human annotations
- red objects
- human hands
- animals, insect, nature, person
layer4-1964
human annotations
- people and animals
- left and right side of a sign, mountain range, a bread pan
- areas with green and brown
conv1-41
human annotations
- a sweater
- multicolored dots and objects
- gauge, food, boots, white backgrounds
conv1-35
human annotations
- lines of a car
- blue and red objects
- car, spoon, bag, pillow
layer2-239
human annotations
- spots of the color white
- diagonal lines
- the ocean
layer3-479
human annotations
- animals and orange color
- fire and similarly colored objects
- smooth, flat areas
layer4-592
human annotations
- containers and circular objects
- tables and cookware
- household objects
layer4-670
human annotations
- animals and fences
- instruments and balls
- an outline of a different color
layer4-1692
human annotations
- mics, grates and dots
- items with designs
- brighter areas on objects
layer2-291
human annotations
- a parrot sits atop a stoop, two people wrestle for a ball
- heads of animals and fruit
- a line between two different colors
layer3-270
human annotations
- space above a animal
- the background
- backgrounds in pictures
layer3-100
human annotations
- necks of objects and breasts of birds
- the small part of lighthouses or similarly shaped things
- front of objects
layer4-114
human annotations
- spotted animals and objects
- animals and textured objects
- spotted dogs
layer4-566
human annotations
- animals and fences
- objects that contain grey lines
- rounded edges in pictures
layer4-1250
human annotations
- people in old photos
- animals, wheels and clocks
- similar color patterns
layer4-1774
human annotations
- natural linear patterns in various colors
- a yard ball, a bird on a pierce, a beetle, a bird on a branch, a dog on the floor
- green objects
layer3-17
human annotations
- bodies of dogs and cars
- bodies of dogs
- torso of dogs and mid sections of vehicles
layer3-52
human annotations
- the sky and pale areas
- sunglasses
- bright and sunglasses
layer4-500
human annotations
- animals and the beach.
- these things look textured and black
- dogs that have black fur on them and long ears
layer3-925
human annotations
- clothes, animals and cups
- articles of clothing
- clock, spider, axe, person
layer4-1625
human annotations
- lake, lake, building
- water sources
- two items that are connected
layer4-1529
human annotations
- insects, flowers, a dog's paws, right of a dog, a person standing on a whale, a chair
- animals and triangular objects
- the region has two items on the side of a third object
layer3-195
human annotations
- a worm crawls through the sand
- waves edges of different colors
- a wavy curve
layer1-245
human annotations
- aquatic life, a dog playing tug of war, stripes of a zebra
- white lettering
- stripes in picture
layer3-99
human annotations
- the color brown and edges
- circles and chin
- objects that resemble noses
layer4-398
human annotations
- animals, food, and circular objects
- several different food items, and there are dogs searching for food
- yellow areas in pictures
layer4-770
human annotations
- body parts and trees
- animals and people
- a person holding an object
layer4-1392
human annotations
- sink, na dog, foxes in the wild
- animals and bathroom objects
- person, nature
layer4-1922
human annotations
- a lizard, cat peaking through a screen, a man holding a fish, a snake ,a monkey, a bird
- textured object
- living things
layer2-94
human annotations
- spaces on the side of a van
- purple, green and yellow areas of toys, cars and nature
- brightly colored spots
layer3-26
human annotations
- chests of people
- waists of different women
- horizontal line
layer3-683
human annotations
- edges or birds, circular objects and furniture
- corners and round edges
- on the sides of objects
layer4-601
human annotations
- dogs, balls, and wooden tables
- animal, nature
- pictures of animal
layer4-1578
human annotations
- insects and animals
- people and animals
- bugs and fish
layer4-1426
human annotations
- a bird on a tree beach, a wild gazelle, a pitcher of beer, a dog on the pavement
- animals, bottles and signs
- brown animals and alcohol
layer1-15
human annotations
- neon colors
- sticker on a cabinet, space on a keyboard
- green areas in picture
layer1-118
human annotations
- white spots of sea creatures
- sharks and the ocean
- lighter areas
layer3-106
human annotations
- traffic lights and curvy lines
- spiraled objects and street lights
- things that look like stop light or spirals
layer4-378
human annotations
- animals
- items with curved areas
- pictures of animal
layer4-773
human annotations
- animals in clothes
- military uniforms
- khaki-colored fabrics and upholstery
layer4-713
human annotations
- people, corns, buses and orange objects
- objects with red and yellow hues
- human mouths
layer3-744
human annotations
- green objects
- green objects and buttons
- power sources that work the system by greatly controlling the operation of the object
layer4-323
human annotations
- arms and wheels
- circular objects
- wheels
layer4-1340
human annotations
- a basket of fruit, a animal's snout, a box of toys,fruit on a table, a scale
- animals, food, and cookware
- items that are connected
layer4-1105
human annotations
- people, vehicles, signs and switches
- faces and white objects
- rectangular objects or faces
layer2-489
human annotations
- whiskers of a cat
- diagonal and curved lines in animals or wicker baskets
- similar patterns
layer3-408
human annotations
- pathways and rooftops
- many walking paths and roads with some roof structures
- paths people can walk
layer3-398
human annotations
- dog paws and birds
- bits of black in urn
- brighter areas in objects
layer2-257
human annotations
- edges of blue and brown
- lattice structures
- similar patterns
layer4-590
human annotations
- insects and birds
- animals and produce
- rounded, tapered objects
layer4-591
human annotations
- animals, bases, treehouse, and bottles
- dogs
- eyes
layer4-1143
human annotations
- face of a person, dog, washing machine, ferret
- dogs and people and sticks
- animals or people
layer3-244
human annotations
- the color red
- parts of orange red items
- red colored objects
layer2-217
human annotations
- repeating lines
- sections of spiral shaped lines
- tops of clothing and birds
layer3-149
human annotations
- dots outlining corners of a object
- multicolored decorations
- animal, nature, person, food
layer4-447
human annotations
- poles
- long, thin objects
- large skinny poles
layer4-870
human annotations
- a trophy near a door, people in a crowd, bottom of food, bottom of a punching bag, bottom of a cup
- things with necks and pie crust
- goblets
layer4-1666
human annotations
- front of a barn, a shoping cart
- circular objects and flags
- the region has items with corners
layer3-223
human annotations
- a bird, a elephant
- beaks and eyes of birds
- these parts have orange in them
layer2-201
human annotations
- spots surrounded by white
- black dots on objects
- sneakers, shoes, vase, cleaning product, mug, plane, clouds
layer4-34
human annotations
- animals and animal products
- red objects
- meat
layer4-1229
human annotations
- animals with eyes and fur
- animals and things with black dots
- items with circles on them
layer4-852
human annotations
- a dog having fun, a beaver walking down pavement, a slug moving, a sheep, a lizard, a pig, a koala bear
- animals
- white dogs
layer4-1500
human annotations
- a person playing a xylophone, a kid on a stretcher, a keyboard, people cooking food, the topo a roof
- laptops, xylophone, grills and other things shaped like tables
- items inside of items
layer3-179
human annotations
- a dog
- the faces of dogs
- dog
layer1-157
human annotations
- computer scree, a kid kicking a football, a car with green paint, hard drives sitting on a laptop, aquatic life, cars
- spots of light colored areas
- the items are either electronics or vehicles which also have to have a source of power
layer2-247
human annotations
- dots on animals, letters and sticks
- pale areas
- edges
layer4-84
human annotations
- fur of animals and tires
- wheels, handles and animal parts
- wheels of wheelbarrows
layer4-963
human annotations
- hamsters, a guy playing guitar, a fish in the water, a knife in sheath a boat on the water, a pair of gloves, a fish ,a dog, a bottom of a christmas tree
- things with holes
- eyes and objects that resemble them
layer4-1331
human annotations
- fluorescent blue
- sea creatures
- the color blue
layer4-1890
human annotations
- animals, hot dogs, a cucumber, an eraser erasing stick figures, and a line on a road
- lines
- items of central focus
conv1-54
human annotations
- fluorescent green and yellow areas
- green screens
- the negative lighting of an image
layer1-59
human annotations
- text around the logo of a fresh
- small black dots and lettering
- sign, text
layer3-555
human annotations
layer3-165
human annotations
- fruit, circular objects and butterflies
- portions of rounded objects
- fruits and clocks
layer4-1205
human annotations
- animals and rocks
- identical items in them
- groups of things
layer4-1282
human annotations
- a sunset, a boat, a bird, person holding cup
- animals, roofs anteater
- people holding up objects
layer2-434
human annotations
- wine bottles on a rack an airplane
- outlines on grids, sticks and ornate objects
- a criss cross design
layer1-247
human annotations
- bird's legs, a dog ina photo, a safe, a musical on stage, a boat on the water
- shows the color orange
- orange areas in picture
layer4-175
human annotations
- object with curve side
- everyday objects
- white objects
layer3-716
human annotations
- animals wearing masks and human tools
- noses of animals
- animal, insect, remote control
layer4-958
human annotations
- animals and metal objects
- brown dogs
- lighter areas in pictures
layer4-1555
human annotations
- animals, feathers, hats and rimmed objects
- fur, feathers and objects with lines
- blue objects and dogs
layer1-164
human annotations
- spots of the color white
- birds and blue skies
- tiny bits of the bottom
layer2-173
human annotations
- black and white borders
- animals
- a line between two shades
layer4-62
human annotations
- dog heads and white backgrounds
- shoulders of people
- this region contains sides of objects
layer4-406
human annotations
- legs and wheels
- legs of dogs
- feet of animals or landing gears on planes
layer4-943
human annotations
- ducks on the water, aperson standing on a platform by train, a person intel grass, a spider, a statue
- animals
- dogs and grassy areas
layer4-1435
human annotations
- a animal walking down the road, a camping bag, a ship on the water, watch someone is wearing, a musician on stage
- people holding objects
- circular
layer3-285
human annotations
- a person going down in the water
- legs of different dogs
- legs and arms
layer2-467
human annotations
- spots of red
- a dogs toy, dogs playing with each other hockey players, flowers in a field, graphic
- red areas of clothing
layer3-814
human annotations
- fluorescent colors
- green lights and dots
- various green objects
layer3-896
human annotations
- the right side of objects
- rounded edges and office supplies
- brighter areas in objects
layer4-960
human annotations
- birds and orange objects
- animals and signs
- red objects and animals
layer4-1306
human annotations
- birds and round objects
- birds, bags, and food
- person, nature, food
layer1-186
human annotations
- the color yellow and text
- red lettering on yellow background
- red and yellow, and green looks like a fire
layer1-32
human annotations
- a remote control
- sign, electronics, person, logo
- under text and picture accents
layer3-619
human annotations
- the edges of objects
- outline of a flower or animal
- faces of different animals
layer4-548
human annotations
- handles and parachutes
- arched objects and handles
- curved items in them
layer4-723
human annotations
- wild animals and nature
- animals and people
- humans and animals
layer4-2034
human annotations
- a grass plain with a house, a tractor, dog
- tan colored
- landscapes
conv1-43
human annotations
- a speedometer
- muted images
- towers and baskets
layer3-162
human annotations
- curved corners
- corners of different objects
- corners of objects
layer4-792
human annotations
- objects that are long
- nail shaped objects and boxes
- long, thin horizontal objects
layer4-1871
human annotations
- food, telephone
- everyday objects
- triangular items
layer3-91
human annotations
- angled transitions from light to dark
- objects with white spots
- similar patterns
layer3-379
human annotations
- single colored beams and pillars
- long rounded objects
- brighter areas in objects
layer4-461
human annotations
- faces of dogs and people wearing glasses
- dogs, handles and tents and similar shapes
- faces of living things
layer4-983
human annotations
- animals, appliances and windows
- black and white dogs
- spotted
layer4-2038
human annotations
- yellow objects
- yellow items
- yellow areas in pictures
conv1-12
human annotations
- shopping cart
- fluorescent green and yellow objects
- green grass
layer2-26
human annotations
- spots of objects bordering blue
- dogs
- front of objects
layer3-515
human annotations
- straight lines and knobs
- legs or sticks
- skinny sticks and poles
layer4-1245
human annotations
- water
- swampy areas
- rivers, lakes and waterfalls
layer4-786
human annotations
- a dog's snout, a car in the grass, a dog walking along path, aperson in inform
- animals or metal objects
- dogs
layer1-182
human annotations
- a dog looking ahead, the space above a man's shoulder on a magazine, space above the text on a shirt, a shark in the water, a hammer head shark
- person, animal
- tops of animal head
layer3-326
human annotations
- corrugated wires grooves and patterns
- repeating parallel lines
- coiled, lined or rounded things
layer3-606
human annotations
- plants and animals
- feet of dogs
- crease between limbs or body regions
layer3-842
human annotations
- circular objects
- rounded edges
- dog eye
layer4-1367
human annotations
- birds, windows, poles and subs
- buildings by water
- animal, boat, castle
layer4-1055
human annotations
- textured areas
- faces of different organism
- on the sides of objects
layer2-352
human annotations
- belt buckle with it
- small eyes
- round portions of images
layer1-187
human annotations
- string on a guitar
- yellow and green backgrounds
- yellow spots on animals
layer3-491
human annotations
- tails of dogs
- dog tails or ears
- rounded edges in pictures
layer3-781
human annotations
- the front chests of several dogs
- these are dog shoulders
- dogs in them
layer4-944
human annotations
- beads, teeth and stripes
- fish
- fish and other animals
layer4-1559
human annotations
- the background
- brown foxes
- animals, sign, people
layer4-1901
human annotations
- a women holding a microphone, a man ironing
- items with straight features
- cylindrical shapes
layer4-1649
human annotations
- matchstick tower, rack of shoes
- animals, weights and textured objects
- textured
layer4-1716
human annotations
- a mop, a computer screen, a suit a guy is wearing
- legs, poles and household objects
- angles
layer2-227
human annotations
- bodies of land animals
- the outlines of some things
- similar patterns
layer3-995
human annotations
- monkeys
- areas at the top
- around animals
layer4-547
human annotations
- objects made of metal
- pants, furniture, and metal objects
- sharp knives
layer4-436
human annotations
- bottles and shelves
- people, shelves and electronics
- people, toaster, cargo, building
conv1-31
human annotations
- stripes of a zebra
- thin white colored lines within a striped pattern
- thieves used a mask
layer2-492
human annotations
- spots of the color white and brown
- areas in the background
- eyes and things you look through
layer4-39
human annotations
- small circles and shapes
- spherical objects with dots
- rounded objects
layer4-251
human annotations
- hind legs of animals and sharp edges
- rectangular objects and animals
- mouths and rear ends
layer4-1164
human annotations
- buildings and sticks
- roofing
- house roofs
layer4-921
human annotations
- animals in the wild
- bird the water, hog, dog
- black animals
layer4-1720
human annotations
- an animal in the sand, a monkey on a rock, a snowmobile, a dog staring forward
- animals and vehicles
- two items that are connected
layer2-6
human annotations
- blue objects
- orange objects and dogs
- orange areas in picture
layer4-416
human annotations
- boats and edges of objects
- boat like objects
- ship, animal, cassette
layer4-1979
human annotations
- a dog in the grass, a dog on carpet, a bowl on the ground, a chicken on the ground, a bird on a tree
- brown dogs
- the top of things
layer2-417
human annotations
- hourglass, a meerkat sits on a sign, a bird on a branch
- outlines of the background
- white areas on objects
layer2-97
human annotations
- text on a ballon, text above a dog's head, space above a bird's head
- area where color change occurs
- spaces around animals
layer3-838
human annotations
- poles and sticks
- skinny poles and red balls
- long narrow stick-like objects
layer3-726
human annotations
- corners of animals
- dog ears
- edges or i-shaped
layer4-1328
human annotations
- a hippo in the water, a rusted chain, fruit, dogs laying down
- animals, chains, wheels and food
- brown dogs
layer4-1420
human annotations
- faces of people and dogs
- a man with a green shirt, dogs walking along, a library of books, a kid playing, a kid posing for a photo, right of a woman
- bookcases and dogs
layer2-415
human annotations
- blue and white stripes
- thin black stripes on them
- lines
layer4-137
human annotations
- uneven surfaces with patterns
- things with cuts in them and animals
- objects with ridges
layer4-725
human annotations
- a trailer someone is hauling, vegetables, flowers, a woman holding a maraca
- fingers, circular objects and flowers
- red objects
layer2-366
human annotations
- space above a animal
- monkeys and dogs
- parts of blue white skies or areas above objects
layer2-69
human annotations
- the lightest parts of each scene
- aquatic life, a bunch of penguins looking for food, a lady in front of a aquarium with a shark in the background, fruit
- sharks
layer3-133
human annotations
- wine glasses
- hands holding something in them
- triangular bottom
layer4-1182
human annotations
- birds and furniture
- small red objects
- similar patterns
layer4-679
human annotations
- a dog outside, a penguin walking ,a golf ball, a train on the tracks. a sunset in the sky, a bottom of a cup
- animals, vehicles and the ground
- brown animals
layer4-2036
human annotations
- dog, fox, crab
- two items that are connected
- person, animal
layer3-222
human annotations
- insect and animal legs
- insects, animals
- mostly legs and arms
layer1-130
human annotations
- the color yellow and spots of the color white
- horizontal lines
- brighter areas in objects
layer3-143
human annotations
- dog ears
- the tops of rounded things
- areas underneath an object
layer4-1281
human annotations
- animals and windows
- objects with grids or lines
- a criss-cross design
layer4-881
human annotations
- a spider on the wall, a snake, a windmill in the distance, a goat
- animal legs and wings
- insects
layer4-1717
human annotations
- animals, cups and vehicles
- animals
- items with straight lines
layer3-217
human annotations
- seating and instruments
- look like creases
- animal
layer3-377
human annotations
- edges of animals or objects
- animals
- specific patterns
layer2-262
human annotations
- white and reflective surfaces
- shine in animal's eyes, reflection of light on objects, lighting, and white dots
- shiney objects
layer4-760
human annotations
- outdoor towers and an animal
- animals, towers and poles
- furry animals and towers
layer4-666
human annotations
- people and plants that are green
- green objects and a bed
- green produce
layer4-1953
human annotations
- objects with circular gaps
- circular objects
- buckets and bowls
layer2-475
human annotations
- a fish in a pool, a butterfly, people riding a horse, a deer on a ledge, a meerkat
- clothing and animals
- edge of pictures
layer3-864
human annotations
- bowls and cakes
- red objects
- include patterned items
layer4-1305
human annotations
- animals, circular objects and poles
- round red objects
- person, nature
layer3-9
human annotations
- aquatic life, insects, two people on a bike, a headlight of a truck, to monitor, tractor wheels
- these images all have the colour orange in common
- orange areas in picture
layer2-104
human annotations
- outlines of objects
- aquatic life
- the back of objects
layer4-568
human annotations
- food and drink
- cookware
- hands and round objects
layer3-677
human annotations
- arms and poles
- guns
- gun, fish, shark, truck, bridge
layer4-1998
human annotations
- remote, bird, lawnmower
- birds, faces and objects that look like faces
- an item of central focus
layer4-1382
human annotations
- people and bottles
- human bodies and objects that may resemble them
- two items that are connected
layer3-342
human annotations
- lines with small holes between
- pills flow from a bottle, a person wears a medical device, a person blows out a candle, bowls on a shelf
- colorful curved objects and necks
layer1-200
human annotations
- a poodle in on a ground
- dots outlining a object
- moving objects
layer3-878
human annotations
- dots and circles
- eyes of different animals
- a circle in a circle
layer3-600
human annotations
- bandages
- objects that are a lighter color than their surroundings
- like on top or areas with a shape in it
layer4-1301
human annotations
- animals and bird in the wild
- animals and boats
- animals and people
layer4-1085
human annotations
- dog, bird, spider, towering building
- animals, towers and cactus
- rounded items
layer1-237
human annotations
- borders of white and black
- black lettering and numbers
- written text and patterns
layer2-25
human annotations
- shark in thewater, a pumpkin cut out with holes, a fire truck a ipod
- pale areas on or around an object
- brighter areas in objects
layer4-242
human annotations
- animals, toys and curved objects
- boat, animal, toy, person
- things outside
layer4-249
human annotations
- i shapes, lights and animals
- hooks and metal objects
- rectangles with a circle in them
layer4-715
human annotations
- food items and objects on grass
- rocks, laptops, animals, clothes and silverware
- bottom clothing
layer4-1554
human annotations
- space on the left and right side of a thimble, snowman, person's hand doing sign language, a dog laying on therans
- objects with red or brown hues
- items with straight features
layer3-214
human annotations
- the color blue and white surfaces
- a trunk lid, a old style camera edge
- nature, rooftop, drum, mailbox
layer1-216
human annotations
- a kid passes a baseball through a fence, a bird sits atop a branch, a curtain waits to be pulled, a spider web, a snake, a musician
- tan specks
- specific patterns
layer3-607
human annotations
- animals and electronics
- eyes of dogs
- curved lid area
layer4-190
human annotations
- wooden objects
- small sticks
- snowman, popsicle, pencil, rod, pole
layer4-629
human annotations
- poles
- legs, fence posts and lines
- fencing
layer4-1416
human annotations
- aquatic life, again life, tree branch, a sewing machine
- animals, pens and wallets
- salamanders
layer1-30
human annotations
- a group of kids throwing a basketball
- tiny bits of the lighter areas next to dark ones
- text, person
layer2-34
human annotations
- the color white above an image
- animals
- above objects
layer2-254
human annotations
- brown and tan colors
- human eyes
- on the sides of or under lines
layer4-377
human annotations
- snakes and similarly shaped animals
- black snakes and slugs
- curved body of reptile
layer4-1174
human annotations
- animals and textured objects
- brown dogs and fencing
- two objects that are touching each other
layer3-296
human annotations
- a cat in the distance, a house window
- pale or white color regions
- blue skies and pets
layer3-383
human annotations
- faces of animals and single color surfaces
- center or nose
- faces of animals
layer4-176
human annotations
- animals, mics and pens
- brown dogs
- a pointed tip like a dog's nose
layer3-718
human annotations
- people faces that are wearing eyeglasses, a mask or a breathing apparatus
- faces
- sunglasses
layer4-1957
human annotations
- carts, clothes, animals, and furniture
- objects containing lines, textures or patterns
- shoes and shorts
layer4-1368
human annotations
- food items and balls
- fish, fruit, old basketball, food, dog
- baked goods
layer2-228
human annotations
- fences and repeated dots
- honeycomb and lattice structures
- spotted items
layer3-590
human annotations
- the outlines of animals
- black dogs
- the area around animals
layer3-763
human annotations
- outlines of animals and vehicles
- ears of people and animals
- rounded edges in pictures
layer4-1556
human annotations
- aircraft, weights, ball someone is kicking
- these things have wheels of fly
- angles
layer4-1710
human annotations
- bird, insect, dog, pen
- animals, pens, rails and vehicles
- items with straight features
layer2-433
human annotations
- an ape
- the wall and the sky
- background of images
layer2-435
human annotations
- colorful designs
- a peacock and a dog with spots
- eyes and dogs
layer2-86
human annotations
- the left side of a dog, scooter's handle bars, text on a speedometer
- white outlines of objects
- sharks
layer4-168
human annotations
- animals and wildlife
- thse are animal heads
- heads of different animals
layer4-296
human annotations
- round spheres and domes
- balls and skyline
- curved areas
layer4-1387
human annotations
- objects in front of grass
- a truck on the ground, a dog, a person in the grass, a swings
- grass
layer4-1402
human annotations
- legs and yellow objects
- yellow and red areas
- yellow objects
layer2-91
human annotations
- space on the microphone of someone singing
- blue dots
- tags
layer3-54
human annotations
- light colored at the top
- blue regions of sky that are above animals
- above images
layer4-362
human annotations
- star fish
- animals and wooden objects
- star fishes
layer4-809
human annotations
- animals and flowers
- textured objects and surfaces
- pink flowers
layer4-1410
human annotations
- bedding of a snake enclose, a dog playing on the grass, a person using machinery
- animals, sticks, ropes
- animal, nature. people, basket
layer4-1669
human annotations
- text on a sign, snake in the grass, monkey, vase, dog
- animals and domed objects
- two items that are connected
layer4-1078
human annotations
- dress someone is wearing, bra of aperson, shoes
- animals, circular objects and balloons
- women's clothing
layer4-1025
human annotations
- dogs, windows, pencils and trains
- column shaped objects and furry animals
- brown dogs
layer1-89
human annotations
- birds walking along the ground, a dog walking, a group basket
- birds
- basket, animal, nature, text
layer3-322
human annotations
- cups on a shelf, items on a shelf, a guy sitting on a rack
- bookcases
- horizontal lines
layer4-106
human annotations
- the ground
- wheels and legs
- wheels
layer3-903
human annotations
- thesea re sticks
- twigs and birds
- pictures of wood
conv1-34
human annotations
- stripes of a zebra, spots on the accordion a women is playing
- white dots outlining a object
- black and white lines
layer2-42
human annotations
- spots of the color white
- crossing a sign on a corner, a kid holding up a stick, aquatic life, fruit, a kid standing by his parent
- lighter areas
layer4-42
human annotations
- wood floors and walls
- wooden flooring
- hallway, animal, rug, insect, wall, person
layer4-261
human annotations
- poles
- skinny metal bars
- fence, insect, person, lawn mower, bridge
layer4-507
human annotations
- animals, fire and lamps
- amber objects
- rounded areas
layer4-1573
human annotations
- heads of babies and people with hands on their lips
- a dog taking a nap, a dog playing a harmonica, a person thinking, a kid, a soldier
- animals and babies
layer4-1731
human annotations
- an one going down the road, a camel on snow, bacteria under microscope, a water tower in the distance, road
- the road, water, and poles
- items with straight features
conv1-36
human annotations
- cap of a pen
- bright blue
- colour of the blue
layer2-246
human annotations
- repeating holes and lines
- poles with ridges
- lines like a screw
layer4-405
human annotations
- animals and ships
- sailboats
- ships, water, penguin, food
layer4-1159
human annotations
- animals, tops and circular objects
- pointed objects
- rounded objects and chins
layer4-1047
human annotations
- buildings and faces
- animals, roofs and circular objects
- eyes of humans and animals
layer3-308
human annotations
- the wheel of a car
- lens flares
- yellow food products
layer3-6
human annotations
- dogs lay on the ground
- animal faces
- multiple patterns of different fur colors
layer4-204
human annotations
- animals, metal objects and leather
- bugs and chains
- tails on lizards or longer pieces of metal
layer3-884
human annotations
- walls and electronics
- clock, sky, band aide, toy pig
- rounded edges in pictures
layer4-1558
human annotations
- nail, a squirrel on a branch, a dog in the grass, a scorpion's tail, a man holding a remote, a building in the distance
- brown or grey surfaces
- things that are rectangular in shape
conv1-45
human annotations
- tool's a kid pulls out
- red or orange
- red objects
conv1-53
human annotations
- stripes of a zebra
- black and white stripes
- brighter parts of objects
layer3-543
human annotations
- fins, wings and pottery necks
- sharks and birds
- sharp things on animals
layer3-533
human annotations
- white corners of photos
- corner of image
- spots on the side and top
layer4-1199
human annotations
- dogs, boats and housewares
- animals, balls, and furniture
- rounded edges in pictures
layer4-520
human annotations
- animals and containers for liquid
- animals, ceramics and bottles
- rounded edges in pictures
layer2-493
human annotations
- leaves of a tree or branches, a dog sitting on a chair, a lighthouse, a person walking down a path
- a thin black line in them
- various spots in images with animals or humans in them
layer3-661
human annotations
- poles, plants and people
- textured objects
- colorful rope and fabric
layer4-1621
human annotations
- bikini, traffic light, flag, weights
- animals, planes, weights, speakers and flags
- person, plain, animal, weights
layer3-508
human annotations
- i's on animals and beads
- areas that are connected
- jewelry, insect, animal
layer2-215
human annotations
- spots of the color white
- dots outlining objects
- the are the edge of objects
layer4-1240
human annotations
- backgrounds and bottles
- yellow bottles
- orange areas in picture
layer3-955
human annotations
- laptops, screens and doors
- computers
- cubed objects
layer4-1782
human annotations
- animals and cylinders
- items with angles
- pictures of animal
layer4-1747
human annotations
- water near a building, a fish near a flower, an insect
- green colored objects
- objects on other objects
layer3-318
human annotations
- star shapes
- arms of humans and animals
- similar patterns on objects
layer1-188
human annotations
- spots of the color white bordering black
- words and outlines of curved objects
- round objects and sharks
layer4-112
human annotations
- legs, strings and poles
- wooden objects
- items that are nearby other similar items
layer3-646
human annotations
- animal and fruit parts
- fresh fruit
- a crease: concave or convex
layer4-1980
human annotations
- beetle, telephone, dog, childs face, sloth
- items with angles
- animals, people
layer4-902
human annotations
- objects with dots and holes in them
- animals, buses, baskets and fruit
- green strawberries
layer3-231
human annotations
- a camels neck, a dog's tail
- things shaped like a hook or peak
- necks of different animals
layer2-52
human annotations
- spots of the color white
- colorful patterns on different objects
- brighter areas in objects
layer4-149
human annotations
- texture features on objects
- hats
- mop, person, hat, animal, cart
layer4-458
human annotations
- circular objects
- rounded objects
- small red objects
layer4-631
human annotations
- the sky in an image
- shiny objects with curves
- red objects
layer4-1640
human annotations
- a large building, people wearing cowboy hats
- people's heads with different types of hats on them
- decorative items
layer2-12
human annotations
- spots of the color white
- text of an object, a dogs paid in snow, random objects on the ground, keys on a keyboard, front of a hawk's face
- brighter areas in objects
layer3-435
human annotations
- striped clothing items
- clothes
- gaps in between things
layer3-731
human annotations
- objects with multiple lines and holes
- sticks and crowds of animals
- multiples of the same object
layer4-424
human annotations
- bottles, cases and things shaped like bullets
- tapered objects
- alcoholic drinks
layer4-1594
human annotations
- handles, chains, leashes and similar items
- chins and hands
- person, radio, animal
layer4-2042
human annotations
- rectangular object
- windows of several buildings
- squared items
layer3-371
human annotations
- these and sticks and poles animals are holding
- sizes of twigs
- a stick sized item in them
layer4-370
human annotations
- wheels, people, and drains
- tires of bikes
- rounded objects
layer4-1954
human annotations
- a monkey on a tree, a penguin walking on the ground, a window open, a dog on the dirt
- animals, pillows and statues
- living things
layer2-421
human annotations
- spaces on a top of a sign, spaces on a pillar of a business, stripes of a shirt
- stripes
- patterns
layer3-970
human annotations
- banded designs around objects and living things
- metal hooks
- specific patterns
layer3-655
human annotations
- animals, jewelry, and metal objects
- dogs
- person, animal, jewelry, logo, instrument
layer3-938
human annotations
- nails and handles
- hair dryers and screws
- items with corners
layer4-932
human annotations
- insects and animals
- animals and plaques
- furry animals
layer4-1483
human annotations
- chicken, cat, mouse
- animals
- living things
layer3-312
human annotations
- flocks of birds in a sky, an animals eye
- eyes and heads
- eyes and dots
conv1-28
human annotations
- stripes of a animal
- black and white stripes
- the zebras all have stripes and are standing outside
layer4-104
human annotations
- keys, grates,balls, and poles
- hands and paws
- keyboards
layer4-364
human annotations
- cups, towers and maracas
- thin stick and connected objects
- balls, balloons, water tower, lightbulb, joystick
layer4-1100
human annotations
- words
- human hands holding objects
- areas above or below items
layer4-2022
human annotations
- animals, firearms and trains
- black dogs
- person, animal, gun
layer1-88
human annotations
- a bear running across sand, a dog going through the pasture with flowers
- red objects and text
- red areas in pictures
layer3-90
human annotations
- bottles, towers, and fruit and legs
- towers
- a rounded object in them
layer4-236
human annotations
- animals and trees
- birds
- animals
layer4-1181
human annotations
- objects that have beaks, tails, containers for fuel, transportation, strings, wings, light source, red and green, and construction
- vehicles and objects with curves
- animals, vehicles and wooden objects
layer4-1949
human annotations
- natural backgrounds
- textured surfaces
- dogs
layer4-1646
human annotations
- waterway, skiers on a mountain, trees
- animals, sticks, water and spikes
- long straight items
layer4-783
human annotations
- animals and objects with lines
- birds
- pictures of animal
layer4-875
human annotations
- switches and tools
- rectangular object
- light switches
layer4-1758
human annotations
- ambulance, water tower, a fox in the snow, a bug on a branch, a dog someone is holding, a tractor
- poles, towers, animals and metal objects
- animals, lock, water tower
layer4-1865
human annotations
- memorial, watch, lighthouse, meter, barn, sign
- buildings, boats, beauty products and benches
- items with something in the center
layer1-10
human annotations
- a birds on a waterway
- eyes of animals
- there white outlines of things
layer3-86
human annotations
- animal eyes
- dog faces
- two similar areas that are separated by a third area
layer4-87
human annotations
- animals and pens
- long, thin pointed objects
- brown dogs
layer4-1697
human annotations
- animals, trucks and metal objects
- areas with multiple lines
- items with straight features
layer2-354
human annotations
- dogs posing for a photo
- eyes
- the eyeballs are shining bright
layer2-294
human annotations
- a spider on a glass pane, a old chevy wiith trim of the glass windshield
- curved edges
- car in the places
layer3-589
human annotations
- animals and green and red objects
- eyes of birds
- faces of people and birds
layer3-76
human annotations
- orange and red objects
- sports vehicles
- brighter areas in objects
layer4-527
human annotations
- circular objects and birds
- rounded objects
- birds and grass
layer4-1171
human annotations
- faces of people wearing hats
- people
- faces of different people
layer2-341
human annotations
- a group of bottles, a firetruck
- objects with patterns
- the lipsticks and other containers are lined up and are in layers
layer2-440
human annotations
- base of a monument, space inbetween zebra stripes
- pale areas in between dark lines
- stripes on different things
layer3-130
human annotations
- signs, words and rulers
- rulers and routers
- similar patterns
layer3-803
human annotations
- animals with things on their faces
- dog muzzles
- masks for dogs and people
layer4-524
human annotations
- animals, toilet paper and helmets
- white objects
- neck braces
layer4-709
human annotations
- animals with whiskers, metal objects and cardboard
- animals, boxes and chains
- brown animals
layer4-1715
human annotations
- sign, a dog in the forest, a bottle of perfume, a dog in the grass
- the sides of objects
- rounded edges in pictures
layer1-205
human annotations
- left of a man on stage
- purple, red and blue fluorescent objects
- pink in them
layer2-165
human annotations
- red and white objects
- a line of color in them
- red and white colored areas on towels, fish, and paper
layer4-184
human annotations
- animals and things with sticks
- items with a separation
- nature, animal, person
layer3-915
human annotations
- the background
- shaggy dogs
- part of the plain side background
layer4-1576
human annotations
- building, butterfly on blades of grass, insects
- buildings, plants and animals
- green grass
layer4-1596
human annotations
- a dog walking along the grass, a green shirt a man is wearing, a cat is drinking from a dish
- animals
- animals that have fur and feathers on them
layer2-505
human annotations
- people pose for a group photo, a person with a neck collar, people at market, dogs outside, a guitar pick in strings
- white and pale spots
- small light colored objects in an image
layer3-978
human annotations
- dog mouths
- dog tongues
- dog mouths
layer3-965
human annotations
- red objects
- beaks of birds that are red
- red in them
layer4-811
human annotations
- irregular coiling or curving shapes
- coiled objects and animals
- spiraled objects
layer4-1434
human annotations
- animals, stages, bridges and metal work
- red or brown objects
- amber creatures and objects
layer4-1517
human annotations
- bottles, cans and animals
- bottles and objects shaped like them
- the regions have long, thick items
layer3-58
human annotations
- squashes
- weird designs in them
- text or light colors at the top
layer1-250
human annotations
- pale areas of text and objects
- sharks
- living organisms
layer4-540
human annotations
- tis is sand, ocean and similarly colored objects
- the beach
- the sides of items
layer3-934
human annotations
- animals and yellow objects
- dog fur
- pictures of animal
layer4-1530
human annotations
- guard, dancers in a crowd
- people, animals and bowls
- two items that are connected
layer4-938
human annotations
- bodies of animals
- animals and orange items
- brown dogs
layer2-24
human annotations
- white areas surrounding text and patterns
- sharks
- patterns
layer2-187
human annotations
- yellow objects
- yellow areas in pictures
- yellow objects
layer4-392
human annotations
- animals and flowers
- the ones at the bottom like legs
- stationary standing creatures
layer4-1153
human annotations
- animals
- birds
- arms or wings
layer4-936
human annotations
- dog, fruit, space on the left side of a dog, roof next to a donkey
- bricks and red foods
- red objects
layer4-1802
human annotations
- dogs playing, a statue on thereof, a horse
- dark-colored, four-legged creature
- items with straight features
layer3-444
human annotations
- circular objects, buttons, and text
- small buttons on devices
- similar patterns
layer3-505
human annotations
- rectangular objects with a background
- curved corners
- rounded edges in pictures
layer4-1224
human annotations
- barrels, pants and pots
- buckets and rounded edges
- red buckets
layer4-1161
human annotations
- words
- lines of text on white surfaces
- corners and edges
layer4-1652
human annotations
- candy in a basket, a bug on a log, a motorcycle, a parachute, birds in the sky
- animals, bubbles, vehicles and sticks
- multiple items that are similar
layer4-1905
human annotations
- chairs on a porch, left side of a sign, a oil rig, a girl wearing a skirt
- feathers, chains and grass
- items with angles
conv1-14
human annotations
- nothing literally nothing
- a toilet papered car
- grassy areas and fish
layer3-453
human annotations
- squares and white backgrounds
- fencing
- box shapes in them
layer3-522
human annotations
- metal rods
- sky, animal, insect, knife, swing
- rounded edges in pictures
layer4-335
human annotations
- switches and doors
- white objects around the house
- white pictures
layer4-789
human annotations
- white objects in the sky
- birds, fences and yellow objects
- surfaces with blue and grey hues
layer4-1653
human annotations
- a dog, a fox, a armadillo, a beetle, an elephant
- animals, clothes and sunsets
- textured area
layer3-39
human annotations
- areas of photo next to animals
- ragged edges or gradients of color
- patterns
layer4-381
human annotations
- barrel shaped items
- hollow round objects
- large tube shaped objects
layer4-413
human annotations
- vehicles and animals
- vehicles and textured objects
- vehicles
layer4-735
human annotations
- bricks and water in the background
- textured areas
- brown dogs
layer3-263
human annotations
- a pot to pour liquid from, a birds beak, a guy holding a barrel, a oflooking for somethig, a guy hitting a gong, a fox
- the color tan
- animal, bird, person
layer2-385
human annotations
- two cranes pose by a tree trunk, a strawberry
- dots outlining a object
- dogs and birds
layer3-794
human annotations
- walls or the sky
- food
- sky, nature, interior walls, table
layer4-463
human annotations
- animals and curved objects
- green grass
- sky, plant, animal, nature, bail of hay
layer4-642
human annotations
- blue jeans
- blue jeans and objects
- objects with blue hues
layer4-1650
human annotations
- animal left and right side of a sky
- the sky, walls or water
- the sides of objects
layer2-286
human annotations
- a keyboard, a radio in the desk a vespa
- small holes that are different colors
- tower, animal, water, shark, sink
layer3-404
human annotations
- the color red
- red articles of clothing
- orange areas in picture
layer3-60
human annotations
- the top of objects
- food
- spots above items
layer3-702
human annotations
- shiny objects and the sky
- blue skies
- regions that are on the sides of objects
layer4-776
human annotations
- animals and small insects
- animals and mics
- textured surfaces
layer4-1583
human annotations
- a shirt someone is wearing, a mountain, a dog walking down the sidewalk, a side of ahand, a person swimming in the water
- brown dogs
- living things
layer4-1527
human annotations
- people holding objects
- animals and circular objects
- curved objects
layer1-14
human annotations
- dogs, a pair of birds walking on a beach
- the outline of spiky looking items
- animal, flowers
layer1-109
human annotations
- shark in the water, a group of fish, a whale in the water, a dog in a cage
- sharks
- lighter areas
layer4-153
human annotations
- sticks and other long objects
- wheel barrows
- things that have elongated bodies
layer3-839
human annotations
- bowties
- bow ties
- bowtie looking things
layer4-539
human annotations
- animals and chains
- older chains
- long straight object
layer4-979
human annotations
- a tape player, a bandaid, a side of table, a shovel, a tablet, a side of a hanger a bird is on, a necklace
- metal shovels
- things with metal
layer2-388
human annotations
- flowers on a cup, dog's leash, beams for a jungle gym, text on display
- blue items
- the colors white and blue
layer2-40
human annotations
- a musician on stage, a drum set, a weight on a desk, a person sailing, a person swimming
- pink objects
- purple areas
layer4-50
human annotations
- checkerboard designs
- clothing that has red accents
- the water and other random images
layer3-696
human annotations
- things with holes
- perforated objects
- website, fencing, electronic, instrument, crib, floor, ball
layer4-1288
human annotations
- architectural structures, tails and fins, and apertures
- animals, bridges and buildings
- arched bridges
layer4-1108
human annotations
- a pacifier or a bottle for a kid, a plate of coffe, a tool someone is using
- babies and dogs with things by their mouths
- items that are connected
layer3-369
human annotations
- the images all include straight lines of various objects
- shows strap or straight lines
- legs on animals and similar things
layer3-103
human annotations
- brown dogs
- eyes and fur of several different animals
- parts of fur
layer4-472
human annotations
- faces of people and animals
- animals and circular objects
- fabric, fur or hair
layer4-1158
human annotations
- towers, produce, and pens
- hair dryers
- vertical patterns
layer4-1386
human annotations
- babies and white objects
- animals and people
- white fabric
layer4-1900
human annotations
- textured areas
- fabrics on people, and green or yellowish foods
- rounded items
layer3-295
human annotations
- single color stone backgrounds
- a person playing guitar
- spaces in between object
layer3-996
human annotations
- legs of animals and bugs
- multiple shades of color
- legs of animals
layer3-827
human annotations
- metal tubes
- rounded objects that are metal
- the region shows the bottoms of items
layer4-649
human annotations
- balls, papers, pics and cross words
- rectangular objects
- rounded edges in pictures
layer4-1352
human annotations
- objects in front of grass
- poles
- bottles
layer4-1662
human annotations
- a object on the beach, a cookie a person is holding, a shirt man is wearing, a ball a man is holding
- circular objects
- a rounded item
layer1-214
human annotations
- a close up of a baseball
- lines across the bottom
- water as well as greenery
layer3-463
human annotations
- light reflections
- small red objects
- fuzzy white areas
layer3-834
human annotations
- things with handles, clasps, and necks
- handles of objects
- fence, animal, guitar, roof, vegetable
layer4-450
human annotations
- legs, wheels and boats
- blue objects
- items with straight sides in them
layer4-1383
human annotations
- text on a monument, dog in the field, pig in a field,barn in the field
- buildings, trucks and animals
- animal, sign, nature
layer4-1784
human annotations
- fish, fountain, plate, man's face
- people, food and the ground
- items that are curved
conv1-57
human annotations
- flower or a mushroom ,paint of a car, text and graphics
- red objects
- the color red
layer3-490
human annotations
- orange objects
- orange objects
- light orange objects
layer4-136
human annotations
- animals and cups
- ears of dogs
- animal, food
layer4-1213
human annotations
- sticks, pens, and other long skinny objects
- long rods
- long metal stick
layer4-1120
human annotations
- animals and bridges
- bridges and textured objects
- areas with straight features
layer4-1887
human annotations
- insects, dogs, athletes
- animals
- living things
layer3-191
human annotations
- no noticeable pattern
- the ground of the bottom of a object
- wrists and shrubbery
layer1-227
human annotations
- red color and black and white borders
- right and left side of a cat
- curly items like the letter i
layer4-70
human annotations
- things with a wavy design
- wavy and circular objects
- objects with stripes
layer3-844
human annotations
- noses and joints
- eyes and noses
- body parts
layer4-819
human annotations
- animals, cords and handles
- long, thin objects
- circular objects
layer4-1963
human annotations
- buses, buildings and shelves
- older buildings
- bus, building, castle
layer1-194
human annotations
- sharks in an ocean, an eagle on a branch, a dog from his bowl, a monument
- parts of white areas
- edges of objects
layer3-370
human annotations
- the space above pictures of animals
- canines pose for a hot, right of monkey, apples and bread
- monkeys and foxes
layer4-285
human annotations
- shiny objects
- light brown animals
- people and things
layer4-962
human annotations
- a man playing a flute, a telephone, a man playing trumpet, a bench on the grass
- thse are musical instruments, wheels and lizards
- musical instruments
layer4-1341
human annotations
- animals and round objects
- flags
- shaped like a flag
layer2-346
human annotations
- a women kissing a cat, a bottle of fanta on a table, white dogs for a group photo
- solid white sections of random images
- the animals, bottles, and food are facing forward
layer3-562
human annotations
- buildings, boats and shelves
- bookshelves and walls of buildings
- boat, bookshelf, books, sign, building
layer3-434
human annotations
- black objects on top of items
- animal heads and appendages
- contrast areas
layer4-519
human annotations
- animals and wheels
- animals, carts and circles
- pictures of animal
layer3-943
human annotations
- striped and spotted objects
- snake
- similar patterns
layer4-1917
human annotations
- animals, vehicles, furniture and phones
- vehicles, people, animals, and other items
- items with straight lines
layer4-1664
human annotations
- a house on the beach, a skirt, a barn, monument, a animal
- items with straight features
- red areas in picture
conv1-60
human annotations
- spots on a side of a cheetah
- areas with lines through them
- they show light colors
layer1-33
human annotations
- spots of the color white
- a dog holding a bone
- dots outlining a object
layer3-1012
human annotations
- patterned objects and fur
- intricate patterns, text and animal fur
- similar patterns
layer3-766
human annotations
- lights and lens flares
- ceiling lights
- lights
layer4-764
human annotations
- a bird in the water, a handle of a hammer, a chain on a lock, a drain on the pavement, old fountain, a boat on the water, remote, a beaver on the grass
- animals, chains, pallets and remotes
- similar color patterns
layer4-2035
human annotations
- a dog, a phone booth, fruit
- animals, electronics and fruit
- items that are connected
layer4-1883
human annotations
- a boy with a shovel, a water tower in a sunset, a hammer, a dog
- two items that are connected
- edges of objects
layer2-382
human annotations
- spots of the color white
- kid's face as the takes a drink from a water bottle, a football player tries to tackle another
- dogs and faces
layer2-223
human annotations
- the edge of objects
- the edges of objects
- person, sky, water tower, computer
layer4-36
human annotations
- dogs and camoflauged items
- dogs
- faces
layer4-451
human annotations
- animals and metal structures
- brown animals
- rounded edges in pictures
layer4-508
human annotations
- animals, fabric and smooth surfaces
- brown dogs
- items with angles
layer4-1515
human annotations
- the bodies and some faces of humans and some animals, including foxes, a dog, and a duck
- people
- living things
layer1-21
human annotations
- a hand bag
- fluorescent blue and purple objects
- logo, person, screen, food
layer2-207
human annotations
- spots of the color white and repeating parallel lines
- metal objects
- brighter areas in objects
layer3-487
human annotations
- rooftops of buildings
- things that look like umbrellas
- rounded edges in pictures
layer4-658
human annotations
- grass in the bottom of a photo
- grass or felt
- the color green
layer4-588
human annotations
- people playing string instruments
- ladders, fences, guitars and animal noses
- guitars
layer4-1667
human annotations
- left side of a court building, lizard, body of water
- textured area
- sign, structure, animal
layer4-171
human annotations
- poles ands stripes
- protruding, rectangular objects
- rounded edges in pictures
layer4-277
human annotations
- neck braces
- this region includes items that have curved areas
- chins of things
layer4-920
human annotations
- animals, trees, bricks and poles
- textured surfaces
- cliffs
layer4-1087
human annotations
- animals
- green leaves and plants
- animals, both on the ground and in the sky
layer3-273
human annotations
- glasses and beige colors
- lenses of a guy wearing glasses
- black sunglasses
layer2-478
human annotations
- areas on dials and signs
- lettering
- letters and written text
layer1-0
human annotations
- a cup of coffee, a car's wheel
- cups with different liquids, different mesh materials, a baseball player, dog and a bird and the attention in each photo is drawn to the areas that is reflecting the most light
- out of focus
layer1-219
human annotations
- several parts of fish, water, white coat on dog, dog faces, female nurse face, white i-shirt and rotary on telephone
- dots on points and eyes
- dogs and sharks
layer3-135
human annotations
- legs and cylinders
- necks of objects and people
- are the slim part of of dumbbell shaped items
layer3-684
human annotations
- mouths of animals
- curved edges
- noses of land animals
layer4-529
human annotations
- animals and carts
- textured areas
- body parts of living creatures
layer4-740
human annotations
- snakes and other reptiles
- a dog's snout, a harp, whale's pain, dogs in a photo, a snake
- animals, windows, bricks and harps
layer4-1849
human annotations
- nearly vertical lines formed by light and dark areas
- space a room in a mansion, field, trees
- similar color patterns
layer3-193
human annotations
- high points of a tower, a curtain in a theater
- arrows and pointed shapes
- person, sky, tower
layer1-38
human annotations
- a drum full of tennis balls
- words
- written text
layer4-71
human annotations
- animals
- seahorses and lizards
- long, thin items
layer3-154
human annotations
- noses of different dogs
- rounded snout-like area
- fur, feathers, numbers, letters or natural surfaces
layer4-820
human annotations
- backgrounds
- triangular shaped lines in them
- rounded edges in pictures
layer4-521
human annotations
layer3-279
human annotations
- face of a dishwashing machine
- locks and doorways
- the bottom parts of areas with writing on them
layer2-395
human annotations
- a statue outside
- curved areas of animals and clothes
- aquatic life
layer4-98
human annotations
- hands and benches
- human hands
- items with curves
layer3-621
human annotations
- sloped objects like animal backs and stairs
- backs of dogs
- car, window, stairs, quilt, building, cage, animal
layer4-720
human annotations
- balls, animals and circular objects
- ovals and round objects
- hands of people
layer4-710
human annotations
- ox, a truck, dog
- animals, trucks, and wooden objects
- items on other items
layer3-196
human annotations
- flower's on a clock
- the color blue
- the labels and logos are blue
layer2-432
human annotations
- points on a soccer ball
- black objects
- white and black shapes
layer3-137
human annotations
- the corners of rectangular objects
- corners of different objects
- building, pan, stand, building, ship in a bottle, tile
layer3-654
human annotations
- wheels and a bear nose
- wheels of vehicles
- car wheels
layer4-618
human annotations
- electronics, scales and furniture
- various colors and patterns of different objects
- similar color patterns
layer4-1705
human annotations
- a sign of a hotel, a tractor, a keyboard, a dog walking in the snow
- animals, vehicles, bridges, keys and fabric
- areas with multiple items that are similar
layer4-1853
human annotations
- faces, cameras, masks and objects that resemble them
- central objects
- pictures of animal
layer3-56
human annotations
- repeating dark lines
- the hoods and panels of cars, pillows, dog's ears, speakers on a a boombox, the top of a mailbox, and a dress
- places where people sit
layer4-427
human annotations
- black lines or squares that form a grid on a white background
- remotes, windows and signs
- contain items with straight lines
layer4-1510
human annotations
- carpet, dress, sign
- red objects
- the color red in them
layer3-360
human annotations
- the color black surrounded by a single color background
- letter like items in them
- letters and numbers and dots
layer3-1017
human annotations
- patches of skin or clothing
- faces
- orange areas in picture
layer3-687
human annotations
- spout or handle protrusions from a larger object
- edges of teapots and mugs
- rounded edges in pictures
layer4-610
human annotations
- ships, birds and vases
- objects composed of lines
- ships in the water
layer4-1101
human annotations
- a man hitting a gong, a feather pen on a table, birds on a branch
- curved objects
- round objects
layer4-1765
human annotations
- person doing acrobatics, mirror of a car, monkey on a tree, bird walking on the grass, satellite dish
- animals and poles
- a ridged pattern
layer3-340
human annotations
- lamps and other shiny objects
- lampshades and thimbles
- bells and lamps
layer1-252
human annotations
- sharks, or whales in the sea, a sea turtle, bottles of a bottle of wine, a owl on a tree branch, dogs in a pose for a picture
- outlines of letters, sticks, animals and bottles
- sharks
layer4-246
human annotations
- animals and a guitar pick
- dogs
- living things
layer3-651
human annotations
- animals and things with dots
- animals that have patterned fur
- a ridged or chain pattern
layer4-904
human annotations
- a bench someone is jumping over, a bin, a dog in a basket, a speaker at a podium two people speaking. furniture in a bedroom
- sticks or boards
- wood
layer4-1453
human annotations
- these include a long stick like object
- items that are long and thin
- stick like objects
layer4-269
human annotations
- objects with strong curves
- vehicles
- items that are curved
layer4-311
human annotations
- wooden objects and animals
- wooden objects
- rounded edges in pictures
layer4-1579
human annotations
- women's tank top, women and man at a beach, cake
- clothes, feathers and circular objects
- person, food, nature
layer4-1658
human annotations
- round
- round objects
- circular features
layer2-144
human annotations
- yellow or orange regions
- colorful striped objects
- orange areas in picture
layer2-175
human annotations
- small circular spots
- circular dots
- similar patterns
layer1-148
human annotations
- a shark's tooth
- black lettering on white backgrounds
- shark, logo, text
layer3-245
human annotations
- left side of a computer screen, space on a joystick, a women plays a harp, a toy in a cup
- these images all have rounded edges in common here
- specific patterns
layer4-121
human annotations
- animals and trucks
- seats of vehicles or peoples faces
- wild and tamed animals and people and cars
layer4-452
human annotations
- birds and porcelain items
- round, smooth objects
- food
layer4-836
human annotations
- animals and poles
- objects with sharp corners and appendages
- rounded edges in pictures
layer4-1815
human annotations
- trees in the background bridge, dog, person riding a unicycle, pavement
- areas with straight lines
- things outside
layer3-205
human annotations
- nose of a dog
- dog noses
- animal
layer3-385
human annotations
- single colors and parallel lines
- rounded objects
- brighter areas in objects
layer2-242
human annotations
- strings and legs
- thin lines in them
- similar patterns
layer4-576
human annotations
- lights and reflections
- human faces
- rounded objects
layer4-1162
human annotations
- dresses women are wearing, dogs posing for a photo, a lizard's torso
- animals and bells
- formal dresses
layer4-1083
human annotations
- cylinder shapes with many lines
- cylinders, people and buildings
- neck braces
layer2-161
human annotations
- spots of green and yellow
- the petals of the flowers are bright colors on both the real flowers and the maracas
- brighter areas in objects
layer4-1981
human annotations
- animals and food
- brown buckets and strawberries
- person, food, vehicle, nature
layer2-72
human annotations
- white colored spots
- african animals
- backgrounds in pictures
layer4-1149
human annotations
- animals, cookware and circular objects
- rounded objects
- vehicles and shoes and instruments and other products
layer4-300
human annotations
- animals and furniture
- objects with lines
- show sides of objects
layer4-1129
human annotations
- animals and glass containers
- bottles and dogs
- look like bottles
layer4-1139
human annotations
- to, tent
- buildings, vehicles and sails, and rocks
- two items that are connected
layer2-140
human annotations
- spots of the color white and edges surrounded by the color blue
- green and blue colored spots
- brighter areas in objects
layer1-138
human annotations
- a roasters feathers
- birds
- animal, food
layer2-486
human annotations
- bright colors
- contain a bit of red
- red areas in picture
layer3-614
human annotations
- the left side of animals
- white skin
- the parts of the right side of objects
layer3-645
human annotations
- circular objects and tails
- circular objects of many colors
- slots on them like a spatula
layer4-1227
human annotations
- something someone is holding or wearing
- tan objects
- a speckled pattern in them
layer4-2004
human annotations
- animals, clothes and things that look like mops
- grey, textured object
- grey
layer3-71
human annotations
- heads, eyes and other circles
- small red dots
- red objects
layer3-21
human annotations
- car doors and circles
- cars
- a line in them
layer3-746
human annotations
- areas above a circle
- hair and hats
- yellow areas in pictures
layer4-421
human annotations
- people and animals
- women's clothing
- bodies
layer4-1804
human annotations
- animal, green shirt
- items on other items
- animals, people
layer4-1970
human annotations
- dogs out on the snow, a cat on the grass, trash on a beach, the tail of a cheetah, bird on the ground
- animals, trash and random objects
- brown birds
layer3-967
human annotations
- clouds
- sunsets
- the sky around different subjects
layer4-1591
human annotations
- a frog, a dog, a spider, a bird
- animals
- black spiders
layer4-1538
human annotations
- cherries, a ladybug, pencils
- two similar items
- similar color patterns
layer3-324
human annotations
- black spots surrounded by white
- rims of a car, text on a picture, text of package or sign, projector, space long kitchen utensils
- grilles and vehicles
layer3-1014
human annotations
- edges of different objects
- the snouts of dogs and the corner of several different items
- rounded edge objects or dog noses
layer4-197
human annotations
- peaches, chins and handles
- woodwind instruments
- mouth region of animals or humans
layer2-448
human annotations
- grass and foliage
- outlines of a blurry background
- nature
layer2-159
human annotations
- objects radiating from the center
- round ceilings and greenery
- bright areas
layer4-192
human annotations
- brown objects
- red and amber objects
- rounded surfaces
layer3-710
human annotations
- animals and cylinders
- dogs
- several different types of long, cylindrical items and structures
layer4-1247
human annotations
- animals, balls and stripes
- eggs
- similar color patterns
layer4-1111
human annotations
- a star fish, hill, teddy bear, scarf, bird
- checks and dogs
- items that are connected
layer2-375
human annotations
- high contrast colors
- of the meeting of two colors
- wagon wheel, person, fruit, washer
layer3-302
human annotations
- a bird sits atop a ledge, nose of a dog, cats play on a sofa, someone holds a fish, a chair to a table
- objects with stripes or dots
- bird chests and dogs
layer3-140
human annotations
- animals outlines
- birds
- a brighter color
layer4-100
human annotations
- fruit, balls, and bins
- edges of squares
- pencil sharper, drawer, vegetable, nature
layer4-1010
human annotations
- vehicles, animals, windows and screens
- noses of people and animals
- person, food, vehicle, nature
layer4-1966
human annotations
- baseball on the field, butterfly on blades of grass, fence with an animal
- textured surfaces
- two items that are connected
layer2-479
human annotations
- spots of the color white and curvy lines
- a hot air balon, aquatic life, a lion, a golf ball
- textured areas
layer3-388
human annotations
- repeating curving lines
- clothing items, a women holding her dog, record of a hone, a bib
- coils and textured objects
layer3-819
human annotations
- areas around animals and circles
- little lines in them
- black, white, and brown regions
layer3-926
human annotations
- grey hued spots
- vehicles
- rounded edges in pictures
layer4-1437
human annotations
- face of a bird, sink, cabinet, flower
- objects with buttons
- animals, people
layer4-1388
human annotations
- red objects and insects
- baskets, vehicles, leather and bugs
- leather goods
layer3-292
human annotations
- the left ear of a monkey, a kid in a swing set, a backpack, a bouquet of flowers, a food dish, a whicker basket, kids clothes
- the sides of rounded objects and clothes
- hands and ears
layer2-132
human annotations
- dots outlining words, cars and circular objects
- objects with red
- the corners of items
layer3-823
human annotations
- letters and metal frames
- truss designs
- bottle, logo, sign, tower
layer4-1148
human annotations
- long stick like objects
- instruments
- areas or objects with straight lines
layer4-1348
human annotations
- objects forming multiple diagonal lines
- poles and nails
- skinny vertical lines
layer4-1564
human annotations
- a barrel, corners around a plate, a screw driver
- barrels, circular objects and paint
- cylindrical objects
conv1-40
human annotations
- my player bezel
- computer screens and small lines
- zebra, person, logo, text
layer2-222
human annotations
- small circular black objects
- eyes of birds
- a i like shape in them
layer4-532
human annotations
- objects with multiple lines and round areas
- animals and cylinders
- a screw design
layer4-1840
human annotations
- man's forehead with a bandaid, a parkman symbol on a shirt. a bird in a tree
- flowers and yellow objects
- bright yellow and pink colors adorn various objects and living organisms
layer1-83
human annotations
- dogs and bugs
- light colored parts of an object
- animal, flower, insect
layer3-22
human annotations
- clocks, circles and fruits
- circular objects
- clocks or look like clocks
layer3-779
human annotations
- poles, sticks and bows
- violins
- these things have a stick shape
layer4-1290
human annotations
- book shelf ina library, people laughing and celebrating, a desk near a bed, a headshot of a person, window of a building, a dog going through grass, part of a snake
- animals, shelves, pillows and water
- brown dogs
layer4-1074
human annotations
- space on the left side of a sign, dishwasher loading tray
- shaggy dogs
- sides
layer2-302
human annotations
- spots of the color blue
- a plane flys in the sky, a bird on a tree branch
- blue skies
layer2-206
human annotations
- lines on a red background
- red or orange color in them
- red areas in picture
layer3-462
human annotations
- grass backgrounds
- the edges of things next to hair or grass
- edges of objects
layer3-953
human annotations
- bears and dog faces
- dog eyes and cheeks
- dogs faces
layer4-796
human annotations
- soccer balls and faces of animals
- animals and balls
- soccer balls
layer4-1808
human annotations
- the tail of a lizard, a beach someone is waling on, shorts someone is wearing
- things shaped like a stick
- people, nature
layer4-1709
human annotations
- wheel shaped objects, and objects composed of lines
- it contains metal work
- items with curved features
layer3-269
human annotations
- the noses of different breeds of dogs
- the muzzle of a dog
- noses and mouths of animals
layer3-233
human annotations
- dogs and computer monitors
- gray or gold
- these all seem to have straight flat edges in them
layer3-793
human annotations
- reflective surfaces and animal heads
- vehicles
- sign, belt, vase, electronic, car
layer3-576
human annotations
- stripes, animals and a carafe
- dogs
- person, logo, candle, water tower
layer4-1056
human annotations
- a lizard, a dog in the grass, friends in a competition
- animals, towers and candles
- towers and tails
layer4-1491
human annotations
- a turtle swims in the water, a spider crawls down a log, a dog lays on the floor, a easter, a dog walks across the road, a hammer
- things sticking out, like legs
- lighter areas in pictures
layer3-337
human annotations
- a person's face, two animals making love, a person performing on a instrument
- hands or necks
- hands of people
layer3-48
human annotations
- noses of many dogs
- textured very different, yet they are all similar
- animals in pictures
layer3-826
human annotations
- pointing extremities
- cords, tails and beaks
- hassles and beaks
layer3-719
human annotations
- animals and household objects
- conical structures
- rounded edges in pictures
layer4-1123
human annotations
- a bird on a tree branch, a dump truck, a lizard on the rocks, a dog in the park
- animals
- animals, as well as a garbage truck
layer4-1440
human annotations
- lotion in a picture, graphic design on a package, a bird on a log, perfume, a women with a tattoo wearing a talkto
- fragrances
- two items that are connected
layer1-77
human annotations
- white areas on animals
- white clouds and sea animals
- some white spots
layer3-419
human annotations
- a birds beak, left of a church window, a dogs ears, maw of an animal
- light colored spots on animals ears and buildings
- face of animal
layer3-584
human annotations
- poles and animal legs
- birds
- a tube shape
layer3-917
human annotations
- screens and trucks
- computer monitors
- the bottoms of items
layer4-1549
human annotations
- toilet, food
- food, puzzles, and circular objects
- food, puzzle
layer4-1787
human annotations
- a bottle of water, a cup someone is holding, a kid is holding a hippie cup. a kid playing pingpong
- two items that are connected
- animal, person
layer2-126
human annotations
- space above the fence of a plant, barber shop poles, aquatic life, projected, a person standing on the beach
- blue areas and white skin
- specific patterns
layer2-430
human annotations
- spots on the top of a taxi cab
- dots on curved objects
- these spots are part one color and part another
layer4-353
human annotations
- animals and sticks
- bugs
- green areas in picture
layer4-130
human annotations
- people; hands and straight, white lines
- reflective surfaces
- these reports of rectangular objects
layer4-1643
human annotations
- a kid playing on a chain link fence, a truck going down a road, a old pho with tractors, a man making poetry
- animals, cookware and vehicles
- objects in the foreground of a black and white image
layer4-1001
human annotations
- animals, produce and furniture
- bugs
- people, bugs, insects, snakes, and vegetables
layer1-78
human annotations
- text on the back of a shirt, text on the front of a car, text on a front of a hat, between the spaces of a zebra
- black and white stripes
- patterns on objects
layer3-480
human annotations
- wings of birds
- the corner of rounded areas
- lighter areas
layer3-588
human annotations
- animal ears and shirts and mirror reflections
- dog ears
- ears on dogs
layer4-575
human annotations
- fences, containers and buildings
- objects with repeating lines
- building siding
layer4-1064
human annotations
- insects, a bird in the grass, a a dog posing for a picture, cows in a field
- animals and boats
- black and white patterns
layer3-365
human annotations
- dogs going a certain direction, a chicken
- fur
- places with fur
layer3-386
human annotations
- white area above an image's focus
- backgrounds around the object
- dogs and other animals
layer4-226
human annotations
- animals and circular objects
- tires
- hands and wrists of people working on things
layer3-682
human annotations
- bird and lizard heads
- lizard eyes
- lizards
layer4-1467
human annotations
- ballons by a door, a vase, toilet paper, a chainlink fence, nails
- small balls
- rounded items
layer4-1641
human annotations
- weights, barrel, a sign
- weights, dogs and ceramics
- two items together
layer1-50
human annotations
- a dog in the pavement, a bunny through a cage, an hourglass on a flat surface, sharks in the water, a volleyball, a cat wearing ears
- lines outlining a object
- words and accents on different objects
layer3-1009
human annotations
- bodies of bugs and other round objects
- bugs and pearls that are shiny in nature
- round things
layer4-47
human annotations
- people and animals
- shoulders of humans
- rounded edges in pictures
layer3-959
human annotations
- areas around the object
- neck braces
- the background of main objects
layer4-639
human annotations
- objects sitting on the ground
- animals, bowls and wheels
- items that are rounded
layer4-1757
human annotations
- women's shirt, women serving food, women's shirt, kid, cartoon on a magazine, man next to toilet paper
- people
- white robes
layer4-1931
human annotations
- objects that are red
- red and black cushions and animals
- red areas in picture
layer2-334
human annotations
- text on a package of paper tools
- diagonal and curved lines outlining a object
- logo, animal, food
layer1-225
human annotations
- dots outlining objects
- red and black lettering
- bottom loops of text
layer3-1023
human annotations
- patches of white
- spots of the color white
- human faces
layer4-227
human annotations
- hands
- hands of humans
- person, hand, bottle, food, animal
layer4-821
human annotations
- vehicles and balls
- object with round edges
- below objects
layer4-682
human annotations
- crowds
- people and penguins
- people and penguins
layer4-1735
human annotations
- a spider, left side of a tree, a beetle on therans, a zebra's ear
- textured areas
- sides
layer3-283
human annotations
- horns of animals
- horns of animals
- the face
layer3-23
human annotations
- beaks and eyes of birds
- eyes of different birds
- bird eyes
layer3-810
human annotations
- people, fruit and furniture
- shaggy brown dogs
- insect, animal, food, fruit, mountain
layer4-282
human annotations
- animals, arches and vehicles
- curved hooks
- tie, lock, hair dryer, saw, structure
layer4-1320
human annotations
- birds and pale backgrounds
- birds on the snow, person writing text on a sign, monkey
- white objects and backgrounds
layer4-1619
human annotations
- farm house, window, pill tablets
- animals, buildings and poles
- items with straight features
layer3-230
human annotations
- the lovely faces of dogs
- animal eyes
- eyes
layer3-984
human annotations
- objects with many stripes
- radiator, person, hand, hair, cologne
- similar patterns
layer4-35
human annotations
- roofs and balls
- eggs
- balls or a diagonal line
layer4-1152
human annotations
- animals and cords
- necks and string material
- circular items
layer4-674
human annotations
- a keychain, a pistol in a holster, a spear that went through a shark's mouth, bracelet around a dog's neck
- keychain, leashes and firearms
- chains
layer4-2009
human annotations
- thumb ,sapce around a bird, thumb, fox fur
- curved items
- animal, nature, person
layer3-210
human annotations
- a shirt of a women wearing a blouse, a design on a cup, a person with binoculars, a person with a camera
- have orange in them
- the people have collars on their shirts
layer2-213
human annotations
- green scales
- grass and fences
- green grass
layer2-268
human annotations
- repeating grid and honeycomb patterns
- objects that have holes in them
- honeycomb-like areas
layer4-1248
human annotations
- a ad player, a dog, a monkey, a tablet, a remote control
- animals, electronics and bells
- objects containing brown and grey
layer4-1272
human annotations
- a ballon, food someone is eathing, a dog a girl is holding, a vase, a plant
- areas with brown hues
- similar color patterns
layer4-1799
human annotations
- a bowl on the beach, a bird, an insect, a face of adog. a pot of food
- round or curved objects
- the center of items
layer1-136
human annotations
- a speedometer, a guitar pick in some string, kid plays baseball, adog, a bonded shack, a typewriter
- animal, gauge
- face of the people
layer3-95
human annotations
- dog noses
- animal noses or spindles
- rods and people holding them
layer3-540
human annotations
- circles and beaks
- round tops of objects
- jewelry, fruit, food, fish, flag, grass
layer4-551
human annotations
- wooden objects, animals, vehicles, and produce
- people and animal body parts
- beans, go kart, animal, desk, ship
layer4-1006
human annotations
- beauty products, electronics and benches
- white, rectangular objects
- white objects
layer4-1796
human annotations
- animals and circular objects
- animals and a couple people
- areas with curved items
layer2-209
human annotations
- green areas on an object or animal
- red tops of birds
- red areas in picture
layer2-196
human annotations
- spots of the color white
- pale areas of subjects background
- brown dogs
layer3-958
human annotations
- the striped parts of animals
- yellow butterflies
- similar patterns
layer3-937
human annotations
- the areas above a animal
- area above an animal
- grassy areas
layer4-1810
human annotations
- objects with pointed features
- show faces
- front of objects
layer4-1134
human annotations
- formation, food, bird
- food, grass, rocks and buses
- the edges of items
layer1-9
human annotations
- letters a atop a bakery sign
- black and white lines
- pieces of white on striped areas
layer1-143
human annotations
- a wine glass, a dog riding a ride meant for a kid
- text
- words and letters
layer3-593
human annotations
- outlines of vertical objects
- the sides of rectangular objects
- edges of objects
layer4-66
human annotations
- animals and lights
- objects that resemble faces
- dogs
layer4-636
human annotations
- man's shirt, kid and his dog, women, two women sitting in a car
- human faces
- fronts
layer4-1014
human annotations
- pink items and chairs
- {these are people, balls and furniture
- brown chairs
layer4-1932
human annotations
- animals, bench
- animals and furniture
- regions above or below objects
layer2-349
human annotations
layer3-282
human annotations
- dogs in the grass, a kid on a bench
- dogs and bugs
- the top side of an animal that is crawling aound
layer4-80
human annotations
- trees, words and animals
- ears of fluffy dogs
- lined objects that move towards a center
layer4-188
human annotations
- animals and spherical objects
- trees
- animal and immediate vicinity
layer4-1191
human annotations
- animals and things with legs
- objects and backgrounds with lines
- things that are slated like an open chair back
layer4-1254
human annotations
- a man holding barons, a man holding a guitar, a man lifting weights, a man holding an axe,bolts
- circular objects
- items with rounded features
layer2-460
human annotations
- a lock around a chainlink fence
- flowers and blue skies
- brighter areas in objects
layer4-556
human annotations
- animals, plants and fences
- green plants
- on or around long, straight items
layer3-666
human annotations
- stripes
- screws of different objects
- a variety of threaded objects and a necktie, coat sleeve, and creepy face
layer4-1601
human annotations
- a sewing machine, a
- wooden objects and food
- the regions have items with curves
layer4-1847
human annotations
- a sign with text, a bird in the background, a remote in hands, a crossword a kid is attempting
- items with corners
- rounded edges in pictures
layer3-5
human annotations
- space above a dogs head, space on the left and right side of a dog
- windows and edges of squares
- brighter areas in objects
conv1-5
human annotations
- a gas gage and fuel gage, a butterfly
- pizza, gauge, flower, pinwheel
- colourful a 3 i picture
layer3-396
human annotations
- the chest and torsos of people
- clothing being worn by people
- articles of clothing
layer3-514
human annotations
- objects that are red
- chairs
- red areas in picture
layer4-489
human annotations
- people who are indoors and white
- people
- drinks
layer4-486
human annotations
- animals and food
- textured surfaces
- spiders
layer4-1623
human annotations
- animals
- animals
- items with long, thin features
layer4-1832
human annotations
- a bird on the shelf, a snake in the grass, a dog in the grass, a car
- boxes and animals
- angles
layer3-445
human annotations
- people playing string instruments
- guitars and banjos
- front of objects
layer3-948
human annotations
- dots and towers and crosses
- skinny lines
- small objects
layer3-688
human annotations
- buoys in water, text on sunscreen, shampoo
- round, cylindrical, objects
- designs
layer2-55
human annotations
- green backgrounds behind animals
- curvatures on different animals
- green areas in picture
layer3-406
human annotations
- chains, steel and hands
- contain joints
- specific patterns
layer4-781
human annotations
- water, the sky, and the ground
- ocean water
- rounded edges in pictures
layer4-676
human annotations
- animals with fur
- animals
- brown dogs
layer4-2021
human annotations
- cups handle, a dog, a saxophone, shorts a person is wearing
- instruments, dogs, handles and clothes
- the sides of objects
layer3-262
human annotations
- a bird that sit's on a branch
- blue, red, and green objects
- colorful birds and red dots
layer4-79
human annotations
- curved objects and corners
- hands and fingers and ears and body parts
- clothing, scenery, nature
layer4-1292
human annotations
- orange animals and insects
- animals and carts
- brown dogs
layer2-370
human annotations
- dots out lining lights or corners of objects
- faces and feet
- plant, animal, person, fence
layer3-2
human annotations
- shark fins and screws
- the connection between a long tube and around area
- stems of objects
layer3-519
human annotations
- dogs
- bottle, animal, white background, food
- the pools balls and dragon fruits are in bunches
layer4-765
human annotations
- round fruits and vegetables
- fruit and objects that resemble it
- small red fruits
layer4-685
human annotations
- objects that are red, white, brown or orange
- knit, wooden, and metal objects
- musical instruments
layer4-1959
human annotations
- small animals and people wearing hats
- animals, food, clothes and legs
- crabs and hats
layer1-236
human annotations
- stripes of an airplane, stripes on a hat, grill of a semi, dog's toy
- red and blue objects
- red clothing items
layer3-870
human annotations
- animal heads
- animal necks
- ears of dogs
layer4-1293
human annotations
- animals, vehicles and wooden objects
- vehicles, structures and animals
- brown dogs
conv1-24
human annotations
- speedometer
- white background areas
- white areas
layer3-384
human annotations
- green spots
- black animals
- green areas in picture
layer3-1019
human annotations
- round objects in between clocks and other items
- lights and circles
- clocks and heads
layer3-924
human annotations
- eyes and ruffled objects
- a swirl in them like a fingerprint
- animal, food, curtain, spider web, flower
layer4-1498
human annotations
- a musician, a snake, a dog, a person shooting a gun
- animals, plants and firearms
- multiple items that are similar
layer4-1381
human annotations
- people and animals in the wild
- people, animals and hooks
- objects with curved edges
layer1-176
human annotations
- space on the front of a grill of a really old truck
- texture lines
- nature, people, structure, car, letters
layer3-436
human annotations
- grilles on vehicles
- crease lines on different objects
- logos, grill, table
layer3-605
human annotations
- white objects and backgrounds
- white tops
- golf ball, roof, sky
layer4-808
human annotations
- animals
- dark dogs
- things outside
layer4-1287
human annotations
- people
- humans and human arms
- human hands and chins
layer3-438
human annotations
- circles with indents
- the corners of rounded things
- white features
layer3-227
human annotations
- a person's shirt
- fabric and animals
- nature, clothing
layer2-459
human annotations
- red and orange boundaries
- yellow or orange areas
- orange areas in picture
layer4-148
human annotations
- mammals and circular objects
- rounded objects
- circular objects
layer3-898
human annotations
layer4-1212
human annotations
- animals, boxes and drums
- area of negative space around an object
- human hands
layer4-1956
human annotations
- animals and circular objects
- circles
- wheels as well as dumbbells and barbells
layer1-160
human annotations
- animals outside
- ocean water and animals
- water, animal, clothing, table
layer2-503
human annotations
- dots outlining a object
- human hands and land animals
- similar patterns
layer3-617
human annotations
- round objects
- heads of people and animals
- circular areas in them
layer4-272
human annotations
- animals
- paws of different animals
- person, ship, animal
layer4-1238
human annotations
- animals and bridges
- animal faces
- animals
layer4-1040
human annotations
- wooden objects with holes
- hands, handles and poles
- objects with holes
layer2-389
human annotations
- rope going on the side of a boat
- the outline of the background
- the edge of bluescreen areas
layer1-36
human annotations
- vents on top of an alarm clock
- complicated repeating patterns
- tennis balls, clock, instrument, person
layer3-777
human annotations
- light reflections
- circular objects
- rounded and shiny
layer3-616
human annotations
- differences in animal fur color
- black and white areas on animals
- patterns on animals
layer4-1211
human annotations
- animals and furniture
- textured objects
- black dogs
layer4-704
human annotations
- people, water, and furniture
- people holding onto saws
- appendages in them
layer2-372
human annotations
- turquoise and khaki
- space below a sign
- small areas that contain half and half of different colors
layer1-170
human annotations
- melons in a basket
- multiple colors, shapes, and textures here
- similar patterns
layer4-19
human annotations
- the wheels of automobiles
- the front of cars
- vehicles
layer4-119
human annotations
- objects found in the rightist position of the image
- rounded objects
- machines used by people and some animals displayed
layer4-837
human annotations
- circular objects and faces
- round objects and faces
- rounded items
layer4-1851
human annotations
- area with red or yellow hues
- items with straight features
- yellow areas in pictures
layer2-348
human annotations
- berries on a branch where a bird is, the frame of a bike
- red colors and bike
- a red colored piece of a larger item
layer3-300
human annotations
- striped objects
- multicolored striped round objects
- a rainbow of color
layer3-119
human annotations
- ears, arms, handles and cords
- dog ears
- body parts dangling off sides of head or body
layer4-159
human annotations
- animals and circular objects
- pale areas adjacent to dark objects
- brown animals
layer4-970
human annotations
- fences
- black fences
- wire criss cross frames
layer4-1404
human annotations
- left side of an owl's feathers, bird on a branch, fur of a dog
- areas with green and brown hues
- birds and dogs
layer4-1898
human annotations
- faces of people or animals, insects
- scorpion shaped
- areas with living things
layer1-220
human annotations
- a dog laying down, a glock of birds in the sky, pictures on a refrigerator
- black lettering and black dots
- outlines of darker areas
layer3-81
human annotations
- objects in a white background
- metal objects
- long items
layer3-662
human annotations
- rounded objects
- small dots and white skins
- rounded edges in pictures
layer3-755
human annotations
- hands and objects that resemble them
- light articles of clothing
- hands or paws in them
layer4-866
human annotations
- animals and people
- human necks
- heads
layer4-1814
human annotations
- a shovel, a person smelling something, a snake
- items with straight lines
- things outside
layer1-1
human annotations
- animals posing for a photo
- nature
- corner of pictured animals
layer2-107
human annotations
- points of a shirt, socks of a shoe a person playing tennis, a person enjoying the beach
- red objects and clothing
- brighter areas in objects
layer3-494
human annotations
- animals and mics
- dog accessories
- things made out of metal
layer3-865
human annotations
- heads, keys and stripes
- sides of vehicles
- body parts and vehicle parts
layer4-1223
human annotations
- animals and cylinders
- people and animals
- faces of humans
layer4-2014
human annotations
- a dog walking in the grass, a plant, a bird in the grass, a keyboard
- animals and canopies
- two items that are connected
layer4-1906
human annotations
- a bird in the grass. a duck in the water. a person playing violin
- living things
- rounded edges in pictures
layer2-381
human annotations
- bits of light colored areas
- fencing, animal
- random parts of patterns
layer2-324
human annotations
- a chainlink fence, guinea pigs, people playin basket ball
- red lettering and lips
- person, usa logo
layer4-99
human annotations
- walkways and animals
- blue skies and walkways
- paths or elongated objects
layer3-108
human annotations
- edges of vehicles and animals
- dots on corners of vehicles of animals or metal
- sides and corners of vehicles and animals
layer4-1219
human annotations
- animals mostly underwater
- textured objects backgrounds in nature
- the ocean and aquatic life
layer4-982
human annotations
- lights
- objects with red hues
- tan objects
layer4-1854
human annotations
- kid wearing sunglasses, kid and her camera, dog, monkey, women and her microphone
- items with openings
- pictures of animal
layer1-132
human annotations
- spots of the color white
- aquatic life, a ferret in a cage, a text around a sign, keys on a piano
- colored lettering
layer4-222
human annotations
- people holding things and animals
- people playing musical instruments, and dogs
- this region shows two items that are connected
layer3-640
human annotations
- heads of people wearing hats
- hates and helmets
- heads wearing hats
layer4-692
human annotations
- red lines and objects
- red and blue items
- objects with red and blue
layer4-1115
human annotations
- objects near bodies of water
- a lighthouse in the distance, a a person on an boat, a person throwing a fishing pole, a bridge in distance
- areas near water and circular objects
layer3-468
human annotations
- circles and repeating parallel lines
- handles on instruments
- rounded edges in pictures
layer2-185
human annotations
- pale spots around dark object
- small cylinders
- lighter areas
layer4-444
human annotations
- fence shaped items
- fencing
- vertical line patterns
layer3-730
human annotations
- animals and metal objects
- symmetrical areas
- bridge, person, lawn mower, insect
layer4-1645
human annotations
- golf cart, goats in a field, dog, giant spider, left side of a face.
- red objects
- animal
layer4-1638
human annotations
- a dog walking in the grass, a bird on a branch, a snake
- animals and objects that resemble them
- living things
layer3-423
human annotations
- underside of an animal
- the jaws and hips of various dogs
- animals in pictures
layer3-73
human annotations
- orange objects surrounded by blue
- floral decals
- colorful areas
layer4-1201
human annotations
- animals and flat reflective surfaces
- three dimensional surface
- bathroom sinks
layer3-735
human annotations
- the sky and walls
- skies
- blue sky and white walls
layer4-1463
human annotations
- wall, arm, ballon, tennis ball
- red and blue colored objects
- animal, nature, wall, person
layer4-1461
human annotations
- a ship, faces of dogs, a beach, a light pole
- dogs, buildings, beaches and ships
- multiple items that are similar
layer3-168
human annotations
- birds walk along the grass, a seal on the floor, a garden, a person holding up a fish, a group of cars
- shadows
- the shadows on the concrete are partly obscure
layer3-549
human annotations
- cylinders and curved lines
- rooftops of buildings
- they edges of roofs or items that are round
layer3-8
human annotations
- the noses of dogs, computer screens and duck feet
- birds, dogs and computer screens
- animal bodies
layer4-600
human annotations
- things with lens flares
- objects with tan hues
- round objects and roofing
layer4-375
human annotations
- outlines of animals
- brown dogs
- on the sides of objects
layer4-1872
human annotations
- people, animals and rocks
- items that are connected
- similar color patterns
layer4-1494
human annotations
- satellite dish, bridge, fowers, monument, kid
- bridges and towers
- animals, people, structures
layer2-287
human annotations
- spots of the color white and orange
- a guitar players pick
- things that are striated
layer3-97
human annotations
- animal fur
- spots of fur on animals
- animal parts mostly legs
layer3-524
human annotations
- i shaped lines
- assorted items that are all long and thin
- multiple lines in them
layer4-554
human annotations
- animals and cookware
- brown dogs
- cat, insect, dog
layer4-516
human annotations
- switches, poles and windows
- switches, knobs and openings
- light switches
layer3-261
human annotations
- a cowboy stand on grass left and right side of the man
- colored skies and seating
- areas with a line through it
layer1-239
human annotations
- shares in an ocean, a fish in the water, a bird walking across the water
- white splotches on animals
- parts of spotted things
layer4-164
human annotations
- cases, birds, pens and vertical structures
- birds
- person, sign, food, nature
layer3-712
human annotations
- lines intersecting an object
- animals and things with rims
- eyes of farm animals and hands
layer4-1222
human annotations
- animals, boats and railings
- brown objects
- brown dogs
layer4-1574
human annotations
- snake, gazelle, dog's snout, text on a box
- objects with curves
- snakes
layer4-267
human annotations
- animals and coils
- sea creatures, and various textured surfaces
- food, chain, crab, ocean, rock
layer4-127
human annotations
- poles, animals and tube shaped objects
- areas that contain lines
- birds and other land animals
layer4-927
human annotations
- animals
- textured objects
- sea creatures
layer4-690
human annotations
- a fox out in the wild, birds, a gator torso
- animals, poles and mushrooms
- white birds
layer2-490
human annotations
- faces
- the edge of rounded things
- edges of objects
layer1-75
human annotations
- snakes, sea life, space above water, birds, trees
- blue and green in nature
- spots of white and green grass and water
layer1-66
human annotations
- golden colors
- the color yellow
- text on speedometer
layer1-47
human annotations
- color orange
- a dog walking down a plank
- orange objects with stripes
layer3-792
human annotations
- bottles and legs
- bottles
- bottle, insect, sky, water bottle
layer4-186
human annotations
- balls
- green and yellow balls
- round items in them
layer4-830
human annotations
- human hands
- items that are connected
- pictures of food
layer4-1311
human annotations
- flowers and potted plants
- plants and fences
- areas with lines
layer4-1712
human annotations
- a beetle on the sand, a car going down the beach, a plant in the shade, a goat on a rock
- areas with red or yellow hue
- items that are connected
layer3-177
human annotations
- dog collars and hooks
- metal items
- objects with i type curves
layer3-4
human annotations
- circular objects
- spirals and round objects
- rounded edges in pictures
layer4-24
human annotations
- sticks
- faces of humans
- faces and similar things
layer4-514
human annotations
- balls, grills and plates
- balls and rounded objects
- soccer balls
layer4-2007
human annotations
- monkeys on the ground, mop, counter top ,bottle, neck of a guitar
- orange objects
- orange objects
layer2-338
human annotations
- birds fly in the sky, tree branches around power lines
- lines outlining a animal
- white fur and blue skies
layer3-554
human annotations
- animal noses and curved objects
- noses of different dogs
- snouts of dogs and posts of several different household items
layer3-1001
human annotations
- limbs of creatures
- animal legs
- legs of black bugs and birds
layer4-517
human annotations
- ships, boxes and animals
- ships on the ocean
- rounded or have something sticking up
layer3-750
human annotations
- the body of something that is at an angle
- wings and objects that resemble them
- this region contains the body of an object
layer4-1886
human annotations
- skirt, man wearing a dress
- fabric and objects that resemble it
- have designs
layer4-1873
human annotations
- a man wearing pants, a man in thewater, a man with his jacket
- people
- items and their backgrounds
layer1-218
human annotations
- white backgrounds and black text
- black and white lettering
- some of the areas between lines
layer1-232
human annotations
- speedometer of a car
- the top half of an image
- above objects
layer4-110
human annotations
- appliances and animals
- the dark space on an object
- microwaves and dogs
layer3-660
human annotations
- the are people sitting
- human legs
- person
layer4-1977
human annotations
- circular objects and stripes
- round objects
- person, animal, food
layer4-1378
human annotations
- fruit, snake, graffiti text
- snakes and circular objects
- people, nature, food
layer3-372
human annotations
- objects and animals with black dots or holes
- black dots on various backgrounds
- eyes and things that have holes
layer3-410
human annotations
- center of clocks
- clocks
- clock, roof, person, mask, watch
layer4-552
human annotations
- poles, spikes and antenna
- stitching and chains
- similar color patterns
layer4-1184
human annotations
- pens shaped things
- cylinders
- poles and bats
layer4-1119
human annotations
- semi truck, trumpet, ship on the water
- torches, poles and vertical lines
- items with straight lines
layer4-1603
human annotations
- a man holding a package, a city block, a boat, a horse pulling a wagon, the left and right side of someone in a jacket
- snow and roads
- white or grey colored ground
layer2-481
human annotations
- tail end of a rooster, the front of a shop
- dots on shiny areas
- brown animals
layer2-508
human annotations
- hourglass, a watchtower, a firetruck, a pick in strings of a guitar, crain support beam
- cranes and bridges
- negative space around patterns
layer3-690
human annotations
- poles and things shaped like pens
- birds
- plant, needle, hot air balloon, animal, oar
layer3-679
human annotations
- dots
- pale areas
- screws of objects
layer4-2020
human annotations
- animals, nails, and things with legs
- people
- edges of objects
layer2-314
human annotations
- a birthday cake, a section of paint of an orange beautiful truck
- nature, people, structure
- the food and animals have spots
layer3-422
human annotations
- fences and diagonal lines
- a wide color band on them
- similar patterns
layer2-234
human annotations
- lines intersecting a background
- pale areas above or below darker lines
- dots
layer3-715
human annotations
- circular and bulbous objects
- metal objects and accessories
- colorful areas
layer4-668
human annotations
- animals, towers and fences
- textured surfaces
- brown animals
layer4-1116
human annotations
- flute, person holding a knife, hippo, one
- electronics and long stick objects
- metal instruments
layer2-99
human annotations
- spots of the color yellow
- colorful dots and regions
- orange areas in picture
layer4-135
human annotations
- containers for cooking and holding liquid and small objects
- bottles, calls and woks
- metal objects
layer3-882
human annotations
- blue skies and birds
- above objects
- nature
layer4-662
human annotations
layer4-1315
human annotations
- insect, person holding a microphone, person holding a snake, lizard, glass
- people, bottles and mics
- insect
layer2-426
human annotations
- spots of the color white
- tiles on a ceiling
- windows and animals
layer2-56
human annotations
- area where an object or pattern ends
- dogs
- ear area of an animal
layer3-623
human annotations
- circular objects
- area near cheekbone
- plaid and feather looking items on people and animals
layer3-902
human annotations
- people
- human faces
- person, animal, statue
layer4-969
human annotations
- animals and handles
- objects with legs or columns
- people, nature, water tower
layer4-1099
human annotations
- a kid playing on a drain, food, right side of a kid
- areas with lines
- person, food
layer1-60
human annotations
- white and black lettering
- text, logo
- words labeling the posters and logo promotional items
layer4-9
human annotations
- curved and swirled lines
- hair of animals and humans
- people's hands holding small things
layer3-809
human annotations
- skirts and animal ears
- dog ears
- ears of animals and humans
layer4-762
human annotations
- hats, animals, and white objects
- white objects
- hats
layer4-1711
human annotations
- a tray in a xbox, a lock on a page, a mouse on a desk, a canyon, cup
- donut shaped
- items with rounded features
layer4-1876
human annotations
- a cannon, a dog laying down, a lobster, a donkey
- dogs
- faces
layer2-11
human annotations
- aquatic life, text on the front of a box of colonel, keys on the front of a keyboard, a horse posing for a photo
- the space above words
- like colored areas under dark ones
layer3-987
human annotations
- curved edges and reflective surfaces
- curved rounded edges
- rounded corners
layer4-259
human annotations
layer4-321
human annotations
- things with dots and grates
- textured surfaces
- patterned fabric
layer4-926
human annotations
- spiky and prickly objects
- plants and animals
- textured areas
layer4-1819
human annotations
- a man pointing a camera, a tower, a person holding a drill, a head of lettuce
- round objects
- two items that are connected
layer2-344
human annotations
- letter's of a license plate, windows on a two story building
- sign, window, numbers, animals
- the animals and bugs are all outside enjoying nature
layer3-334
human annotations
- elephant holding another elephants trunk
- background surrounding object
- backgrounds in pictures
layer3-85
human annotations
- straight vehicle lines in front of a background
- vertical, narrow structures
- metal poles
layer3-705
human annotations
- the area around animals and furniture
- fluffy animals
- nature
layer4-763
human annotations
- animals tables and food
- human hands
- similar patterns
layer4-1407
human annotations
- animals, legs, sticks and toys
- the sides of objects
- rounded edges in pictures
layer4-1867
human annotations
- a polar bear, a welcome mat, pets
- above and below objects
- lighter areas in pictures
layer2-9
human annotations
- a swan's neck, a person standing near the ocean, a tiger an armadillo, a shark in the water
- pale spots and highlights
- sharks
layer2-371
human annotations
- a cowboy hat, flowers on these of a road
- part of red or green things
- the colors red and green
layer3-663
human annotations
- bugs
- black bugs and creatures
- insect
layer3-518
human annotations
- animal noses
- mouth or hands
- animal, person, clothing
layer4-1138
human annotations
- a woman's shoulder. rows of crops in field, woman drinking coffee, meat with vegetables, automatic rifle, river, pink feathers, rooster, man hiking, man staring ahead, fox, boy holding large fish, mushroom, woman arm swimming, woman playing tennis
- person, animal. body of water
- the edges of items
layer4-702
human annotations
- snakes and curved lines
- things shaped like snakes
- snakes that are brown
layer1-162
human annotations
- animal behind a chainlink fence, a color of a dog, a owl sitting a top a branch, branches of a tree bearing fruit, dogs ears
- the borders of objects
- small details on animals and people
layer1-249
human annotations
- flocks of birds in a sky, a fire fly, ,a shark in the ocean
- the right side outline of objects
- lighter areas
layer3-570
human annotations
- the widest part of an object
- lawn mowers
- cup shaped or have two lines
layer4-228
human annotations
- animals, towers and things with handles
- mouths of dogs
- animal, building, animal, tower, dogs, bottle
layer4-1045
human annotations
- dog, a restaurant, photos and stamps, a supermarket store
- yellow and brown objects
- areas with yellow and brown hues
layer2-8
human annotations
- lines that are around forty five degrees
- a musician, people pose in costum, a blender, a kid in a bathtub
- edges of objects
layer3-473
human annotations
- scales that are on various animals like fish and frogs
- skin/surface
- the spot where creases in the animal or object start
layer4-348
human annotations
- bricks, trees, and cylindrical items
- human faces
- neck areas of objects and humans
layer3-765
human annotations
- roofs and caps
- objects with lines or dots
- rooftops
layer4-1136
human annotations
- curved or round objects in an environment
- balls and animals
- rounded features
layer4-1713
human annotations
- food
- rounded objects
- brighter areas on objects
layer2-343
human annotations
- bead of a necklace, tree, spider web space inbetween a hot air alone, forms of transportation
- pieces of the edges of things
- person, bike, helmet
layer2-396
human annotations
- bleacher seats
- white stripes and beads
- black and white stripes of color
layer3-82
human annotations
- things with legs or handles
- handles of locks and bags
- rounded edges in pictures
layer4-116
human annotations
- the grass and flooring
- areas of greenery
- nature, animal, person
layer4-1146
human annotations
- animals and doors
- brown and black animals
- animals paws area
layer4-1303
human annotations
- bird on therans, snake ,someone holding a camera, smiling kid
- striped objects and animals
- stripes
layer4-1864
human annotations
- faces of people
- area with lines or texture
- items with straight lines
layer1-44
human annotations
- spots of the color white
- a basket of fruit, left of a waterway where there is rocks
- little pieces of light colored areas
layer3-391
human annotations
- desert food and lines with gaps between
- spiral designs on objects
- layers of objects
layer3-785
human annotations
- animals, rims, and handles
- stripe-like patterns on objects
- edges of rounded objects
layer3-905
human annotations
- wheels of a truck, random parts of a tractor, same around a mans head
- wheels
- wheels of vehicles
layer4-1220
human annotations
- circular objects
- containers
- items that have curves on them
layer4-1611
human annotations
- threads on a baseball, a bird on the grass. a lizard
- animals, balls, and rocks
- fossils and animals, as well as laces of a baseball
layer2-16
human annotations
- holes and dots
- black spotted objects
- spotted areas in pictures
layer2-127
human annotations
- spots of the color white and edges of objects
- tan clothing and accessories
- similar patterns
layer3-914
human annotations
- red and green items
- spaces in between objects
- numbers, needle, animal, insect, smoke
layer3-714
human annotations
- animals with legs and peaks
- the hard part of a bird without feathers on it
- birds
layer4-1332
human annotations
- sign of a restuarant, hog, theater sign, dog
- animals and signs
- brown land animals
layer4-1051
human annotations
- flying insects
- a dog in the park, a fly on a tennis ball, a fly, a person hand feeding a dog
- animal, insect
layer3-320
human annotations
- bodies of insects
- bugs, snakes and other animals or pens
- similar patterns
layer2-162
human annotations
- spots of the color white
- dots on the sides of circles
- things that can be touched
layer3-632
human annotations
- flowers
- red florals
- flowers
layer4-284
human annotations
- faces and bodies of people
- body parts
- human hands and instruments
layer4-1417
human annotations
- animals, furniture, and hallways
- textured areas
- faces of dogs
layer4-1668
human annotations
- hour glass, frog, bridge, guitar picks
- objects that are similar to one another
- gaps in pictures
layer3-442
human annotations
- animal collars
- dog tags
- the dogs' collars have a tag hanging from them
layer4-22
human annotations
- dogs and soft clothing
- objects with fur
- dog and pet fur and humans hair
layer4-1145
human annotations
- animals, furniture and musical instruments
- tops of different meshed objects
- regions with areas with straight lines
layer4-589
human annotations
- fences and doors
- protruding, vertical objects
- fencing material
layer4-1613
human annotations
- a kid walking down the hallway, a shovel, a house in the distance, people in a cave, water
- areas of light
- areas with straight lines
layer4-1927
human annotations
- people, lizard, chain link fence
- hands and chains
- two items that are connected
layer2-347
human annotations
- numbers on a phone, a train going down the tracks
- number buttons and bottles
- the color green
layer3-183
human annotations
- a women holds a frog
- white striped things
- person, handbag, water, headphone
layer4-8
human annotations
- animals and brown lines
- brown, red or green things
- red areas in picture
layer3-509
human annotations
- colored balls
- balls, mainly athletic ones
- round objects near other objects
layer4-637
human annotations
- wooden objects and animals
- brown objects
- person, insect, vehicle, nature
layer4-890
human annotations
- these ae black animals, trees and plaques
- surfaces with dark lines
- brown dogs
layer4-1896
human annotations
- women in shorts, woman on grass, dog, go cart, man in skirt
- torsos for both animals and humans
- items with angles
layer4-1904
human annotations
- a dog through a chainlink sense, a bird, left of a man
- plants and plaques
- edges of objects
layer1-95
human annotations
- clocks ring
- round objects with lettering
- yellow clock
layer3-853
human annotations
- animals, signs and cookware
- shadows
- around a central item
layer4-918
human annotations
- animals fences and striped objects
- areas with patterns
- striped objects
layer1-223
human annotations
- spots of the color white
- small electronic devices
- liquids and electronics
layer2-236
human annotations
- tips of objects surrounded by blue
- blue and yellow objects
- airplanes
layer3-821
human annotations
- bird and other animal heads
- textured areas
- brown birds
layer4-757
human annotations
- pants, animals and sticks
- jeans and jean shorts
- pants on people
layer4-1973
human annotations
- the side of a house, a pond of water
- reflective surfaces
- textured items
layer2-452
human annotations
- eyes, ears, and other appendages
- the borders of the tops of items
- rounded edges in pictures
layer2-317
human annotations
- shoes in a row, a peacock
- animal, shoes, lanyard
- the pups have bright colored collars and toys
layer4-142
human annotations
- animals and coiled objects
- shaggy dogs
- a rounded edge
layer3-87
human annotations
- colored bowls
- the sides of bowl like objects
- rounded edges in pictures
layer4-993
human annotations
- people, paper, and white backgrounds
- the edges of items
- rounded edges in pictures
layer4-1193
human annotations
- birds on therans, wild life, small white buildings by the beach, a baby's right arm, a person holding a water bottle, a person writing
- animals, bottles and curved objects
- rounded edges in pictures
layer4-1714
human annotations
- dogs, appliances and circular objects
- curves
- rounded edges in pictures
layer2-10
human annotations
- they have a line through them
- lines and edges
- objects with metal
layer3-449
human annotations
- dials of a clock, womans face, motorcycles whee, wheel
- wheels and clocks with spokes
- the spokes of wheels, and the hands of a clock
layer4-333
human annotations
- bottles and water
- cylinders
- bottles
layer4-1052
human annotations
- paint of a limo, bike, bird on theree, tire, canoe on the water
- animals and circles
- birds and wheels
layer4-1624
human annotations
- right and left side of a bird, building, sock
- corners, floors and grass
- angles
layer3-175
human annotations
- a dining table in the distance
- many types of tables
- tabletops or water
layer2-436
human annotations
- spaces on the support beams of crane, a person walking on theback holding something, two guys on a cover of album, text on the side of a blimp
- areas between letters and metal poles
- brown dogs
layer3-561
human annotations
- orange and yellow areas
- food
- food, animal, drink
layer3-648
human annotations
- animals and other shiny objects
- bugs
- spider, animal, food, jet, clock
layer4-1495
human annotations
- glasses, stone building, fence
- stones, arches and produce
- multiple items that are similar
layer4-1015
human annotations
- animals, cookware and buildings
- animals and objects that resemble animals
- land animals
layer3-315
human annotations
- faces of people
- faces
- faces
layer3-353
human annotations
- the bottom
- colored dots
- edges of the object
layer3-808
human annotations
- arched areas of animals
- areas around beaks, horns and wings
- beaks of birds
layer3-935
human annotations
- fence and pole shapes
- pale areas between dark lines
- fire truck, pig, grated looking objects
layer4-1593
human annotations
- a car going down the track, a pathway ,sky, a hay bail, window
- grass, roads and clouds
- grassy areas
layer4-1570
human annotations
- animals and rulers
- rulers
- rule, snake, animal, boat
layer1-17
human annotations
- turtle's shell
- space above black lines
- the outline of two of rounded things
conv1-1
human annotations
- comic book text and drawings, flower pedals
- yellow flowers and signage
- yellow in the colours
layer4-154
human annotations
- curved objects and animals
- skinny poles and arms
- brown and white colored objects
layer3-459
human annotations
- bird heads and nails and similar shaped objects
- heads of birds
- things that are long
layer4-541
human annotations
- animals
- brown dogs
- a furry texture
layer4-1343
human annotations
- cabinet, ball a kid is holding, a cloud in the sky
- furniture, clouds, and ball
- wooden drawers
layer1-226
human annotations
- a guitar pick in strings
- white outlines of objects
- flowers and skinny bars
layer3-328
human annotations
- snake going across a branch
- bodies of different types of bugs
- insects
layer4-118
human annotations
- animals, produce and axes
- people and animals
- long, thin items
layer4-280
human annotations
- animals and planes
- black and brown creatures
- pointy sections, such as claws or horns, of several animals
layer4-1599
human annotations
- chains, people, snakes and railings
- brown animals
- the regions have one item on another item
layer4-1317
human annotations
- poles, vehicles and animals
- these objects have spoke like this sticking out
- lawn mower, person, animal, chair
layer2-45
human annotations
- the color blue
- space around animals, or a animals' toy, mosaic glass, table, dogs posing for photo
- blue areas in pictures
layer2-30
human annotations
- striped objects
- checkered pattern on objects
- striped or checkered patterns are found in multiple places from screens to clothing to designs
layer4-262
human annotations
- water
- sources of water
- person, nature., food, water
layer4-669
human annotations
- animals, flower buds and plungers
- rounded objects
- orange bugs and animals
layer4-1093
human annotations
- birds and vertical poles and columns
- rectangular objects
- stone towers
conv1-30
human annotations
- lit up areas around the edge of text and objects
- black lettering
- the edges of letters and objects
layer4-367
human annotations
- repeating lines and fences
- dogs, furniture and vehicles
- shaped like a fan
layer4-2032
human annotations
- a bridge on the water, a guitar, a bridge
- people, bridges and instruments
- items with string-like connections
layer3-393
human annotations
- a crockpot, a serving cup, a cup of cofee, pastry on a rack
- coffee mugs
- cups
layer2-203
human annotations
- snakes and monkeys
- background behind and over an animal
- brighter areas in objects
layer4-266
human annotations
- animals and boxes
- wooden structures and animals
- boxes
layer4-327
human annotations
- animals and buildings
- brown dogs
- animal heads or round at the bottom and skinny at the top
layer4-1968
human annotations
- windows in a building, pole a women is holding, keyboard a kid is playing on
- human hands
- people, nature
layer4-1836
human annotations
- areas with letters, numbers, or patterns that resemble letters or numbers
- butterfly, hamster, volleyball, measuring cup, headstone at a cemetary
- rounded items
conv1-33
human annotations
- a laptop with text on it, a picture with text
- black lettering
- letters and numbers
layer2-266
human annotations
- dots around legs, letters and metal poles
- red shirts
- a line separating color
layer3-141
human annotations
- purple objects
- pink
- purple areas
layer4-1246
human annotations
- people and animals
- faces and objects that look like them
- dogs
layer4-1170
human annotations
- animals and tools
- birds and dogs
- person, desk, grass, nature
layer4-1671
human annotations
- a rocket lifting off, a volcano erupting, a musician on stage, a dog's ear
- colored lights
- bright colors
layer3-310
human annotations
- noses and rounded objects
- birds and dog noses
- rounded areas
layer3-319
human annotations
- a dog walking through the snow
- dog heads and the tops of perfumes
- the face
layer4-215
human annotations
- animals and things with posts
- tan jackets
- people doing things
layer4-225
human annotations
- curved objects and animals
- curvatures and corners
- hooks and hook shaped items made out of different materials
layer4-882
human annotations
- animals, handles and pencils
- household objects
- items used as extensions
layer4-1274
human annotations
- makeup in a dish, fruit on a table
- food and dirt
- person, food, vehicle, nature
layer3-990
human annotations
- snakes and curvy lines
- tails of dogs
- things that can bend
layer3-492
human annotations
- graduation caps and legs
- multiple star or "cap" shapes
- the photographs represent angles / points within an object
layer4-490
human annotations
- guitar picks, bowls cooking, a place to sit, a satellite dish
- circular and metal objects
- rounded edges in pictures
layer4-501
human annotations
- animals, boxes and clothes
- fabric and textured surfaces
- rounded edges in pictures
layer4-1459
human annotations
- animals, chains, and food
- produce
- food products
layer4-1342
human annotations
- floor tiles
- kitchen tile
- person, ball, radio, nature
layer4-1096
human annotations
- bowtie, graphics on money, dog
- the color brown
- centers
layer1-69
human annotations
- lines and dots outlining the background
- a color gradient
- yellow tiger
layer3-343
human annotations
- back of a person's shirt as they play volleyball
- shirts being worn by people
- similar patterns
layer4-162
human annotations
- people and holes
- neck braces
- person
layer3-919
human annotations
- drawings and circular objects
- text and patterns
- orange and red objects
layer1-169
human annotations
- a tiger in the distance
- spots that are on different animals
- very small dots
layer3-247
human annotations
- few insects
- sticks and other strong lined objects
- food, person, plane
layer4-160
human annotations
- boat someone is on, a star fish, a insect
- animals and pottery
- small sea creatures
layer4-125
human annotations
- animal faces and objects that resemble them
- dogs
- head and neck area of animals
layer4-1353
human annotations
- ox, pole, light fixture, cemetary stone, speaker
- animals, poles and electronics
- brown animals
layer4-1313
human annotations
- birds, water, pills and handles
- white bottle caps
- multiple items that are similar
layer2-160
human annotations
- pale color region next to dark color region
- airplanes
- shark, car, boat, camera
layer4-403
human annotations
- edges and corners of furniture
- fingers and the outline of walls and animals
- black furry animals
layer4-397
human annotations
- rectangular objects and vehicles
- a brightly colored object in them
- fork lift, barn, shed, animal, buss, person, chain saw
layer4-1356
human annotations
- handles, electronics and balls
- long rectangular objects
- sharp knives
layer4-1595
human annotations
- limbs of animals and walls and floors
- a bird's wing, a water in the city, a bridge
- items with straight features
layer3-332
human annotations
- no noticeable pattern
- fruit and vegetables
- tan colored areas
layer4-16
human annotations
- animals, handles, and bridges
- musical instruments
- vertical patterns
layer3-678
human annotations
- sticks, whales and the backgrounds
- brown animals
- animal, sky, jeans, snow, vegetable
layer4-1231
human annotations
- animals and circular objects
- animals, handles, and wheels
- objects with yellow and brown hues
layer4-911
human annotations
- animals
- bugs and dogs
- living things in them
layer4-1775
human annotations
- a shopping cart, a boy eating pizza, cheetah
- animals and buildings
- items with straight features
layer2-340
human annotations
- words and number pieces
- colour of the pictures
- circular objects
layer3-1016
human annotations
- bugs
- screw, tractor, bracelet, spider, spoon
- metal in the picture
layer2-255
human annotations
- lines and corners
- edges of pieces of text
- lighter areas
layer3-761
human annotations
- the outlines of square objects
- edges of squares and sharp objects
- edges of items
layer4-991
human annotations
- animals, boxy objects, and vehicles
- objects with text or lines
- brown animals and objects with circles
layer4-1829
human annotations
- emblem of a car, insects, dog pack, paper tools, building
- various animals
- multiple items that are similar
layer4-1870
human annotations
- animals and containers
- curved items
- things outside
layer2-445
human annotations
- aquatic life, a diver with a shark, toys, dump truck, a computer, a gas mask, a women on a motorcycle
- fluorescent blue objects mostly of water
- colorful decorations
layer3-993
human annotations
- bends in lines
- limbs of insects
- legs of creatures
layer3-644
human annotations
- tripods, flowers and animals
- spiders and flowers and bananas
- long, thin appendages in them
layer3-743
human annotations
- dots and corners
- orange objects
- contains curved areas of objects
layer4-1270
human annotations
- animals and white household objects
- white objects
- bathrooms and white objects
layer4-1798
human annotations
- bear, a dog laying on a sofa, kids eating ice cream, a fox, a cat, a kid walking in the grass
- animals and people
- living things
layer1-146
human annotations
- the letters of a speedometer, tech devices, a dog sits in a sweater, dogs and cats pose for a photo, the side of a statue
- pale areas next to dark colored areas
- the sides of a printed graphic
layer1-92
human annotations
- bright spots against a dark background
- flowers and butterflies
- flowers
layer3-622
human annotations
- beaks of birds
- line like items
- long, thin regions
layer4-179
human annotations
- birds, butterflies and vegetables
- animals and textured objects
- birds
layer4-834
human annotations
- objects that have words in them
- words
- written text
layer4-1028
human annotations
- objects in the sky and appliances
- household appliances, surfaces outside. a
- appliances, grass and furniture
conv1-20
human annotations
- bottle of a drink, pumping carving, letters of a clock
- colour of the products
- red in the colours
layer3-20
human annotations
- photo watermarks
- bras
- the transparent watermark covers part of the photo
layer3-1003
human annotations
- repeating gaps and holes
- plastic and metal objects
- pianos
layer3-899
human annotations
- faces of animals and areas surrounding insects
- animals, and nature backgrounds
- eyes of different animals and humans
layer4-510
human annotations
- vehicles, cups, animals and clouds
- colorful vehicles
- rounded edges in pictures
layer4-1499
human annotations
- windows and glasses
- a color blue green
- people
layer4-1700
human annotations
- hats, hammers, bats, sky, and flags
- black protruding objects
- items with angles
layer2-351
human annotations
- a spider going down a window
- person, bottle
- colorful pieces
layer3-403
human annotations
- the space under living creatures
- these where are the places underneath curves
- spaces around mammals
layer3-1021
human annotations
- eyes of brown animals
- fruit, dog, person, plant
- spotted areas in pictures
layer4-283
human annotations
- animals, guitars, windows and vehicles
- objects with yellow and brown hues
- mouths of animals and humans
layer4-581
human annotations
- birds, vehicles and trees
- dogs and birds
- things outside
layer4-1141
human annotations
- warehouse, monkey iin the trees, dog's ears
- animals, bridges and rails
- items with angles
layer4-1899
human annotations
- a computer text screen, a ver, a satellite, a barn, a chicken
- where two items meet
- cubed objects
layer1-2
human annotations
- penn, person standing on a whale
- bits of the edges of color changes
- nature, people, structure
layer1-166
human annotations
- shaded characters
- a man holding a lighter with text on it
- balls and black lettering
layer4-59
human annotations
- instruments, bottles and animals
- heads of different dogs
- mouths interacting with objects
layer3-556
human annotations
- poles and sticks
- metal screws
- long, thin items
layer4-615
human annotations
- animals and produce
- two areas that are connected by a central object
- rounded edges in pictures
layer4-1285
human annotations
- objects that are long
- animals and cords
- yellow areas in pictures
conv1-58
human annotations
- game controller, pair of shoes
- the background behind all items is plain
- devices
layer2-483
human annotations
- legs of a bird, boarder of a text, birds sitting on a stick
- diagonal red, blue and orange objects
- red stripes and birds
layer4-13
human annotations
- animal heads
- ears of brown dogs
- animal ears
layer3-845
human annotations
- the right side of a object
- edges of red and orange objects
- side of object
layer4-842
human annotations
- dog posing for a photo, people posing for a photo, a ship washed ashore, lizard in therans. ship out at sea, a pull up drive in
- animals, vehicles and lights
- shaggy dark dogs
layer4-1456
human annotations
- condiments and brown animals
- items with circular features
- rounded edges in pictures
layer4-1892
human annotations
- bird
- animals and people
- appendages
layer2-450
human annotations
- animals in a photo, a few fish
- spots on objects
- lighter areas
layer3-65
human annotations
- dog eyes
- face of animal
- canine eyes
layer3-642
human annotations
- animals and rockets
- grey hued areas
- red objects
layer4-1154
human annotations
- animals, boxes, boats and pots
- boats, animals, and furniture
- things that can go outside
layer4-1365
human annotations
- objects with multiple gaps and lines
- grates, fences and mics
- grids and lines
layer4-1622
human annotations
- fruit in a basket, fish
- puzzles, food and balls
- items with straight lines
layer2-301
human annotations
- space on a crossword
- dog looking in the human
- keyboard use a music
layer3-1013
human annotations
- ears of animals and squares
- dog ears
- boat's sails or mast
layer3-1004
human annotations
- eyes and doorknobs
- eyes and noses of animals and humans
- red areas in picture
layer3-767
human annotations
- circular objects
- food
- distinct rounded area
layer4-513
human annotations
- animals and things shaped like shells
- white areas
- a white object against a dark background
layer4-1911
human annotations
- dishes, kid, theback
- curved features
- rounded edges in pictures
layer4-1826
human annotations
- a man wearing a skirt, a dog walking along the grass, a scorpion
- animals
- items with straight features
layer3-275
human annotations
- a piece of jewelry, a sock hanging up on a wall, chair, instrument, boat in the distance
- splotches on the main body of a object
- gold looking objects in them
layer3-397
human annotations
- space on theother side of an object, speedometer
- jewlery and round meters
- lines in pictures
layer4-165
human annotations
- walls and backgrounds
- background of an image with light colors or animals
- the sides of objects
layer4-309
human annotations
- grass
- dirt and grass
- similar color patterns
layer4-898
human annotations
- foxes looking through a fence, a piece of food, a movie theater poster, top right of food, dogs playing in yard
- animals, windows, food ad bottles
- food
layer4-1567
human annotations
- a snail on a law, a tennis ball, a person with a tennis racquet
- curved area or round object
- rounded items
layer2-82
human annotations
- the color blue
- areas where brown spot is next to blue spot
- the tips of items or have a mix of colors in them like stripes
layer3-202
human annotations
- curved areas of animals
- ears of animals
- necks of objects
layer4-363
human annotations
- tan areas
- blunt end of object
- fruit, logo, food
layer2-265
human annotations
- dots outlining a object
- red objects and pans
- items that are colored red or chrome
layer4-708
human annotations
- green objects and vegetables
- items that are curved
- green areas in picture
layer4-698
human annotations
- food and eyes
- fruit
- rounded edges in pictures
layer1-175
human annotations
- a shark going through the waters. a whale in the ocean
- outlines of animals and letters
- animal, plant, person
layer2-151
human annotations
- dogs, a hockey player in a rink, a bird near it's mess, shoes
- dog ears
- lighter areas
layer3-610
human annotations
- animals in the water
- water with ripples
- brown ducks on the water
layer4-400
human annotations
- animals, bowls and water towers
- water towers
- a ridge like pattern
layer4-950
human annotations
- text on a tombstone, aquatic life in the water, back of a school bus, a student hiding, white line or a road
- mirrors, buses, animals and circular objects
- surfaces containing grey
layer4-1464
human annotations
- thimble, wallet, gator, graphic on a crockpot, strings on a harp
- areas with mesh or lined texture
- curved items
layer1-41
human annotations
- a mouse trap
- small dots
- pan, animal
layer2-431
human annotations
- repeating black and white patterns
- a women holding a pair of crutches
- red stitching and keys
layer3-538
human annotations
- grey areas
- metal bars
- thin metal pipe
layer3-835
human annotations
- bottom right corner
- corners of objects
- tiny patterns in them like writing
layer4-914
human annotations
- animals and circular objects
- object with pointed thin objects
- clocks
layer4-1295
human annotations
- objects that have silver in them
- circular objects, animals and clothing
- metal objects
layer1-114
human annotations
- a cup of juice, a tree bearing fruit, a soccer ball
- dogs and black lettering
- edges of objects
layer2-149
human annotations
- windows of buildings
- specific patterns
- areas of intersecting lines
layer4-355
human annotations
- skin toned items
- tan objects
- items that contain straight lines
layer3-732
human annotations
- masks, collars and tops of bottles
- necks
- armor, dress, baby lotion, person
layer4-733
human annotations
- a dog on the ground, kids at a table, a cat in a washing machine, a man holding a watch
- rounded objects
- hands, water, paws, and turquoise objects
layer4-1581
human annotations
- a bird on the beach, a hog in the grass, a dog, a kangaroo
- animals
- living things
layer2-336
human annotations
- a birds beak, a dogs ear
- beaks and ears
- the tips of pointy objects
layer2-326
human annotations
- a pirate ships flag
- colored lettering
- the top edges of some items
layer3-102
human annotations
- these spots are in the corner
- car, sky
- around objects
layer4-543
human annotations
- duck on the water, a dog on the grass, ant moving around, a bird on a rock, right side of a women
- animals and rocks
- mammals, birds, and insects
layer4-650
human annotations
- animals and square objects
- textured objects
- food and stones
layer4-1860
human annotations
- animals, pills, baskets and furniture
- insects, faces of does and various food products
- things that are coming together
layer3-259
human annotations
- faces of people and socks. also bottles
- blue and red stripes
- faces of different things
layer2-78
human annotations
- pale spots where light hits an object
- green trees
- similar patterns
layer4-185
human annotations
- toys, and other circular objects
- plastic, tapered objects
- skinny rods
layer4-750
human annotations
- dog, flute someone has, bird, bow and arrows, flute
- people and trees
- hands doing things
layer4-1723
human annotations
- stones and boulders
- rocks
- rocks
layer3-284
human annotations
- faces of animals and food items
- space above a dogs head
- the outlines are a object mostly animals or food
layer2-188
human annotations
- edges of animals and background
- sharks
- specific patterns
layer4-103
human annotations
- animal chests
- animals
- white shirts and white birds
layer3-932
human annotations
- yellow objects
- yellow areas
- yellow objects
layer4-907
human annotations
- objects and lines in the sky
- birds in the sky, a did player, stream from exhaust from airplane, a truck going down the highway
- cassette, smoke, animal
layer4-1127
human annotations
- cow in water, person at a swimming pool, horse
- animals
- brown dogs
layer1-70
human annotations
- aquatic life, a person playing an instrument
- small white sticks
- duck, plant
layer2-285
human annotations
- a parrot
- small holes that are black
- flowers in the places
layer3-768
human annotations
- noses and shiny metal objects
- black bugs
- a wheel spoke design
layer2-193
human annotations
- look like hair
- corrugated metal that is on different objects
- similar patterns
layer4-905
human annotations
- people
- people and animals
- human faces
layer4-1582
human annotations
- drain on the ground, bed, bird on the ground, pet
- animals, grates and fabric
- white dogs
layer1-174
human annotations
- outside borders
- a shark in the waters
- muted animals
layer2-153
human annotations
- the sky above animals
- monkeys and dogs
- above animals
layer4-825
human annotations
- animals and things with handles
- items that are connected to other items
- things outside
layer3-945
human annotations
- these things with dots
- objects with patterns
- similar color patterns
layer4-1532
human annotations
- fruit and vegetables in a basket, a kid eating fruit
- circular objects
- have food
layer4-1405
human annotations
- toilet paper, semi, pole two girls are dancing on
- column or rectangle shapes
- two items that are separated
layer2-454
human annotations
- dogs in the grass, a person wearing a shower cap, the neckless or strap of an object, space of a license plate of a car, a dogs toy
- areas that contain the colors yellow or blue
- yellow areas and blue areas
layer2-155
human annotations
- black lines that form edges
- corners of curvatures
- patterns
layer4-143
human annotations
- animals and metal objects
- brown animals
- animal, vase, bell
layer4-276
human annotations
- animals and circular objects
- black birds
- areas with blocked patterns
layer4-859
human annotations
- animals, domes and jewelry
- spirals and chains
- similar color patterns
layer4-1777
human annotations
- a to up on a stand, a cup for a candle, a fire place guard, monument
- rectangles and column shapes
- items with straight features
layer1-26
human annotations
- an accordion
- hooks and black lettering
- the color white
layer3-389
human annotations
- a pair of binoculars, a armadillo, a coffee cup, a person taking a selfie
- birds
- front of objects
layer4-38
human annotations
- circles
- eyes and objects that resemble them
- images with circular features
layer3-671
human annotations
- red object
- red accented clothing
- the color red
layer4-1296
human annotations
- pointed objects and white items
- areas with lines and text
- guitar picks
layer4-1755
human annotations
- dog on snow, light pole, fence, chain link fence with logs
- poles and fences
- nature
layer1-72
human annotations
- a violin on a sofa
- white lines outlining a object
- mask, person, ipod
layer3-390
human annotations
- beverages and cylindrical domes
- tops of angled/curved shaped triangles on objects
- tips of things
layer3-550
human annotations
- pale spots on or around an object
- ferrets
- are blue or tan areas
layer4-275
human annotations
- food in a pan, flowers in a pot, frog, dog
- animals and circular objects
- fluffy dogs and pots
layer4-1364
human annotations
- the sky or a reflective surfaces
- objects with red and yellow hues
- blue skies
layer4-1604
human annotations
- a bird someone is holding, a dog, a person on the beach
- collared dogs
- animals, people, nature
layer2-102
human annotations
- yellow backgrounds on industrial objects
- school buss, bedding, animal, person, sand, puzzle
- orange areas in picture
layer2-61
human annotations
- patches of red and yellow
- the color orange
- red and yellow objects
layer3-674
human annotations
- gold and silver ornate items
- golden items
- hooks of objects
layer4-1004
human annotations
- animals and points
- object over pale background
- pointed outer edge
layer4-1458
human annotations
- man's shirt, tennis racket, hippo in the water
- people, animals and circular objects
- body parts of humans and animals are being used for rest or for completing tasks
layer2-461
human annotations
- a space shuttle, a group of dishes in a rack, a dog driving a car, a car herring off track, a
- black stripes
- specific patterns
layer2-231
human annotations
- edges of curved lines and white spots
- a line through them
- edges of objects
layer3-653
human annotations
- {these are poles, walls and leafs
- tile in bathrooms
- tiles and plants
layer4-470
human annotations
- animals and pens
- black bugs
- spiders and snakes and bugs
layer4-860
human annotations
- snow and water
- animals in the snow
- white areas in pictures
layer4-1941
human annotations
- snakes, chains, ties, and circular objects
- items that are rounded
- similar color patterns
layer2-501
human annotations
- spots of the color white
- this has gradients of white and gray
- brighter areas within objects
layer3-971
human annotations
- red and orange corners
- space in between objects
- spaces in between things
layer3-942
human annotations
- clothes
- logos and patterns on clothing
- basketball clothing
layer4-613
human annotations
- mice, striped shirts and poles
- corners
- rounded edges in pictures
layer4-1602
human annotations
- food, dog, hyena, wolf
- brown dogs
- dogs and food
layer4-1771
human annotations
- magnifying glass, tennis racket
- area where object tapers significantly
- extensions
layer2-27
human annotations
- dots on animals, backgrounds and vehicles
- brown dogs and beavers
- light areas of pictures
layer1-229
human annotations
- a group of dogs in the background, a speedometer, people pose for a photo with or without animals, animals in the wild
- white outlines of objects
- brighter areas in objects
layer4-234
human annotations
- people
- faces of people
- areas with rounded tops in them
layer4-213
human annotations
- poles and cakes
- animal cages
- part of the sides of things
layer4-1634
human annotations
- building, boat on the water, dog, bench
- water and furniture
- angles
layer4-1370
human annotations
- ice cream cone, a boy holding a piece of bread, four corners of a pillow, the left and right top space of a bunk bed
- objects with brown hues
- the sides of objects
layer2-422
human annotations
- the color orange and red
- a dog walking through a field of flowers
- animal
layer1-152
human annotations
- pale areas next to dark objects
- small white color dots
- space on borders of polygons
layer4-145
human annotations
- electronics
- grey objects
- black and silver objects
layer4-69
human annotations
- fabric and greens
- faces and dogs
- wrinkled fabrics
layer4-706
human annotations
- insects and objects with gaps
- things with black dots
- panda bears
layer4-807
human annotations
- people and dogs
- brown dogs
- pictures of animal
layer1-76
human annotations
- a trash basket, a dog infront of a fire truck
- mesh texture
- red patterned dots
layer2-180
human annotations
- spots of single color
- spots of grey and blue
- specific patterns
layer3-848
human annotations
- snakes, grills, and electronics
- snakes
- snakes
layer4-805
human annotations
- fences and pool dividers
- a pattern made from multiples of the same object
- water and fencing
layer4-1336
human annotations
- animals with fur
- animals, plaques and the sky
- brown dogs
layer4-1661
human annotations
- textured surface or object
- birds and dogs
- living things
layer4-21
human annotations
- tires and circular objects
- wheels and other curved objects
- round objects
layer2-123
human annotations
- dogs posing for a photo, space above a gym bag, birds pose on a branch
- pale areas
- sharks in the ocean
layer4-956
human annotations
- carts, animals and electronics
- cats and dogs
- areas with straight lines
layer3-686
human annotations
- bows, animals and dots
- red objects
- plates, food, person, bowtie, animal
layer4-1509
human annotations
- liquor bottles and beer
- man holding a beer, beer in a crate, a beer bottle next to a clock
- containers
layer4-1396
human annotations
- a crossword puzzle, pineapple, sailboat, quarter, dog
- tables and paper
- items with straight surfaces
layer2-138
human annotations
- grass and the color blue
- outlines of animals and vehicles
- orange vehicles
layer3-55
human annotations
- white backgrounds on tools
- fluorescent white backgrounds
- around the object
layer4-379
human annotations
- limbs of people and wildlife
- mens' faces
- facial region of human
layer4-322
human annotations
- animals and grass
- red objects
- similar patterns
layer4-2043
human annotations
- blue objects
- a writing
- animal, nature
layer4-1513
human annotations
- the right side of a monkey, a dog sleeping in a cage, a person playing guitar
- windows and cages
- windows, animals
layer1-158
human annotations
- a sign wither there is space inbetween
- twigs and ocean life
- animal, text
layer2-470
human annotations
- words and numbers
- black numbers and lettering
- numbers and letters
layer4-191
human annotations
- animals and things with black dots
- thin at the top and rounded at the bottom like a bell
- tower, food, animal, ship
layer3-887
human annotations
- shelves and the background
- brown dogs
- some pieces of sky, some clothing, and the ear of a fox
layer4-654
human annotations
- green objects and parallel lines
- belts, straps, and handles
- shirts and other pieces of fabric
layer4-1049
human annotations
- hat, lock, food
- animals, locks, tools, and toys
- metal locks
layer2-416
human annotations
- a shelf of wine bottles
- dots outlining corners
- person, food, helmet
layer1-91
human annotations
- instruments
- a spotty texture
- similar patterns
layer3-635
human annotations
- animal heads and legs
- eyes of dogs
- brown
layer3-669
human annotations
- animals and handles
- fur of animals
- nature, person, dog, handle, clothing
layer4-839
human annotations
- poles, animals and wheels
- machinery
- edges of objects
layer4-891
human annotations
- means of transportation going down the road, a flag parachute
- vehicles, metal objects and flags
- trucks
layer3-84
human annotations
- ceiling above rooms
- ceilings
- ceilings
layer3-437
human annotations
- repeating lines and patterns
- various patterns
- specific patterns
layer3-966
human annotations
- circular objects
- bridges and railings
- spoke like pattern
layer3-946
human annotations
- animals, flowers, and baseballs
- pink areas and foreheads of animals
- lighter areas
layer4-1889
human annotations
- the background of an image
- clouds in the sky, mountain ranges
- curved items
layer4-1788
human annotations
- brushes and feathers
- the sky and the ground
- two items that are connected
layer1-100
human annotations
- a whale with lettering underneath
- outlines of spider webs, words and fences
- thin white colored lines along a darker colored surface
layer3-336
human annotations
- the top of an archway
- curved borders of things
- front of objects
layer3-624
human annotations
- the body of animals and vehicles
- brown dogs
- skin folds or things that look like it
layer4-681
human annotations
- animals in the wild and people climbing rocks
- animals, ground and things with handles
- dog legs
layer4-1092
human annotations
- food, a dog leaning over a ledge, a airplane taking off, a roof
- food, roofs, boards and planes
- sandwiches and dogs
layer4-1719
human annotations
- insects, a prize, a insect
- animals, frisbees, signs
- areas with straight features
layer3-450
human annotations
- light colored and have a shape in them
- flat areas on different objects
- rounded edges in pictures
layer2-277
human annotations
- objects with polka dots and checker patterns
- small polka dots
- spotted patterns
layer4-494
human annotations
- box shaped objects
- boxes, dogs and use
- baskets and furniture
layer4-879
human annotations
- poles, rims and snakes
- smooth cylinders and cube shapes
- person, nature
layer3-220
human annotations
- animals roaming outside
- faces of brown dogs
- animal
layer4-448
human annotations
- lines with jagged edges
- animals and sticks
- area where object tapers significantly
layer4-641
human annotations
- animals, cookware, candles, bats and poles
- area where action is taking place
- flames
layer4-1693
human annotations
- shoes, dog, pants, whale in the water, pants
- dogs and clothing
- animals, insect, nature
layer2-304
human annotations
- space on the upper part of a speedometer
- necks and round numbers
- needle, gauge, mask, person
layer2-218
human annotations
- bottle caps
- dual color areas within objects
- brighter areas in objects
layer2-224
human annotations
- no noticeable pattern
- striped objects
- the i-shaped areas in them
layer1-56
human annotations
- bird
- flowers and birds
- 90 degree angles black lines
layer3-969
human annotations
- center of clocks and circular objects
- clocks and buds
- front of objects
layer3-762
human annotations
- areas above a dark object
- fountain pens
- the sides of objects
layer3-936
human annotations
- outlines of animals and objects
- multicolored stripes
- edges of objects
layer4-1695
human annotations
- animals
- animals
- living things
layer4-1526
human annotations
- front side of a church, water tower, flowers
- a building containing windows in it
- two items that are connected
layer3-313
human annotations
- repeating parallel lines
- a camera lens projector
- grilles and stripes
layer2-199
human annotations
- spots of the color white and orange colors
- colorful objects and spirals
- lighter areas
layer3-681
human annotations
- people and towers
- waists of outfits
- hourglass shapes
layer3-729
human annotations
- animals and stripes
- birds
- lines and animal fur
layer4-933
human annotations
- a man wearing a green shirt, a dog on these of a box, a dog laying down, a cat in the wild
- animals
- people, nature
layer4-1135
human annotations
- dots and people
- curved items
- corn, water, person
layer2-307
human annotations
- the color white and circles
- a zebra stripes on head
- right sides
layer2-280
human annotations
- the middle of yellow and white objects
- corners and animal faces
- light colored patches on a wall
layer3-529
human annotations
- the heads of animals pointing upward
- heads of birds
- the necks of birds or bird looking items
layer3-59
human annotations
- dog collars
- god collars
- necks of mammals
layer4-678
human annotations
- birds in flight, a fish, clothing, backside of a cheetah
- patterned fabric, animals and mics
- patterned knits
layer4-499
human annotations
- animals, bottle tops and trash
- white bottle caps
- person, food, vehicle, nature
layer4-1534
human annotations
- animals, water tower, water
- animals and towers
- two items connected
layer4-1805
human annotations
- a mouse trap, a book with magnifying glass,
- animals, poles, and sticks
- long and slender items
layer2-410
human annotations
- edges of curved objects
- cars going down a road, plane's turbo engines
- wheels of vehicles
layer3-115
human annotations
- beaks of birds
- feet, peaks and petals
- beaks of birds
layer4-464
human annotations
- fur of animals and objects in the sky
- animals, bridges and bottles
- glass bottles
layer4-777
human annotations
- electronics, bottles, buses and a snake
- text and textured areas
- digital numbers
layer4-1818
human annotations
- brown and beige items
- brass colored objects, foliage, animals and tube shaped objects
- areas on the side of items
layer1-183
human annotations
- white outlines
- lines and edges
- edges on objects
layer3-66
human annotations
- fur on different animals
- the top parts of items or hair
- above images
layer4-210
human annotations
- dresses, appliances and walls
- vertical, rectangular objects
- fridges and pink dresses
layer4-1701
human annotations
- areas where light colors meet dark colors
- curved items
- things outside
layer4-2010
human annotations
- a women holding a bottle of alcohol,a dog playing around, a snake,a insect, a rack full of weights in a gym
- brown animals
- animals, people
layer2-488
human annotations
- spots of colors and corners of objects
- stripes and texture
- edges of objects
layer2-167
human annotations
- spots of the color white and round objects
- orange circles
- jewelry, tripod, plane, wheel, car
layer3-647
human annotations
- corner of objects and animals
- red and pink objects
- corners and edges
layer4-408
human annotations
- dots, animals and food
- curved and textured objects
- tan food items
layer4-1451
human annotations
- school bus, truck, butterfly
- butterflies, vehicles and windows
- vehicles or birds
layer4-1673
human annotations
- a dog on a rug, a dog in a room, a phone on a wall, a bird on a rock, a cup
- handles, dogs, and vehicles
- show the sides of objects
conv1-48
human annotations
- ray traced sun spots
- strikes of a zebra
- black and white stripes
layer1-96
human annotations
- a computer screen
- green objects
- green and blue colored areas
layer3-122
human annotations
- the necks of birds
- rough textured patterns
- repeating lines in living things
layer3-874
human annotations
- necks and diagonal instruments
- long lines on objects
- woodwind instruments that people blow into
layer4-512
human annotations
- animals and grass
- green trees
- green areas in picture
layer4-1065
human annotations
- round objects and vehicles
- reddish objects
- orange materials
layer4-1704
human annotations
- tennis ball, shore, fish
- tan or yellow areas
- items with straight features
layer3-173
human annotations
- windpipe instruments
- contain stair/combined structures
- bulled in the gun
layer3-207
human annotations
- the edge of a sand, a chair
- elbows and corners
- sign, person, legs
layer2-253
human annotations
- dots outlining a object
- bottles and white skin
- parts of colored items
layer4-92
human annotations
- animals and wood
- textured objects
- men in red uniforms
layer4-791
human annotations
- child, a women's shirt
- people
- people
layer4-1280
human annotations
- animals with fur and feathers
- hair, dogs, water, smoke and legs
- eyes and hands
layer4-1703
human annotations
- drain, soccer ball
- animals and balls
- show two items connected
layer4-1912
human annotations
- a person cooking corn, a ruler, a syringe, a person playing music, text on a bottle
- object with line patterns or text
- items with straight features
layer2-98
human annotations
- white and black repeating patterns
- beds, stripes and checkered
- snakes and compasses
layer2-241
human annotations
- dogs
- very small dots and lines
- curves in them
layer4-219
human annotations
- tables and chairs
- seating arrangements
- this region shows items that are sets
layer4-484
human annotations
- monkey on a tree, hammer, design on a package, microphone
- animals and balls
- round objects
layer4-1131
human annotations
- a drums on the water, a large rock in a photo, a barrel of water, buildings on the right side of a road
- roads, grass and water
- rock looking items
layer3-348
human annotations
- computers and repeating lines
- the hinge of a keyboard, a camera tripod, a beatle, a watch hinge, a dog tail, case of a watch
- laptop hinges and compasses
layer4-239
human annotations
- green items
- green grass
- grass around dogs
layer3-930
human annotations
- furniture and carts
- wooden chairs and grocery carts
- various chairs
layer4-1480
human annotations
- a cat, a snake, an apple, a shovel, a whale
- animals, handles, stems and spoons
- cat, snake, people
layer4-1960
human annotations
- a bird on a hand, a dog in the grass
- animals and fruit
- small balls and dogs
layer3-335
human annotations
- the ear of an animal
- brown animals
- parts of animal body parts or other objects
layer3-172
human annotations
- a person golfing
- round object against a background
- the things that look like balls
layer4-240
human annotations
- animals and makeup
- lizards
- the backs of animals
layer3-112
human annotations
- the tops of peoples heads
- hats on heads of people
- shower caps
layer4-1009
human annotations
- paint brush, person laying on the bench, spider, hippo, a soccer ball
- pink objects
- purple accented items
layer4-840
human annotations
- animals and coils
- shaggy dogs
- items with straight lines
layer4-1869
human annotations
- space on the front of a women's shirt, a musical on stage, a ladder in front of a sign
- ladders, barrels, instruments and tailing
- items that are curved
conv1-7
human annotations
- spots of the color white around objects
- black lettering and other black objects
- the white areas
layer3-323
human annotations
- text on a truck or object, a back window of a car, a kid trying on googles, a trash truck
- lettering and stripes
- words or contain lines
layer3-877
human annotations
- spots of the color white
- the outline of animals and metal objects
- human hands and animal ears
layer4-278
human annotations
- circular objects and animals
- brown objects
- pictures of animal
layer4-1485
human annotations
- fruit, pizza
- the corners of objects
- food, pizza, nature
layer4-1314
human annotations
- chainlink fence, dog, a tire
- dogs, fences, pics, and circular objects
- items that are rounded
layer3-281
human annotations
- white spots on animal fur
- a dogs enjoying the outdoors!
- dogs
layer3-31
human annotations
- things with holes and eyes
- rounded objects with dots
- depict small circles inside an object
layer3-797
human annotations
- black, circular holes
- eyes and windows
- eyes of animals and black holes
layer3-927
human annotations
- checkered items
- dotted patterns on fabric
- a small checked pattern
layer4-1369
human annotations
- birds and animals
- animals and curved objects
- brown dogs
layer4-2030
human annotations
- chain on the ground, flute, people ina crowd, child and her computer mouse
- people, chains and instruments
- have a snake like pattern
layer2-362
human annotations
- a battle on a plate, a man holding a giant rabbit
- dots outlining a object
- stripes on objects
layer2-465
human annotations
- spaces between repeating lines
- brown dogs
- specific patterns
layer4-17
human annotations
- brown colored shelving
- ladders and bookshelves
- things with corners
layer4-198
human annotations
- mammals
- grassy areas and dogs
- the images show, animals, people
layer4-829
human annotations
- animals, brushes and trees
- legs
- rounded edges in pictures
layer4-935
human annotations
- food someone is eating preparing, animal
- animals, food and beakers
- the are a bunch of people eating and playing with pets
layer3-305
human annotations
- rows of objects
- rows of things especially rounded edges
- common patterns
layer2-243
human annotations
- dots and eyes
- black dots
- spotted areas in pictures
layer3-633
human annotations
- backgrounds and holes in fences
- small blue areas
- specific spots on animals and natural objects that are circular
layer4-480
human annotations
- people, animals and poles
- textured areas
- rounded edges in pictures
layer4-1034
human annotations
- hands of people and faces of babies
- animals, poles and shelves
- animal, nature
layer4-1739
human annotations
- a girl standing on the sand, a women walking down the pier, a women with her dog
- faces
- hair like things
layer3-187
human annotations
- blue and orange borders
- beads on a neckless, a dog playing with his toy
- colorful toys and vehicles
layer2-118
human annotations
- spots of the color white
- instrument, a bed, a piece of equipment
- white outlines of objects
layer3-504
human annotations
- green regions of images
- green objects
- green objects
layer4-359
human annotations
- dogs and vehicles
- vehicles
- vehicles or dogs
layer4-850
human annotations
- blue and green backgrounds
- blue ocean
- person, nature, food
layer4-1627
human annotations
- someone with a tennis race, a snake on the ground, a dog's tail
- animals and sticks
- two items connected
layer4-1913
human annotations
- animals
- animals
- living things
layer2-447
human annotations
- small metal lines
- the people and the animals are facing forward as if they are posing
- vertical objects
layer4-58
human annotations
- metal objects
- musical instruments
- metal or look like metal
layer4-195
human annotations
- shower caps
- dome shapes, the faces of humans, plastic bags, and a book's cover
- person, insect, plastic bag, satellite dish
layer4-992
human annotations
- animals that are brown
- animals and mounds
- brown animals
layer4-843
human annotations
- animals, plaques and water
- black dogs
- these features have two items connected with each other
layer4-1702
human annotations
- hamster in a package, text on a photo, boat in the water, dogs in the snow, birthday cake
- animals, water and white objects
- items that are connected
layer4-1190
human annotations
- animals
- people and animals
- pictures of animal
layer3-185
human annotations
- left ear of a tiger, fur of a dog, statue, people gather in a crowd
- areas that are tan
- animal
layer3-153
human annotations
- bodies of bugs and animals
- animals in there habitat
- reptile, bird, and arachnid features
layer2-373
human annotations
- uniform spaced ridges
- a ship masts
- helmet, fan, person, mouse trap
layer1-133
human annotations
- spots of the color white
- bright white areas
- lighter areas
layer2-261
human annotations
- dots on rounded objects
- vehicles and parts
- the edge of rounded things
layer4-274
human annotations
- animals and textured objects
- hands and arms of animals
- hands or claws or bugs
layer4-1242
human annotations
- a boy eating a piece of fruit a person playing an instrument, people cooking
- red objects and people
- objects close to the mouth
layer4-1552
human annotations
- dogs and white objects
- animals, appliances, furniture, and instruments
- white objects
layer1-215
human annotations
- spots of the color white
- nature
- random living and non living things
layer1-154
human annotations
- the space on the left of a bird
- dots on sticks
- unknown
layer4-174
human annotations
- animals
- animals and water
- pointy things in them
layer3-560
human annotations
- birds and things that look like wings
- bugs
- rounded area on an animal or object
layer4-1421
human annotations
- windows on a large building, a store window and door
- buildings, rides and alleys
- skinny poles
layer4-1269
human annotations
- circular objects and flamingos
- round objects
- human hands
layer2-195
human annotations
- the background walls and sky
- white skies
- areas directly above object
layer3-975
human annotations
- red hued spots
- random spots
- red areas in picture
layer4-430
human annotations
- chinese characters in background
- words, beads, and shoes
- text in them
layer4-1198
human annotations
- animals, bandaids and electronics
- fur texture
- bandages and ipods
layer4-1789
human annotations
- pet, women on grass, thimble
- animals and ceramics
- animals and textured surfaces
layer4-1785
human annotations
- faces of people, animals, front of buildings, front of bus
- wooden objects and vehicles
- areas with red or brown hues
layer3-215
human annotations
- a typewriter, a word search
- bottle caps
- round objects
layer1-112
human annotations
- edge of a beach before water
- outlines of blue objects
- dog accessories
layer3-512
human annotations
- noses of dogs
- dog noses
- dog noses
layer3-885
human annotations
- things shaped like cones
- tapered objects
- pots
layer4-968
human annotations
- people, animals and fences
- animals, cups, and things shaped like fence posts
- objects in places
layer4-1012
human annotations
- wooden objects with parallel and perpendicular lines
- cups, boxes, windows, and tables
- items with patterns
layer2-131
human annotations
- spots of the color white
- lines in them
- rounded edges in pictures
layer3-107
human annotations
- windows or window like things
- glass windows on bus type vehicles, with a swing set and house thrown in, for good measure
- yellow areas in pictures
layer4-561
human annotations
- metal bar
- animals and curved objects
- human hands
layer4-1208
human annotations
- balls, food, vehicles and shirts
- textured areas
- areas with straight lines
layer4-1441
human annotations
- faces of animals
- straw and dogs
- items with straight features
layer4-1654
human annotations
- peacock, boat, a women holding an umbrella, a gate to a house
- umbrellas or similar pattern
- straight lines
conv1-38
human annotations
- a zebra in a field
- birds
- animals in the places
layer4-63
human annotations
- texture on natural objects
- brushes
- a hair like texture or pattern
layer4-52
human annotations
- screens and windows
- illuminated areas
- an assortment of screens, a geode, and some painting
layer4-648
human annotations
- animals
- green grass and military jackets
- military and green jackets
layer4-596
human annotations
- animals, cars, and things with circles
- eye area of animals
- rounded objects
layer4-1943
human annotations
- text on a package, dress
- the tops and bottoms of objects
- vertical line patterns
layer4-1855
human annotations
- animals, trucks
- green objects
- green items
conv1-18
human annotations
- a bunny in a cup
- nothing
- nothing highlighted
layer3-523
human annotations
- area of photos above an animal
- the background and screens
- screens and dogs
layer3-424
human annotations
- curvy objects and single color backgrounds
- wooden instruments
- lighter areas
layer4-853
human annotations
- animals, blimps and papers
- fluffy dogs
- edges of objects
layer4-417
human annotations
- people, electronics and vehicles
- human mouths
- various consumer products
layer3-266
human annotations
- an animal's face
- dogs heads from the sides
- dog mouths
layer1-150
human annotations
- spots of the color white
- a group of people stand in a row where there is space above the sky
- white areas
layer4-90
human annotations
- national flags
- flag design or pattern
- triangular
layer3-585
human annotations
- wheels
- vans
- sides of objects
layer4-714
human annotations
- a bookshelf in a library, a train, a turkey in the wild, a skirt a man is wearing, left side of a sign, a dog
- animals, shelves and vehicles
- brown birds
layer4-1319
human annotations
- agglomeration of multiple colors
- food items on a shelf, food items, dress, right side of a kids clothing
- animals, food, and shelves
layer3-354
human annotations
- a women holding pups with have their faces, a to entertainment system with corners, kitchen appliances with it
- the sides of rectangular objects and dog heads
- lighter areas
layer1-122
human annotations
- blue and red borders
- a kids toy, a dogs ball, the strap to a gas make, text, graphics, table
- brighter areas in objects
layer3-894
human annotations
- checkered items
- checkered and lined designs
- object with patterns
layer4-138
human annotations
- poles, goggles, and dresses
- red and blue objects
- corners
layer4-924
human annotations
- animals, insects, metal and nylon
- animals and circular objects
- textured area
layer4-1358
human annotations
- elephant trunk, cabinet, camera
- animals, hooks, sky and water
- human hands
layer3-211
human annotations
- a dog on a sofa or chair
- dog ears
- ears on dogs
layer2-273
human annotations
- the border of two objects, materials, or colors
- dots on curved objects
- objects with red dots
layer4-1294
human annotations
- instruments, animals, cookware and grates
- object with lines
- objects with vertical lines
layer3-212
human annotations
- a pair of boots, a sweater
- green socks and mittens
- the edges of knit items or other objects
layer1-248
human annotations
- flock of birds in the sky, apples on a tree, a musician, speedometer
- flowers and branches
- lighter areas
layer4-41
human annotations
- animals and appliances
- black slugs
- curved area of animals
layer3-879
human annotations
- objects with different colors and patterns
- striped
- plant, curtain, animal, spiral designs
layer4-816
human annotations
- nets, grids, and sticks
- object with grids or lines
- netting
layer4-916
human annotations
- black and yellow wild life
- striped or checkered objects
- black objects with yellow and white
layer4-1866
human annotations
- text on a shirt, a insect, a flute someone is playing
- animals and corners
- items with angles
layer3-182
human annotations
- a drilling rig in the ocean, a train goes down the tracks
- light sources and plants
- plant, boat
layer3-857
human annotations
- these ae laptops and clothes
- area where object is indented
- bottom clothing
layer3-123
human annotations
- meters, wheels and white parts of nature
- pale areas around an object or text
- beaks of birds
layer4-693
human annotations
- a lizard, a crab. a dog walking along the beach
- animals, chains and blimps
- items with peaks
layer4-1283
human annotations
- animals, lines and barrels
- roads
- animals, nature, person
layer4-1882
human annotations
- a piece of fruit, a water tower, a toilet in the jungle, a soccer ball kids are playing with, dishes, a old man
- animals and curved objects
- items that are curved
layer1-13
human annotations
- spaces on the left side of an ipad
- sharks and blue skies
- person, water, text
layer3-271
human annotations
- under the eyes of furry animals
- eyes of animals
- eyes of animals and patterns
layer3-131
human annotations
- curved objects like mugs and stetsons
- hats
- hats
layer3-825
human annotations
- the rood of vehicles and birds
- tops of vehicles
- the tops of vehicles
layer4-675
human annotations
- roofs ships and windows
- lines on objects
- objects with many lines
layer4-887
human annotations
- book, eggs in a nest, a animal
- items that are rounded
- people, nature
layer4-1940
human annotations
- objects with curved surfaces
- bottles and jugs as well as a volleyball
- circular items
layer2-423
human annotations
- animals pose for photo, a cassette tape, a person performing, jewelry
- jewlery and guinea pigs
- round balls and eyes
layer3-486
human annotations
- tires and straight lines
- light blue
- things with extremities
layer3-578
human annotations
- vos and areas of white shirts
- jackets
- corners of tables
layer4-468
human annotations
- toilet paper, tracks on the sand, kid, spider
- animals, toilet paper and electronics
- babies
layer4-1546
human annotations
- horns of a gazelle, a building on a island
- buildings and things with bumps
- objects with ridges
layer4-1525
human annotations
- golf balls, faces of people
- bots and buttons
- multiple items that are similar
layer1-55
human annotations
- grass and foliage
- monies on some trees
- animals
layer2-220
human annotations
- colorful dots on objects
- several different colors of lights, mainly of the christmas variety
- brighter areas in objects
layer3-160
human annotations
- bottle and tower tops
- caps of bottles
- lid or rounded area
layer4-1256
human annotations
- people and animals
- hands being placed near the mouth
- heads and faces of people looking around
layer4-729
human annotations
- straw on the ground
- vegetation
- animals in straw
layer4-1687
human annotations
- two items connected
- animals, insect, nature
- similar color patterns
layer2-451
human annotations
- a type writer, a tail end of a airplane
- vehicles and shoes
- at least two colors in them that are contrasted
layer3-833
human annotations
- stripes
- skinny vertical lines
- striped objects
layer4-867
human annotations
- furniture, bowls, animals and fences
- surfaces with lines on them
- wooden objects
layer3-206
human annotations
- a dome building
- rounded buildings
- structure
layer1-79
human annotations
- butterflies and sharks
- animal, insect
- animal
layer3-770
human annotations
- cylindrical metal objects
- metal cylinder objects
- camera, stoplight, electronic, pen, hair dryer
layer3-773
human annotations
- windows, screens, shins and shoes
- teeth like lines in them
- the photographs represent angles within an object
layer4-951
human annotations
- people and flowers
- mouths of people
- pictures of mouths
layer4-1547
human annotations
- bus, punching bag
- cylindrical objects
- curved features
layer1-87
human annotations
- a bunny on a sofa
- nature, people, animal
- lighter regions
layer2-53
human annotations
- blue, green and red dots
- green and blue color spots
- knots of different rope
layer3-638
human annotations
- heads, necks and chests
- birds and dogs
- edges of objects
layer3-897
human annotations
- the right side
- fluffy animals
- edges of objects
layer4-671
human annotations
- animals and textured surfaces
- birds
- dark areas
layer4-1657
human annotations
- right side of a dog, a light switch, a toilet
- walls, floors and furniture
- items connected to other objects
layer1-12
human annotations
- two tiger's with spaces on their furs
- orange roofing
- ripples on the subject
layer2-394
human annotations
- classic cars, space atop a rocket, musicians on stage
- upper portion of circle and triangle shapes
- car
layer3-571
human annotations
- the bottom of electronics and fruits
- red colored objects
- fruit and vegetables and objects people use
layer3-545
human annotations
- the bottom right corner
- water and roads
- water, broom, nature
layer4-620
human annotations
- hands of people holding insects
- animals and fruit
- bugs
layer3-999
human annotations
- dog ears
- ears of animals
- ears and similar shapes
layer2-96
human annotations
- circles and eyes
- eyes and black dots
- they all contain living species
layer3-957
human annotations
- reflective metal objects
- shiny objects
- metal drums
layer4-358
human annotations
- red items
- red colored objects
- birds and red objects
layer4-1806
human annotations
- the edge of clothing and objects that has orange in it
- a ladybug, a women on a pier, theft and right side of a ship
- people and insects
layer4-1944
human annotations
- lettering on a wallet, a field, a giant snake, a meerkat, fish
- things that look like tails
- animal
layer3-171
human annotations
- bird chests
- person, animal
- brighter areas within objects
layer4-0
human annotations
- water and sky
- a divider between two shades of color
- blue areas in pictures
layer3-114
human annotations
- ships
- wooden masts that are on ships and ones that carry power lines as well
- vertical lines
layer4-758
human annotations
- animals and legs
- thigh and leg area of animals or humans
- legs of things
layer4-986
human annotations
- dog, alligator
- textured objects
- person, flower, vehicle, nature
layer4-1736
human annotations
- clothes and balls
- green or yellow hued areas
- areas with circular items
layer1-128
human annotations
- a person about to gong a bell, a player's legs as he hits a tennis ball
- legs of humans and animals
- sharp lines
layer2-248
human annotations
- airplanes
- spots of color
- spotted areas in pictures
layer4-387
human annotations
- animals
- black dogs
- a texture to them
layer4-579
human annotations
- animals, chains, handles and a recorder
- brown dogs and hands
- this region has objects with curves
layer4-1550
human annotations
- child's face, earth on the ground, shadow on the wall, right side of a horse, man laying on the ground, kids standing in a hall
- animals and the ground
- stone walls
layer4-1880
human annotations
- a beach, a castle, a walkway
- objects containing red or brown
- areas on the sides of items
layer3-186
human annotations
- wings of a hawk
- jagged edges
- wavy or alternating patterns in nature and various manmade subjects
layer3-367
human annotations
- poles, legs, and brushes
- bottom parts of clothing
- vertical patterns
layer4-33
human annotations
- poles and birds
- rounded objects with a point
- a cup shape
layer3-893
human annotations
- animal heads
- the eyes of animals
- animal faces
layer4-803
human annotations
- animals and musical instruments
- shaped like insects
- pictures of animal
layer4-1431
human annotations
- fences, animals and food
- large spiders
- things that are knotted together
layer4-1841
human annotations
- clothing, snake, beer
- people and clothes
- show centers
layer1-191
human annotations
- animals in the street
- sea creatures and white lettering
- plant, text
layer3-1011
human annotations
- facial features, the color yellow, and patches of skin
- human faces
- things related to people
layer3-828
human annotations
- eyes and flower buds
- eyes of dogs
- eyes
layer4-459
human annotations
- objects with cylinders or square protrusions on top
- faces of animals
- the heads of animals and the tops of bottles andlor items
layer4-981
human annotations
- objects and animals with curved lines
- snake like objects and nails
- snakes
layer4-1903
human annotations
- textured areas
- items with straight lines
- lighter areas in pictures
layer2-404
human annotations
- space above a mushroom growing
- a few foxes
- sky, nature
layer2-51
human annotations
- spots of the color white, text and yellow colors
- animals
- brighter areas
layer3-542
human annotations
- area of background above an animal
- monkeys
- parts of areas above things
layer4-771
human annotations
- brown color
- animals, plants and beaches
- textured objects
layer4-1037
human annotations
- makeup on a table, a a cat on a table, a monkey on a tree
- brown animals
- items with designs
layer4-1584
human annotations
- blinds, crane, an animal, boats
- poles, triangular shapes and punching bags
- suspended or floating objects
layer1-107
human annotations
- spots of the color blue and other borders of white
- red clothing and flowers
- similar patterns
layer3-499
human annotations
- eyes of animals
- red pandas and dogs
- eyes or fur of animals
layer3-881
human annotations
- curved lines and edges of objects
- balls, bowls, and other curved objects
- rounded orange objects
layer4-491
human annotations
- fur of animals
- animals and a plaque
- similar color patterns
layer4-1291
human annotations
- people, animals and relish objects
- red objects
- brown
layer4-1895
human annotations
- shopping carts and grates
- carts and remotes
- items with straight features
layer1-134
human annotations
- spots of white
- the sides of photo
- dogs
layer2-480
human annotations
- aquatic life, a monkey on a tree, birds in water, a person holding power tools, animals laying about, cars
- animals
- red areas in picture
layer4-126
human annotations
- animals, water and smoke
- animals and objects that may resemble animals
- lines of smoke
layer3-860
human annotations
- fabric and helmets
- red and white objects
- cloth or fabric
layer4-1994
human annotations
- this food, balls and balloons
- round objects
- orange balls
layer4-1857
human annotations
- areas with ridges
- animals and items with ridges and segments
- similar color patterns
layer1-209
human annotations
- repeating lines
- a dog in the grass
- legs and skinny lines
layer3-387
human annotations
- brown dog ears
- tan fur
- animals and over peoples head
layer3-630
human annotations
- fur of animals and red vehicles
- light reflections
- rounded edges in pictures
layer3-699
human annotations
- chests and similar shaped objects
- human chests
- women
layer4-1577
human annotations
- black critters
- items on other items
- band aid, snake, flower, bee
layer4-1113
human annotations
- rounded objects
- body parts of different animals
- two items connected
layer2-168
human annotations
- lines forming a grate on objects
- horizontal striped objects
- orange or have thin lines
layer3-80
human annotations
- word and the bottom of animals
- legs of animals
- feet area of animals
layer3-964
human annotations
- nails, pots and towers
- cylindrical objects
- object's bottle neck area
layer4-329
human annotations
- animals, smokes and vehicles
- birds
- animal, boat
layer4-1985
human annotations
- a trailer, a dog on the ground, a van with wheels
- birds
- items with triangular features
layer4-1744
human annotations
- animal or pet
- spiders, animals and tents
- animals, people, food, and floral or natural motifs
layer1-251
human annotations
- edges and boundaries of objects
- borders on white flowers
- the surface edges of these pieces are all very different materials
layer1-195
human annotations
- the upper outline of different parts
- black lettering and military equipment
- white lines
layer4-354
human annotations
- furniture and balls
- bedding
- bedding, sofa, person, ball
layer3-846
human annotations
- white appliances and animals
- coffee machines
- coffee makers
layer4-1403
human annotations
- people and water
- shorts and skirts
- people that are shirtless
layer4-1020
human annotations
- green objects and surfaces
- surfaces with green or yellow hues
- green objects
layer2-361
human annotations
- corners
- a printer machine
- corners of different objects
layer3-161
human annotations
- things shaped like shoulder seams
- concave features on objects
- curved beak-like area
layer4-347
human annotations
- cups, guitars, and carts
- brown dogs
- object between someones arms
layer4-1197
human annotations
- mouths, electronics and vehicles
- cars and electronic devices
- cubed things
layer3-287
human annotations
- cups and round objects
- salt shakers
- open containers
layer3-27
human annotations
- outlines of bowls
- box, animal, table, flower
- rounded edges in pictures
layer4-187
human annotations
- trees or wooden objects
- trees and birds
- birds and background images of shakes
layer4-598
human annotations
- human eyebrows
- these include the color yellow
- yellow areas in pictures
layer4-1043
human annotations
- fabric and clothing
- animals and dresses
- loose clothing
layer4-1462
human annotations
- a kid and his tennis ball, a fox and a package of toilet paper, a boat on the water, a taxi, a dog and a football
- soft and round objects
- two items that are connected
layer3-356
human annotations
- the color blue
- a horse galloping, a person holding a phone in their hands, the space below a human doing gymnastics, a person playing an instrument
- lighter areas
layer2-85
human annotations
- birds sitting on a branch, dogs paw, tech, wall decor
- shiny areas in the background
- parts of gradient color changes
layer4-385
human annotations
- animals
- animals and rounded objects
- pictures of animal
layer4-290
human annotations
- toasters and tools
- animals, appliances and things shaped like a tube
- kitchen objects
layer4-1327
human annotations
- animals and spiders
- animals
- spiders and dogs
layer4-1082
human annotations
- animals
- brown animals and grass
- foliage, feathers, fur, and wood
layer2-335
human annotations
- uniform color or shaded from blue to white
- canines posing for a photo, elk and cows in a pasture, a wild hog, fruit, mushrooms growing
- the farm animals are eating grass and seem to be enjoying the farm
layer3-331
human annotations
- yellow and tan backgrounds
- these include yellow parts
- brighter areas in objects
layer4-64
human annotations
- planes, animals, words and grates
- older writing and water
- things with a trail
layer3-850
human annotations
- dog ears
- the ears of dogs
- dogs with ears
layer4-1766
human annotations
- bird i the grass, a light switch, a vent, a tray, a dog
- boxes, switches and animals
- items with straight features
layer4-1952
human annotations
- ropes and chains holding an object
- stems, chains and ears
- hanging objects
layer3-363
human annotations
- a person rowing a boat, a dog poses for a photo, a zoomed in close up of a cheetah, a duck in the water, a bell from a tree, a snake, animals on a branch
- parts of outlines of things
- edges of objects
layer2-468
human annotations
- letters on a sign, space aroud a dog's tail, bunny on a machine, car's rims, leaves of a tree, dog's fur
- dots on curves
- dogs
layer3-704
human annotations
- bird beaks and similarly shaped items
- beaks of birds
- food, tie, microphone, apple, animals
layer4-383
human annotations
- a bookshelf in a library, a display case in a store, someone's shack, outside of a package, a fridge, left side of a picture of goats
- shelves, doors and door
- shoulders of people
layer4-737
human annotations
- people and electronics
- areas with red hues
- fingers and hands on people
layer4-1307
human annotations
- smoke and food
- smoke and things that resemble smoke
- steam and smoke
layer3-169
human annotations
- head of a dog, legs of a dog
- face of a dog with ears and nose
- animal parts and square objects
layer3-414
human annotations
- the top of dogs heads
- dog faces
- face of animal
layer4-11
human annotations
- aquatic animals
- a bubbling or explosive texture
- spotted areas in pictures
layer3-913
human annotations
- birds
- birds
- items with angles
layer4-861
human annotations
- animals, balls and artwork
- round colorful objects
- little things
layer4-1514
human annotations
- domes on top of buildings, a couple animals and one baby
- items that are curved
- things outside
layer4-1733
human annotations
- scales and fathers
- were textured
- similar color patterns
layer3-237
human annotations
- noses and areas around a object
- animal noses and sides
- fruit, animal
layer3-376
human annotations
- buttons and human tools
- small red dots
- faces on objects
layer3-530
human annotations
- shiny areas of animals and a mic head
- brown and red hued objects
- noses of animals and bugs
layer4-257
human annotations
- buses, buildings and bridges
- sides of objects
- school bus, building, shelf, car, house
layer4-633
human annotations
- animals and shiny objects
- metal
- items that have straight features
layer4-1086
human annotations
- black and white objects
- animals, food, balls and cups
- animals, vase, food
layer4-1915
human annotations
- benches and windows
- squared items
- vertical line patterns
conv1-50
human annotations
- zebra stripes
- dots outlining a object
- black and white stripes
layer2-95
human annotations
- dots on circles and stripes
- small black dots
- things on earth
layer3-580
human annotations
- eyes and blue objects
- eyes of black dogs
- assorted items and plants that are all blue
layer4-429
human annotations
- animals
- birds and dogs
- rounded edges in pictures
layer4-683
human annotations
- conical and tapered objects
- small metal objects
- tools, toys, and animals
layer4-1965
human annotations
- circular objects
- objects that contain red or yellow
- red objects
layer3-180
human annotations
- space below a boat
- water and fur
- water, animal
conv1-22
human annotations
- the front face of a soda machine. text on the front of a comic book
- red stickers and lettering
- bright red objects
layer3-579
human annotations
- wooden objects and peoples hands
- poles and people
- human hands and arms
layer3-142
human annotations
- edges of objects
- red and green objects
- rounded edges in pictures
layer4-518
human annotations
- animals
- brown dogs
- pictures of animal
layer4-801
human annotations
- dog's face, a guy in dyed hair smiling, a puppy
- animals and straw
- brown dogs
layer4-1902
human annotations
- animals ,food
- dogs and wooden things
- rounded edges in pictures
conv1-63
human annotations
- animals, signs
- text, logo, stripped animal
- the designer perfume and designer shoes go perfectly with the designer dog
layer3-329
human annotations
- space above the text on a bottle of lotion
- the edges of curved objects
- the edges of objects or areas
layer4-144
human annotations
- people and animals
- faces of people
- people, baby
layer4-399
human annotations
- vehicles, animals and circular objects
- vehicles and round objects
- tire, car, van, lock, animal, beach
layer4-686
human annotations
- hands and faces of people
- kid, a kid holding a remote, faces of people
- people holding things
layer4-728
human annotations
- a kid is holding a spider, a frog someone is holding, a elephant, stripes on pants, a bird ina a cage
- animals
- animals
layer2-120
human annotations
- grey or pale colored areas
- checkered printed objects
- spotted areas in pictures
layer3-692
human annotations
- red objects and bricks
- areas containing lines
- red objects
layer2-289
human annotations
- dogs in a fence
- lattice fencing
- dogs in the house
layer3-446
human annotations
- the corners of windows and pictures
- corners of paintings and windows
- brighter areas in objects
layer4-1419
human annotations
- tree, wicker broom
- pokey features
- animal, nature
layer1-139
human annotations
- letters on a sign
- white areas in between things
- nature, structure, text
layer2-133
human annotations
- spots of the color white
- the background of a animal
- areas with a slightly darker area of the main color in them
layer4-115
human annotations
- circular objects
- exotic animals
- animal, pills
layer3-754
human annotations
- red articles of clothing
- people and their skin and body parts
- red areas in picture
layer4-645
human annotations
- animals, cords and eggs
- brown objects
- brighter areas on objects
layer4-2017
human annotations
- birds, a spider a kid is holding, bread, a woman in a swiming pool
- animals
- living things or water
layer2-93
human annotations
- spots of the color white bordering text
- white dots on different objects
- brighter areas in objects
layer3-42
human annotations
- outward appendages such as feet or paws
- heads and appendages
- hands and feet of gators
layer4-250
human annotations
- the outline of a object
- brown dogs
- the edge of things that have an open like texture
layer4-420
human annotations
- legs of creatures and trucks
- animals, vehicles and roads
- green plants
layer4-1027
human annotations
- objects that are long
- instruments, firearms and dogs
- objects with line patterns or texture
layer4-2024
human annotations
- grass of a barn, corners of a fence, a panda, dogs on the grass
- animals, cases, grass, and tables
- angles
layer3-416
human annotations
- leaves and flowers
- green areas in picture
- green leaves
layer1-125
human annotations
- the color blue
- ipods
- the images are either black and white, or they are blue
layer4-1192
human annotations
- vehicles, tools, electronics, and balls
- vehicles
- things outside
layer4-232
human annotations
- objects with a wide tip
- nails, bugs and food
- metal objects and utensils
layer4-2005
human annotations
- makeup, drain pipe, white billiard ball, watch, whale
- poles, bugs and food
- birds
layer4-1018
human annotations
- sports balls
- balls, roofs, and webbing
- small balls
layer3-10
human annotations
- pale spots around darker objects
- the images include various colors and patterns
- specific patterns
layer3-457
human annotations
- lamps and dog ears
- lamp shades
- ears on people and animals
layer4-376
human annotations
- sticks, cords, and plants
- ropes and sticks
- vertical line patterns
layer4-334
human annotations
- animals
- brown dogs and birds
- multiple objects that are similar
layer4-1879
human annotations
- a tennis ball a pet is playing with, a tiger, a kid blowing bubbles
- yellow or green hued areas
- items that are rounded
layer2-497
human annotations
- the sky on top of images of animals
- dogs and monkeys
- light colored areas at the top
layer4-28
human annotations
- dome shaped objects
- objects with rounded bottoms
- bulbous or have a striated texture
layer3-891
human annotations
- ears of animals and coffee mug handles
- corners of animals and mugs
- ears of animals
layer4-597
human annotations
- animals and chains
- silver chains
- items that connect to each other
layer4-732
human annotations
- kids shoulder, books on a shelf, kid's hand, shopping cart
- animals, shelves, remotes and electronics
- people holding objects
layer3-184
human annotations
- handle's on a strap, a walkway to a castle, a dog's stuffed animal
- lines
- people, statue
layer3-204
human annotations
- a plane in the sky
- textured orange or peach colored
- red or flesh
layer3-498
human annotations
- repeating holes and grates
- dots and stripes
- a honeycomb design
layer4-29
human annotations
- peoples hands and pyramid shapes
- cup like objects
- rounded edges in pictures
layer4-660
human annotations
- legs, stripes, and scales
- line patterns on objects
- brown animals
layer4-699
human annotations
- animals, fences and poles
- necks and objects that resemble them
- human chins
layer4-1897
human annotations
- a foxes tail, a sign on a fence, a bird in a cage, a puppy on the other side of a fence
- cages
- areas with corners
layer2-212
human annotations
- lines in them
- small colorful dots
- person, flower, logo, sign, food, basket
layer3-756
human annotations
- furniture and vehicles
- areas around rectangles and lines
- wheel barrows
layer4-1884
human annotations
- space on the right side of brooms, dogs, a man wearing a skirt, a lizard
- white or grey areas
- items that are connected
conv1-23
human annotations
- a flea
- tiny spots of white areas
- animal, fan, helmet, logo
layer3-243
human annotations
- green plant life
- include green items
- small sections of textured green
layer3-64
human annotations
- black dots
- the colors black and white
- ball, person, clothing, mask
layer3-557
human annotations
- animal legs
- legs of different dogs
- the photographs represent legs of living things
layer4-1422
human annotations
- a dog in a bathtub, a dog in the floor, a inject a women wearing a dress, a
- dogs, clothes and trees
- items with straight features
layer4-810
human annotations
- objects made up of multiple lines
- animals and wheels
- rounded edges in pictures
conv1-39
human annotations
- flowers on a pedal, a tent
- pink flowers and hearts
- contain pink
layer3-849
human annotations
- tables and vehicles
- desk, table, sign, fire truck, person
- cubed objects
layer2-232
human annotations
- wings of birds and tall towers
- columns on older buildings
- vertical lines
layer4-884
human annotations
- human skin, females, dogs, and objects that are white
- bottles of random substances, a person sitting down, a dog's corner shot
- brown dogs
layer4-953
human annotations
- babies, cookware, electronics and bugs
- hands of people
- person, nature, fruit
layer2-116
human annotations
- repeating shapes and geometry
- small tan circles
- spotted areas in pictures
layer3-16
human annotations
- human hands
- small electronic devices
- hands in pictures
layer4-433
human annotations
- brown dog faces
- the region shows curved items
- pictures of animal
layer4-415
human annotations
- bowties
- bowties of different colors
- people, animals, food, and fruit
layer4-2001
human annotations
- a dog on the hand, a kid with a harmonica, a kid on the grass, a bird on the sand,
- animals kids and keyboards
- brown animals
layer4-1955
human annotations
- handles, fire hydrants and beads and accessories
- multiple items that are similar
- animal, collar, scale, fish, bucket
layer2-290
human annotations
- space above a dog, space above a polar bear
- the animals are in play
- dog looking in the human
layer3-373
human annotations
- lightly colored circles
- circular objects
- knobs
layer3-991
human annotations
- repeating black, white and brown colors
- whiskers and grid objects
- fur like patterns
layer4-849
human annotations
- animals and curves
- fur textured areas
- furry brown animals
layer4-1166
human annotations
- vehicles, animals, appliances and boxes
- rectangular objects
- animals and vehicles
conv1-16
human annotations
- underwater realize
- tables and shirts
- animals in the sea
layer3-239
human annotations
- borders of objects
- lipstick on a table, a dog staring at a computer screen
- area where light hits and object
layer2-237
human annotations
- the color red and yellow
- mushroom caps
- red areas in picture
layer4-45
human annotations
- animals, lamps, handles and parachutes
- the underside of things
- sky, bottle, lamp, balloon, sign
layer4-477
human annotations
- penny, and sticks
- objects with short, thin protrusions
- items that have straight lines
layer4-1267
human annotations
- chest of a dog, a bird, a snake in the grass, a tombstone, a dog near a shelf, a boy playing in water
- animals
- necks of dogs
layer4-1507
human annotations
- a bridge with cables, a snake, aquatic life, a man holding a fish
- animals, chains and bridges
- a striped pattern
layer3-297
human annotations
- support pole to a mega phone is attached to
- bottles, poles and cylinders
- the area around a meeting of 2 colors
layer2-109
human annotations
- dots on animals, clocks and vehicles
- red dots on different objects
- red areas in pictures
layer4-220
human annotations
- cords, furniture and plates
- item with lines
- items with straight lines
layer4-441
human annotations
- animals and electronics
- black poles and brown animals
- wildlife and entertainment, such as electronics and exercise equipment
layer4-721
human annotations
- bird, people on a row boat
- lipsticks, birds, balls, android
- ball, lipstick, person, cake
layer4-1988
human annotations
- people and vehicles
- red accented objects
- red, black or white items
layer3-309
human annotations
- human legs and the circles of color
- hairy or have lines in them
- the front of things
layer1-244
human annotations
- the color pink and red
- pink objects and lighting
- red and purple areas
layer4-345
human annotations
- curved lines
- object with curved, smooth features
- neck braces
layer4-307
human annotations
- animals and circular objects
- brown animals
- similar color patterns
layer4-1033
human annotations
- animals and circular objects
- faces and birds
- person, nature
layer4-1333
human annotations
- animals, vehicles, and pinecones
- brown and black animals
- person, nature
layer2-406
human annotations
- dogs in front of a chain link fence
- eyes of dogs
- animal below eye
layer3-583
human annotations
- black objects with a dot of red or brown in the middle
- eyes of brown dogs
- heads of both people and animals
layer4-1200
human annotations
- animals, bricks and posting
- red and orange objects
- pictures of animal
layer2-322
human annotations
- yellow ear-tips
- a guitar pick in some string
- animal, food
layer3-62
human annotations
- brown dog eyes
- faces of dogs
- canine
layer3-155
human annotations
- legs of bugs
- insect, animal
- legs of animals
layer3-741
human annotations
- birds
- feathers on wings
- bird wings
layer4-1176
human annotations
- things with edges
- orange objects
- rounded edges in pictures
layer4-1647
human annotations
- two friends, door, kids forehead, a cabinet, trim of a room
- shelves and fences
- a lot of these show both empty and filled shelves or cabinets, the rest are doors and windows and some flowers on the ground
layer4-1862
human annotations
- birds and horses in snow
- buildings and animals
- two items that are connected
conv1-17
human annotations
- a bottle on a road, a octopus, a shark
- ocean water
- bright blue areas
layer2-176
human annotations
- spots of the color white
- the outline of animals
- animal, food, insect, plane, truck
layer2-270
human annotations
- the outline of objects with dots
- pale areas on or near subject
- red colored objects
layer4-822
human annotations
- forehead of a person, trees of a skyline, person's head. water fountain
- animals, fountains and trees
- textured objects or surfaces
layer4-496
human annotations
- animals and circular objects
- rounded objects
- people and animals and appliances
layer4-2029
human annotations
- items on surfaces
- flower, bird
- behinds of animals
layer4-1842
human annotations
- light switch, ethernet port, person playing the guitar
- furniture, tables and guitars
- items with angles
layer3-203
human annotations
- the space above red items
- rocks, water, person, plant
- similar patterns
layer2-474
human annotations
- the color red
- red and yellow objects
- red objects and animals
layer4-151
human annotations
- square objects
- rectangular objects
- cubed objects
layer4-194
human annotations
- towers, homes and animals
- textured objects
- winter trees
layer4-1225
human annotations
- animals, appliances and mounds
- straw and hands
- rounded edges in pictures
layer4-1103
human annotations
- yellow objects
- hands
- yellow features
layer2-507
human annotations
- straight, white, lines
- grids and diagonal lines
- rounded edges in pictures
layer2-397
human annotations
- few tomatoes for sale in a display rack
- pink and red dots
- red dots and eyes
layer3-862
human annotations
- objects surrounded by grass and foliage
- light reflections in the background
- green plants and twigs
layer4-72
human annotations
- reflective and white backgrounds
- arched objects
- have rounded tops
layer4-1746
human annotations
- dogs walking along the grass, a stick to hit a bell with, someone is taking shots out fo a syringe
- wooden objects
- wooden and stick shaped objects
layer4-1770
human annotations
- beetles on the sand, snail. person diving
- items on other objects
- animal, nature
layer4-1021
human annotations
- water towers in the distance, a clock tower's base, a spoons handle, a large two story building
- windows, buildings, water towers and pins
- animals, people, nature, building, water tower
layer4-1377
human annotations
- food and animals
- animals, fabric and texture
- living things
layer1-40
human annotations
- space on a circle of guitar picks
- dogs
- designs on objects
layer2-477
human annotations
- street lights
- space at the top of a dress, space at arches of a mansion or large building, space at the bottom of a monument
- small lights on buildings
layer4-44
human annotations
- poles, handles, legs and lamps
- legs
- the dog has a round nose just like the glass has a round base
layer3-657
human annotations
- wooden tables
- wood grain
- wooden
conv1-15
human annotations
- a belt, a guitar pick
- black and white stripes
- animal, mask, radio
layer2-506
human annotations
- aquatic life and objects in the sky
- a line in the middle of area
- specific patterns
layer4-32
human annotations
- wooden instruments
- hearts on them
- wooden objects with holes in them
layer3-963
human annotations
- stripes
- slits
- a feature on an object that is doubled
layer4-768
human annotations
- animals, boxes, rulers and boats
- white dogs
- pictures of animal
layer4-1946
human annotations
- people and cakes
- human arms
- shoulders and mouths
layer4-1837
human annotations
- a phone on the cabinet, a mower, a girl sitting on a bench
- objects with curve features
- areas where two items are connected
layer1-210
human annotations
- spots of the color white
- a bird landing, a bottle washed, a cricket, a fish in the ocean, fruit on a branch, people performing
- sharks as well as household objects
layer3-415
human annotations
- the background around the animals
- areas that contain yellow or orange
- dogs
layer4-128
human annotations
- animals and the sky
- animal legs
- the entirety of an animal
layer4-469
human annotations
- brown objects and containers
- amber liquid
- rounded edges in pictures
layer4-730
human annotations
- a man holding a ball, a flamingo, a man holding a trumpet
- animals, shovels, jewels and metal objects
- objects with curves
layer1-103
human annotations
- a dog sitting on a sofa
- circular objects
- parts of the top outlines of things
layer3-378
human annotations
- grass
- the area around angles and some lines
- grass or dirt areas
layer3-836
human annotations
- mouths
- dog faces
- a lot of mouths, mostly dogs but also a couple of humans
layer3-695
human annotations
- spots of white and blue
- produce, food and electronics
- red objects
layer4-973
human annotations
- animals, remotes and cylindrical objects
- small furry animals
- corners
layer2-129
human annotations
- spots of the color white
- separate color areas
- the sky, person, clock, animal
layer3-972
human annotations
- shelves of different objects
- parts of things that are rounded
- round or cylindrical things
layer4-260
human annotations
- people, bottles, and poles
- plastic items
- baby, child, fruit, bottle
layer4-422
human annotations
- graphics on a crockpot, guitar pick, carpet, snake
- animals and carpet
- textured areas
layer4-1089
human annotations
- a bird in the wild, a dog, a semi truck going down the street, a lizard
- animals, vehicles, vases
- animals and vehicles
layer4-2026
human annotations
- a shelf behind a sofa, a books shelf behind a man
- books on a bookshelf
- books
layer3-40
human annotations
- dog noses
- eyes and noses on dogs
- noses of animals
layer2-509
human annotations
- the space above a camera, a four poster bed, a coffee machine, a row of slot machines, a spiral ceiling with between each one, spaces on a typewriter
- wooden objects
- pieces of bigger structures
layer4-812
human annotations
- animals and metal objects
- animals, cars and containers
- bottles
layer3-875
human annotations
- animals, produce, and circular objects
- round objects
- small round objects
layer4-1137
human annotations
- table and chairs, bus, car, person sitting down in a chair
- animals, vehicles, keys and furniture
- items with straight features
layer4-1551
human annotations
- a musical on stage, a person at an atm, a person hiking, a person on a snowmobile
- people with straps
- outdoor activities
conv1-2
human annotations
- audio equipment
- nothing highlighted
- nothing
layer2-50
human annotations
- orange dots
- varying degrees of reds, oranges, and yellows
- orange areas in picture
layer4-31
human annotations
- round colorful objects
- animal faces
- hands or things shaped like fist
layer4-382
human annotations
- brown animals
- animals
- living creatures
layer4-599
human annotations
- lines with gaps and dots
- left and right side of a cat, boys face, pill bottle, people looking at a menu, people looking through a drain
- animals, crosswords and grids
layer4-1095
human annotations
- balls and cylinders
- dogs with tennis balls
- balls
conv1-4
human annotations
- a basket with it
- clocks and baskets
- more sitting of the chairs
layer3-407
human annotations
- orange and red objects
- a two tone color gradient
- colorful things
layer3-1006
human annotations
- body parts, bottles and a remote
- white skin
- skin and objects with similar colors
layer3-908
human annotations
- animals, toys and bottles
- black outlines
- mug, stuffed anima, insect, rodent, person
layer4-1362
human annotations
- objects on fire and straight lines
- fire and the sun
- flames
layer4-1665
human annotations
- a person holding a sign, a man laying down on the sofa with his dog
- curved items
- person
layer3-742
human annotations
- cups and bowls
- bowl shaped objects
- coffee maker, cup, bowl, plant
layer4-231
human annotations
- animals and black and white objects
- objects with text or texture
- things that are black and white
layer4-1338
human annotations
- chest of people wearing skirts
- dresses and poles
- dresses and skirts
layer4-1850
human annotations
- water towers and round objects
- hands, and things that look like martini glasses
- items with curves
layer2-4
human annotations
- repeating edges and boundaries with round shapes
- sign, guitar, water tower, sky, person
- long objects
layer2-471
human annotations
- spots of the color white
- dots of various colors
- lighter areas
layer2-313
human annotations
- the front of a vow bus
- every item is in layers upon layers
- car cross a road
layer3-341
human annotations
- the corners and borders of objects
- the text bellow a bunny, vegetables
- lighter areas
layer3-98
human annotations
- objects in the sky
- planes and flags
- things that are in the air
layer4-987
human annotations
- animals, vehicles, poles and windows
- objects or areas with lines in them
- bugs
layer4-1660
human annotations
- animals and signs
- items in the central focus
- brighter areas on objects
layer4-1845
human annotations
- food, a dog wearing a skirt, aquatic life
- animals and circles
- items with straight features
layer3-3
human annotations
- beaks of birds and ears of dogs
- beaks of birds
- the backgrounds are all bright in contrast to their focal points
layer2-183
human annotations
- spots of the color white and clothing boundaries
- white skin
- human skin
layer3-748
human annotations
- noses and embossed items
- animal noses and objects that resemble them
- similar patterns
layer4-295
human annotations
- animals and electronics
- square objects
- electronic devices and watches
layer4-1618
human annotations
- right side of a kid, a dog playing with his toys in a field, eggs in a cage
- items that are rounded
- animals, people, ball
layer4-1126
human annotations
- pocket holder, animals, bulding
- animals and screens
- edges
layer2-510
human annotations
- spots of the color white
- left and right of a zebra's ears, spaces on a dogs jacket, a hog in their, a horse in the farm
- random spots
layer3-47
human annotations
- the area between stems and tops
- rounded spaces
- rounded edges in pictures
layer4-1239
human annotations
- curved edges on objects
- animals, food and circular objects
- red and orange objects
layer4-317
human annotations
- animals, plaques and other square objects
- faces on animals and objects
- brown dogs
layer4-1502
human annotations
- a person holding an axe, a armadillo
- sticks and necks
- long stick-like objects
conv1-26
human annotations
- stripes of a zebra
- the space directly running along the side of a curved strap
- animal, clock, logo, person
layer3-258
human annotations
- things that are longer that they are wide
- the images stripped objects
- stripes in picture
layer4-40
human annotations
- animals, vehicles and benches
- large spiders
- top of vehicle
layer3-620
human annotations
- poles and sticks
- wooden objects and branches
- birds
layer4-856
human annotations
- babies and striped objects
- faces of people
- items that have straight features
layer4-845
human annotations
- tall perpendicular lines
- animals and poles
- shaggy dogs and poles
layer4-1811
human annotations
- duck on the water, parrot
- animals, water and food
- items with triangular features
conv1-11
human annotations
- transportation, a shower head, a piano
- the outlines of objects
- moped. piano, chair
layer3-474
human annotations
- parts of objects with wavy edges
- necklaces
- rounded edges in pictures
layer3-466
human annotations
- heads of different birds
- faces of various colorful birds
- bird heads
layer4-471
human annotations
- objects with more than one curved line
- animals
- black bugs
layer4-1366
human annotations
- animals
- dark animals and objects
- black dogs
layer3-293
human annotations
- animal ears
- an animal's ears
- the ears on an animal at rest
layer3-461
human annotations
- arches and wheels
- wheels
- rounded edges in pictures
layer3-615
human annotations
- white and wooden poles and chins
- area on an object where red transitions to a lighter color
- neck braces and red tops
layer4-972
human annotations
- animals, water and plaques
- objects with fur or lines
- bugs
layer4-1399
human annotations
- bird, dog, fox
- legs and objects that resemble them
- animal, ladder, person
layer4-1682
human annotations
- vehicles, backgrounds and smoke
- smoke
- smoke
layer1-212
human annotations
- tips of an airplanes wing
- dots outlining a object
- the outlines of pointed areas
layer3-476
human annotations
- ears and similar shaped objects
- dog ears
- shaped like ears
layer4-123
human annotations
- furniture
- seating areas and pillows
- clothing, pillow, animal, person. free weights, sofa
layer4-466
human annotations
- animals, furniture, chains and buildings
- brown dogs
- things that can be held
layer4-1413
human annotations
- vehicles, grass, sax, and food
- textured surfaces
- person, food, vehicle, nature
layer4-1801
human annotations
- gravel near a river, table people are dining at, trail, rocks on a surface, fountains
- items with curved features
- similar color patterns
layer2-377
human annotations
- shark pin, spiders legs, spaces a camera lense, wires of a cassette tape
- outlines of black circles
- animal, fruit
layer1-147
human annotations
- an orange, a whale with text bellow space enclosed
- dots outlining a object
- sharks and the ocean
layer3-581
human annotations
- things shaped like flowers
- flowers with petals
- animals in pictures
layer4-68
human annotations
- striped poles and animals
- striped
- insect, socks, stripped objects
layer4-624
human annotations
- mirror of a semi, a gear on some sort of meter, two people gliding with the help of a parachute, birds in flight, a musician on stage, tree
- animals and wooden objects
- pictures of animal
layer4-909
human annotations
- animals, water and poles
- animals and rod shaped items
- skinny poles
layer2-281
human annotations
- ant on the ground, a dog on the sofa, a clock on the wall
- letters and numbers
- signage and eyes
layer3-136
human annotations
- flowers, animals and metal
- base of nail or cylinder
- striated lines
layer4-140
human annotations
- black and white animals
- black dogs
- black fur or clothing
layer4-1249
human annotations
- keyboards, laptops, people, and dots
- keyboards for computers
- surfaces in them
layer4-848
human annotations
- faces and animals, and objects that may resemble them
- something with zig zag lines
- items that are the central focus
layer4-1790
human annotations
- fruit in a basket, dog, wine glass, guitar, fish
- animals, food, musical instruments and carts
- items with angles
layer2-288
human annotations
- a polar bear carry a disk
- red booths and vehicles
- red in the colour
layer2-272
human annotations
- circles and repeating lines
- stripes objects
- similar patterns
layer3-988
human annotations
- ears of animals
- the ears of animals
- ears on animals
layer4-976
human annotations
- people, cookware and vases
- textured areas
- portions of several people's faces, as well as random corners of other assorted items
layer3-949
human annotations
- the sky or lights
- blue skies
- the sky
layer4-1800
human annotations
- a bird in the grass, a kid on the dishwasher, dogs, people cooking food
- sides of objects
- inspect, food
layer4-1706
human annotations
- an elephant walking forward, a statue, a moped, a bird on a branch, a old soldier
- animals and people
- appendages
layer3-240
human annotations
- animal faces and corners of objects
- sides of a hotel
- gaps in objects
layer2-58
human annotations
- things that are the color purple
- no pattern or highlight
- specific patterns
layer4-94
human annotations
- poles, animals and circles
- fencing and white lines
- animal, person, water bowl, hand, road
layer4-505
human annotations
- animals, patterned objects and stores
- patterns on surfaces
- clothing
layer4-1228
human annotations
- animals, lights and firearms
- scorpions
- things outside
layer4-2018
human annotations
- star fish, dress
- curved features
- edges of objects
layer2-463
human annotations
- fruits and vegetables, bottle, spaces on the suite of a soldier
- curved objects and legs
- please have a gradient of color
layer2-90
human annotations
- a hot air ballon, a fish in the sea, a couple birds on a stump
- the edges of things
- red lettering
layer3-613
human annotations
- vehicles and other metal objects
- white vehicles
- solid sides of metal objects
layer3-724
human annotations
- the background
- green grass
- blue and white backgrounds
layer4-1585
human annotations
- insects and sea creatures
- animals, striped objects and furniture
- areas with many lines
layer4-1572
human annotations
- a dog in the grass, puppy, a person doing acrobats, a panda. adog walking down the sidewalk
- animals, balls and shells
- brown dogs
conv1-52
human annotations
- space above a old typewriter or building
- household materials and pets
- white objects
layer3-493
human annotations
- the area under animals and circles
- dogs
- rounded edges in pictures
layer4-964
human annotations
- faces of people and containers
- people, dishes and blinds
- rounded edges in pictures
layer4-1877
human annotations
- fox or animal
- angles
- faces of animals
layer2-443
human annotations
- the front of a car grill,beams of a bridge, letters of a speedometer
- striped objects
- edges of vehicles and black lines
layer2-47
human annotations
- a spiral slide, a man fixing a women's hair, a musician playing at a table
- poles
- office equipment
layer4-107
human annotations
- square objects with a handle
- switches, furniture and things with wings
- two lines that are connected by a third area
layer4-766
human annotations
- colorful decorations
- contain items that are on other items
- pictures of animal
layer4-1079
human annotations
- man's hand, tents on a beach, a pan on the sink
- chains, grass and tent shaped items
- items on other items
layer4-1408
human annotations
- animals, words, and flower buds
- curved shapes
- animals, nature
layer2-292
human annotations
- the color blue bordering orange
- person's jacket
- blue in the colour
layer3-1000
human annotations
- the bodies of dogs
- dog torsos
- bodies of brown dogs
layer3-70
human annotations
- the area around heads and remotes
- heads of different animals
- edges of objects
layer3-960
human annotations
- bird necks
- necks of birds
- pictures of birds
layer4-778
human annotations
- animals and pens
- long, thin features on an object
- paddles for kayaks
layer4-2045
human annotations
- animals in the wild
- animals, carts and buildings
- things outside
layer4-1540
human annotations
- a dog holding a soccer ball, a kid doing gymnastics, a kid wearing a shower cap
- animals, balls, furniture and trucks
- the regions have items with angles
layer3-448
human annotations
- hands of people
- hands and feet
- hands and paws
layer3-976
human annotations
- multiples of each item, and all the multiples have either different colors or different shapes
- multiple objects
- the middle of objects
layer4-646
human annotations
- animals, clocks and screws
- circular objects
- rounded objects
layer4-485
human annotations
- umbrellas and curved lines
- handles and umbrellas
- red objects
layer4-1490
human annotations
- a dog in a cage, a mouse, a sky
- animals, pencils and water
- speckled
layer4-1522
human annotations
- ducks in a pond, hand of someone, mouse trap, hand
- hands and birds
- hands
layer1-113
human annotations
- yellow objects
- nothing highlighted
- brighter areas within objects
layer3-255
human annotations
- flowers and spots of white
- clothing on a mannequin or real person, left and right of an object, a person posing for a picture with or without their dog
- pale, skin tone, and red colored spots
layer3-612
human annotations
- trees
- trees
- foliage in the background of an image
layer3-641
human annotations
- stripes and dots
- striped snakes
- fish, animal, snake, flower, person, sand
layer4-1962
human annotations
- legs of people and water in a background
- legs or water
- chest and legs
layer4-1321
human annotations
- birds and the sky
- animals, food and the sky
- sky, clouds, hats, birds, and geometry
layer2-68
human annotations
- electronic devices
- half of two shades of color
- orange areas in picture
layer4-338
human annotations
- faces
- sunglasses
- glasses in them
layer4-293
human annotations
- animals, poles, and water towers
- sharks
- nature
layer4-1691
human annotations
- bug, fish
- animals
- animals, both that live on land and live in the water
layer4-1617
human annotations
- bike, soldier in uniform, a bird on a branch
- motorcycles
- blue or bikes
layer3-77
human annotations
- the color brown
- aquatic life
- brownish color
layer2-342
human annotations
- beer bottles on a shelf
- red edges and blue skies
- gauge, sign, tooth, crane, sky
conv1-21
human annotations
- clock's rim
- black lettering
- tiny bits of thin areas
layer3-166
human annotations
- thin cylinders
- barbels
- barbell like objects
layer3-1005
human annotations
- parts of gold things
- food in people's mouths
- thing that people may put near their mouths
layer4-818
human annotations
- windows, needles and furniture
- tiles of different kinds
- a crisscross shape
layer4-515
human annotations
- splashing water
- water and remotes
- water sources
layer4-1827
human annotations
- animals, cars, birds,people
- animals and windows
- animals
layer3-235
human annotations
- a dog collar, a persons mask, a snake, a dog collar, a person posing for a photo
- green leaches and other i shapes
- animal collars
layer1-255
human annotations
- the mouth of a shark where its teeth are
- words or outlines of animals and boats
- black lettering
layer4-53
human annotations
- faces of animals
- animals, tacks and necks
- metal hooks
layer4-308
human annotations
- animals and golden objects
- metal objects
- logo, door handle
layer4-717
human annotations
- a kid on a pole, a money in the trees, a dog in the grass
- animals and hook shapes
- animals
layer4-1961
human annotations
- animals and foliage
- fur, grass and mops
- human hands
conv1-42
human annotations
- letters of a clock, a ambulance
- black letters and numbers
- the edges surrounding a thin, black colored space
layer2-402
human annotations
- outlines or sticks, poles and bird parts
- steel towers and birds
- brighter areas within objects
layer2-208
human annotations
- spots of the color white
- cats and dogs
- lighter areas
layer4-78
human annotations
- animal parts and rounded corners
- small brown animals
- legs or upper body of animals/humans
layer4-475
human annotations
- animals and fruits
- animals and objects that resemble them
- pictures of animal
layer4-1322
human annotations
- aquatic life, tire on a trailer, a bird on a branch, a person's forehead
- people, wheels, poles and birds
- people, nature
layer2-442
human annotations
- white and black borders
- washing machine, ironing device, my player, a maze of stairs and guard rails
- circular objects that are mechanical
layer2-172
human annotations
- edges of objects and bottles
- red objects
- brighter areas in objects
layer4-113
human annotations
- people and animals
- animals and humans
- baby faces
layer3-929
human annotations
- ears, winds, and tails
- wings, tails and fins
- parts of different birds
layer4-1030
human annotations
- food items and animals
- space arond a man's shirt, frog, pancakes
- brown objects
layer4-1524
human annotations
- dog, a butterfly on a leaf
- living things
- animal
layer1-51
human annotations
- borders of objects and text
- space on a soldiers jacket guarding the palace
- dots and diagonals outlining a object
layer1-127
human annotations
- instrument, speedometer, cactus on a beach, fruit
- {these are diagonal lines
- lines that are next to each other
layer3-158
human annotations
- orange objects
- orange areas
- objects with red and orange
layer3-907
human annotations
- the sky at the top of a photo
- the sky and the walls
- land animals
layer4-928
human annotations
- animals
- objects with lines
- large spiders
layer4-1316
human annotations
- base of a pole, a puppy, a car in a drive through, a dog
- animals and poles
- human hands
layer1-234
human annotations
- the color blue
- dogs
- blue areas in pictures
layer2-170
human annotations
- white objects surrounded by a single color
- the noses of different dogs
- specific patterns
layer4-390
human annotations
- fur and objects with intricate line features
- dogs and cats
- animal, fence, ship, person
layer4-754
human annotations
- animals and buildings
- birds
- birds
layer4-1069
human annotations
- animals and boats
- green grass
- animals or plants
layer4-1508
human annotations
- a deer in the woods, a elephant, a dog, a fox
- animals, lines and laptops
- objects with black and brown color
layer3-198
human annotations
- black and white borders with repeating lines
- a butterfly
- the colors white and black and some lines and support beams
layer3-19
human annotations
- a bird beak on a branch, dogs muzzle
- beaks of different birds
- mouth
layer3-117
human annotations
- circular objects and green ones
- green spots
- straight lines in these regions
layer3-764
human annotations
- walls and electronics
- dogs
- person, led
layer4-952
human annotations
- boxes and books
- boxes
- boxes
layer4-2031
human annotations
- animals and bottles
- areas where objects or shapes repeat
- items that are similar to each other
layer4-1918
human annotations
- boat, horse, food, boat
- objects with red, yellow or brown areas
- two items that are connected
layer1-246
human annotations
- feathers of a bird
- these images all show lines within them
- patterns
layer2-49
human annotations
- lines that cover a background
- pale areas in between dark lines
- patterns
layer4-199
human annotations
- whitish animals and pillows
- small white animals
- triangular features
layer3-703
human annotations
- animals and things on shelves
- bottles and heads
- the tops of objects
layer4-1445
human annotations
- animals
- ears of animals
- animal, nature
layer4-1997
human annotations
- a lizard, means of transportation, aquatic life, a bird, a do
- heads, towers, and office things
- animal, nature, helicopter
layer1-204
human annotations
- spots of the color white
- text on the side of an airplane, sunglasses hanging on a rack, a bird on a branch
- pale areas next to dark areas
layer3-50
human annotations
- these look at two tone patterns
- black surrounded by single color background
- human eyes and wooden objects
layer4-254
human annotations
- animals
- black figures
- these look cloaked like a hood
layer4-756
human annotations
- animals with fur
- mugs and bowls
- rounded edges in pictures
layer4-705
human annotations
- animals and orange objects
- objects with orange and white
- birds with orange stomachs
layer4-1512
human annotations
- towers and clothes
- mansions or flag poles
- items with peaks
layer1-93
human annotations
- a butterfly on a leaf
- outlines of white areas
- dots on different types of butterflies
layer3-113
human annotations
- noses of dogs and edges
- round edges of objects
- gaps in between things
layer3-813
human annotations
- objects with dots and holes
- patterns made of small items
- book, phone, boat, food, label
layer4-582
human annotations
- poles, pots, animals, and curved objects
- rounded objects
- part of rounded items
layer4-922
human annotations
- butterflies and circular objects
- vegetation
- colored produce
layer3-252
human annotations
- colors of the outdoors
- space on a classic truck towards the back, a wrapped up golf club
- animal
layer1-53
human annotations
- areas with black lines in them like stripes
- the lines on the zebras and the horizontal lines the girls' legs are making in a jump are resemblance
- objects containing stripes
layer3-567
human annotations
- animal faces and electronics
- eyes of land animals
- food, animal, toaster
layer3-591
human annotations
- buttons, words and stripes
- buttons on electronics
- writing on them
layer4-1204
human annotations
- animals and domes
- knob shapes
- older towers and dogs
layer4-1318
human annotations
- ceramic animals and animals with fur
- animals and circular objects
- items that are rounded
layer3-361
human annotations
- containers and bottles
- these objects are tube-shaped
- containers that hold things
layer2-115
human annotations
- red objects surrounded by backgrounds
- grass, dog, candle, table
- spotted areas in pictures
layer3-954
human annotations
- animals, rocks, and rims
- brown dogs
- tops of objects
layer4-243
human annotations
- mammals, birds, and wooden surfaces
- animals and tables
- similar color patterns
layer4-1361
human annotations
- dogs and brass instruments
- shiny areas
- circular
layer4-1389
human annotations
- these re circular objects, guitars, backs, and clothes
- green trees
- dog, clothing, basket
layer3-303
human annotations
- dogs
- face of animal
- canine and feline faces
layer2-225
human annotations
- white lettering and land animals
- straight lines
- parts of thin lines
layer4-207
human annotations
- wooden and other patterned objects
- brooms
- look like an ear of corn
layer4-545
human annotations
- dog walking in grass, a parrot in the trees, a mouse loking at another mouse, foot of a dog, toy container, bottom of skirt
- animals
- white shaggy dogs
layer4-1255
human annotations
- cars, boats, and rivers, a race competition, a climber on the side of a mountain
- vehicles, animals and sticks
- object against background
layer4-1518
human annotations
- animal, elbow
- animals and torches
- items with angles
layer3-294
human annotations
- noses on dogs
- the images have black in them
- brighter areas within objects
layer3-74
human annotations
- people playing string instruments
- musical instruments and leashes
- musical instruments
layer4-124
human annotations
- animal heads and rock formations shaped similarly
- faces
- faces of people
layer4-841
human annotations
- a dog in the grass, a front side of a wallet, a crossword puzzle with pen, spider hanging, stem of an apple, elephant trunk, bird on a branch
- animals and pen shaped objects
- dogs and greenery
layer4-961
human annotations
- bird on a pole, person holding a shovel, neckline of shirt, sign someone is holding
- people and poles
- wooden poles
layer4-1786
human annotations
- clear view of a white and blue sky
- multiple items that are similar
- backgrounds in pictures
layer1-197
human annotations
- graphic on a package, stripes on a hat, lines on a jet
- stripes or dots in them
- things with ridges
layer3-124
human annotations
- yellow dots
- faces of animals and small balls
- tags and name plates that are on things
layer4-1172
human annotations
- animals
- brown dogs and cats
- pictures of animal
layer4-1003
human annotations
- dogs, electronics and brick wall
- areas with dark, thin objects
- human hands holding objects
layer1-7
human annotations
- space on the letter's on a volley ball, a hawk flying through a sky
- white outlines of certain areas
- logo, doll, animal
layer1-117
human annotations
- electronics and white shirts
- borders
- lighter areas
layer3-566
human annotations
- white backgrounds and patterned objects
- brown items with ridges
- nature, animal, person, white background
layer4-216
human annotations
- fabric, wood, and windows
- drapes and curtains that are red
- curtains and rugs
layer4-542
human annotations
- animals and stick objects
- areas containing lines and patterns
- skinny wooden objects
layer4-863
human annotations
- black and white objects and animals
- animals and grass
- texture areas; scales, fur, water and rock
layer1-8
human annotations
- spots of the color white
- spaces on a dogs face, a space on a cat's head
- animal, logo, person, truck
layer1-126
human annotations
- rims of a wheel
- white and black lettering
- text like images
layer4-25
human annotations
- long needles and handles
- the things that have a long area connected to a rounded area
- weight, pan, plunger, soup, trailer
layer3-841
human annotations
- outlines of people and animals
- hands of humans
- a blocked design
layer4-673
human annotations
- objects that have a light source
- lens flares
- bright spots
layer4-1363
human annotations
- vehicles, signs and barrels
- parts of trucks
- square and rectangular geometry
layer4-1925
human annotations
- box, building, birds, shoes, table
- items with designs
- edges of objects
layer4-183
human annotations
- wild animals and nature
- animals, food, and things with bumps
- italian food and sea creatures
layer4-790
human annotations
- the road, vehicles and counters
- animal, nature, road, limo
- rounded edges in pictures
layer4-959
human annotations
- animals and musical instruments
- human hands
- long, thin items in them
layer4-1477
human annotations
- an re or a trailer, a house, a to, a dog
- windows or front panels on a number of different buildings and items
- items with angles
layer3-280
human annotations
- space above a blooming flower
- green plants
- out of focus textures interacting with lighting (or bokeh)
layer3-33
human annotations
- red lipsticks
- light tube shaped objects such as arms or handles
- arms and stems of objects
layer2-0
human annotations
- spots of the color white
- wildcat animals
- light sections of tan
layer2-390
human annotations
- vertical outlines of a object
- small dots and skinny poles
- shark, person, water, pumpkin
layer4-265
human annotations
- animals
- furry or hairy objects
- brown haired animals and humans
layer4-747
human annotations
- birds
- items with curved areas
- things outside
layer4-1029
human annotations
- round objects with holes
- objects with curved edges
- bathroom appliances
layer4-1761
human annotations
- pen, a bus in a field, space on the left side of a book, a decorative shelf, a kid eating a snack
- pencils, pens, and other curved objects
- items with straight features
conv1-6
human annotations
- borders of objects
- a picture of a bunny with text below it
- around the main object
layer2-293
human annotations
- stripes on a shoe
- black and white stripes
- the stripes of the colour
layer2-235
human annotations
- blue objects
- blue areas on an object
- almost impossible to discern what these objects are
layer4-27
human annotations
- circular objects and pens
- metal objects
- round items like clocks
layer4-544
human annotations
- arms
- blue shirts
- arms of things
layer4-784
human annotations
- animals and things with poles or legs
- long, thin objects
- rounded edges in pictures
layer4-1489
human annotations
- casino slot machine, shirt someone's wearing, cabinet dresser
- hands and poles
- items on other items
layer2-194
human annotations
- tongues of dogs
- parts of background images that are light colors such as white or pink
- red areas in picture
layer3-38
human annotations
- beaks of cranes
- heads and tails of animals, musical instruments and paddles
- rounded edges in pictures
layer4-1217
human annotations
- basket, bird, fence
- baskets, fences and grates
- baskets
layer4-298
human annotations
- balls and appliances
- balls and rounded objects
- small red round objects
layer4-1481
human annotations
- dog, computer screen, dogs, pasture
- animals, appliances, and the ground
- items on other items
layer3-452
human annotations
- circular objects like leashes and mouths
- collars for animals
- rounded edges in pictures
layer3-433
human annotations
- circular areas of animals
- a pattern like a shell
- rounded edges in pictures
layer4-319
human annotations
- animals and poles
- household objects
- rounded edges in pictures
layer4-1764
human annotations
- a dog on the ground, a spider, truck, a van in a drive through, a tomato, a beetle, a women sitting on a bench
- animals and vehicles
- animals, people, insect, truck
layer4-1778
human annotations
- floor of a room, dog in the room, front of a dog, a table with flowers, a station with lettering on theground
- windows, tables and floors
- two items that are connected
layer2-316
human annotations
- musicians on stage, right side of a cat
- pink outlines of clothing and doorways
- pink or purple areas
layer4-51
human annotations
- buttons and faucets
- lawn mower, screw, outlet, type written, dog, sign
- similar patterns
layer3-440
human annotations
- insect legs
- legs of insects
- spiders
layer4-617
human annotations
- animals and hobbies
- brown dogs
- people and dog faces
layer4-431
human annotations
- animals and plaques
- animal faces and rectangular objects
- dogs
layer4-1676
human annotations
- shopping cart, wine glass, guitar
- animals, guitars and cups
- two items that are connected
layer2-21
human annotations
- firetrucks, a camera, a vaulted dome ceiling, a radio with knobs, text on a computer screen
- areas adjacent to black spots
- arched lines
layer2-476
human annotations
- spots of the color white
- the bottom of lines
- small gaps of space directly underneath a little black object
layer3-711
human annotations
- birds and turtles
- bird necks
- include birds
layer4-885
human annotations
- fur of animals and keyboards
- grids, buttons and fur
- objects with dark spots
layer4-942
human annotations
- between two trees, birds int eh water, a person playing with magnifying glasses, a sail in the sky
- thee are birds and things that look like coils
- mouths and parachutes
layer4-1708
human annotations
- a man standing next to a dog, a dog looking right
- eye or eye-chaped crevices on faces or face-like objects
- these objects have items that are curved
layer3-395
human annotations
- household appliances
- pure white background
- white areas in picture
layer4-4
human annotations
- round objects with circular patterns
- mesh
- similar patterns
layer4-455
human annotations
- objects in cases, animals and structures
- furry animals
- pictures of animal
layer4-752
human annotations
- handles, rooms and poles
- long lines and corners
- metal objects
layer4-2028
human annotations
- faces of friends, na kid on the floor, dog's face, ambulance, beetle
- eyes of pets and people, as well as a bunch of different types of vehicles
- items that are connected
layer4-1848
human annotations
- keys, boxes and ladders
- multiple items that are similar
- rounded edges in pictures
layer2-472
human annotations
- blimp in the air, penguins walking around, a speedometer, a van going down theroad, flowers around a dog
- the ears of different animals
- orange areas in picture
layer3-431
human annotations
- beige backgrounds
- tan and green colored spots
- the edge of objects or things
layer3-889
human annotations
- red items
- orange objects
- logo, person, water, animal, machine, apples
layer4-314
human annotations
- animals and dome shapes
- domes and bottles
- bottle, vase, dog, fencing, animal, roof
layer4-1057
human annotations
- tennis ball someone is wearing, a frog in a basket, insects, a baseball on the grass, a shark in the ocean
- animals, columns and balls
- small bugs
layer4-1685
human annotations
- trees
- the sky
- sides of objects
layer2-35
human annotations
- colored shirts
- red and blue colored objects
- spots of color on crafted material
layer3-973
human annotations
- horns and beaks of animals
- antlers of animals
- sharp objects
layer4-570
human annotations
- animals, metal objects and tools
- arms and long, thin objects
- objects in peoples hands
layer4-482
human annotations
- numbers and text
- text and patterns
- snakes
layer4-1077
human annotations
- seems of elvis, a girl dancing on a drain, a bird on the grass
- animals, water and jeans
- brown monkeys
layer4-1672
human annotations
- butterfly, monkey, my player, dog
- nature, animal
- pictures of animal
layer3-200
human annotations
- the taillight or headlight of a car or truck. kid wearing a glove, window on a door
- rectangular button like objects
- handle, glove, light
layer2-154
human annotations
- grass and the color green
- green areas on or around subject
- green grass and trees
layer4-3
human annotations
- animals and towers
- stone towers
- objects that are on or nearby other objects
layer4-1177
human annotations
- water and animals that are gray
- fur texture and bodies of water
- human hands and water
layer4-772
human annotations
- striped objects
- lines and grids on objects
- backgrounds in pictures
layer4-1476
human annotations
- dog, top of a building, desert sand, pasture, group of people
- animals and natural backgrounds
- backgrounds in pictures
layer4-1926
human annotations
- people, gourds and flags
- areas with blue or red hues
- celebrations and holiday items
layer1-94
human annotations
- a dog chases a ball
- the edges of where a particular color is changing into another color
- edges of objects
layer2-189
human annotations
- highlights of rounded objects
- the lines and edges of similar
- a series of lines
layer3-868
human annotations
- spots of color and repeating lines
- animals and brushes
- dogs
layer3-941
human annotations
layer4-694
human annotations
- dogs, shoes, horses
- animals, furniture, and tools
- human legs
layer1-124
human annotations
- a motorcycle in the distance, a snowmobile, a sleeping bag, a flock of birds
- white areas surrounding objects and text
- aquatic life and the ocean
layer3-500
human annotations
- the is water
- bodies of water
- water areas
layer3-890
human annotations
- walls, sky and buns
- brown dogs
- empty wall space in background
layer4-1168
human annotations
- animals, mops and food
- face coverings
- rounded areas that are sticking out
layer4-1374
human annotations
- person's head
- hats and similarly shaped things
- colored hats
layer3-317
human annotations
- dog's head as it walks down the grass
- animal necks
- dog faces
layer3-45
human annotations
- insects and windows
- features of an animal, log posts and cans
- similar patterns
layer4-178
human annotations
- poles
- skinny tall poles
- people and animals
layer3-728
human annotations
- archways of buildings and towers
- a circular region inside
- structure, electronic, cassette tape
layer4-1588
human annotations
- people, animals and railings
- white areas and faces
- person, boat, nature
layer4-1479
human annotations
- remote, horse, fox, bug, curtain of a bathroom shower, dog
- fish or animals
- angles
conv1-0
human annotations
- types of fungus
- a mushroom growing out of ground
- animal, fish, person, mushroom
layer3-1002
human annotations
- wood works and fur on animals
- dogs
- sticking up
layer4-20
human annotations
- animals, a baby and objects with faces
- dogs
- faces
layer4-449
human annotations
- animals, poles and curved edges
- dogs
- pictures of animal
layer4-761
human annotations
- animals and yellow and red objects
- rounded objects and structures
- yellow and red objects
layer4-1535
human annotations
- roads, railings, shelves and buildings
- items with straight features
- backgrounds in pictures
layer4-1830
human annotations
- a memorial, a ship at sea, a barn, a lighthouse, a dog
- animals, rails, boats and towers
- items with straight features
layer3-311
human annotations
- a dogs ear, a eye, a guitar in a case
- a curved edge in them
- edges of things
layer3-950
human annotations
- the indent in an hourglass shape
- stop watches
- hour glass, signs
layer4-869
human annotations
- animals, photos, pens and cassettes
- red accented objects
- insect, animal
layer4-1794
human annotations
- ballon, car, bird, ball someone is holding
- animals, allows and vehicles
- some birds, insects and balls, all of which spend time in the air
layer4-1834
human annotations
- conglomeration of colors
- a hot air ballon, a fruit, arts and crafts, a sail boat
- textured areas containing red hues
layer3-67
human annotations
- objects with parallel lines and repeating shapes
- aircraft
- the curved lines on a curved surface
layer2-327
human annotations
- gas gauge
- red lettering and bars
- the infrared light is red in color
layer2-29
human annotations
- repeating yellow lines and white holes
- color stripes
- specific patterns
layer3-483
human annotations
- white objects
- fountains
- fountains and similar things
layer4-389
human annotations
- food and balls
- small red objects
- fuzzy round object
layer4-1257
human annotations
- animals, boxes and white objects
- spotted dogs
- horizontal line
layer4-1439
human annotations
- pet, bird, drill
- animals
- black dogs
layer1-48
human annotations
- a bike's wheel, a bird walking on the beach
- the outlines or animals, cookware and baskets
- plant, food, person
layer3-618
human annotations
- animal heads and a camera
- brown dogs
- the colors brown and grey
layer4-465
human annotations
- marimba and wooden planks
- sticks, chains, xylophone and animals
- centers of items
layer4-667
human annotations
- animals and balloon shapes
- brown dogs
- either white objects, or dark objects against a light background
layer4-1823
human annotations
- parachutes in the sky, a drain cover, birds in the sky
- planes, birds and, designs
- multiple items that are similar
layer2-411
human annotations
- techno ridges
- a camera
- diagonal outlines
layer3-1008
human annotations
- buttons and small objects
- small dots and buses
- similar patterns
layer3-569
human annotations
- tripods for cameras
- diagonal poles
- things that have limbs
layer4-780
human annotations
- dogs, benches, mouths, birds and sticks
- mouths
- people, nature
layer4-1334
human annotations
- tables and objects that are outside
- containers and structures
- circular shapes, buckets, and ridges
layer4-1639
human annotations
- mouse, ree, plant, corner of a sign
- green objects
- the edges of items
layer2-308
human annotations
- dots of color
- a soap dispensary
- nothing highlighted
layer3-213
human annotations
- a lizard
- faces, walls and the sky
- areas with a line through it
layer4-5
human annotations
- animas and balloons
- objects in the sky
- hot air, ballon, animal, boat, horses, person
layer3-116
human annotations
- spots of the color white
- white backgrounds
- red objects
layer4-1147
human annotations
- patterned objects
- patterns on various objects
- contain objects that have straight lines
layer4-583
human annotations
- microphones
- circular objects and different types of animals
- animals and instruments and balls
layer4-1678
human annotations
- zebra, dog, armadillo, monkey, elephant
- the sky
- parts of the sky
layer1-181
human annotations
- head of a hammer head shark
- sharks
- nature, animal
layer2-511
human annotations
- spots of the color white
- a bird sits on a branch, a person plays an instrument, tables of vegetables for sell in a market
- brighter areas in objects
layer4-182
human annotations
- caps and plastic
- shower caps
- contain items with straight lines
layer4-846
human annotations
- papers, grates, water and rice
- white objects
- items with straight features
layer4-974
human annotations
- animals and circular objects
- round objects
- insect, animal, music instrument
layer2-92
human annotations
- spaces on the inside of a sock, a dress, a wing of a bird, a motorcycle, laundry in a washing machine
- spots that contain the color red
- snakes
layer3-109
human annotations
- skirts and dogs
- straight lines in them
- tent, animal, motorcycle, race car
layer3-643
human annotations
- animals and poles
- skinny bugs
- long, thin items
layer4-749
human annotations
- balls, windows and circular objects
- round objects
- small round red objects
layer4-1446
human annotations
- a man sitting on a beach, a dog at a vet, sea life, a sunset in the background
- animals, sunsets, oceans and lighthouses
- two items connected
layer4-1689
human annotations
- sunscreen bottle, pet
- animals and foods
- the signs of objects
layer1-228
human annotations
layer3-465
human annotations
- animal necks and legs
- shaggy dogs
- hair and similar patterns
layer3-817
human annotations
- fences, keys, and rulers
- objects with several lines
- animal, ruler, fence, piano
layer4-855
human annotations
- eyes, lamps, and purses
- household objects
- lights, lamps, and candles, and some animals
layer4-1436
human annotations
- person sitting on a bench, right side of a bird, headphones
- circular and striped object
- straight features
layer4-1694
human annotations
- truck, train, turtle, bandaid, bird on the beach
- circular objects and animals
- the colors blue and white
layer3-201
human annotations
- small light sources
- lights, eyes
- round bright things
layer3-344
human annotations
- coils of a snake, patches of a cheetah, a lab's neck, dog's ear and tail, a stacked group of cups
- snakes
- the corner of something
layer3-132
human annotations
- mouths of women and monkeys
- person, clock
- mouths of people
layer4-292
human annotations
- hands
- human hands
- animal, people, food
layer4-1259
human annotations
- animals, sticks and leashes
- an elongated item and then
- people and long thin sticks
layer4-1400
human annotations
- curved lines
- round objects
- curved features
layer1-167
human annotations
- stripes, poles and fences
- black and white lines
- car, animal, dirt
layer2-441
human annotations
- outlines of blue and yellow or red objects
- multicolored objects and eyes
- areas that have a gradient of three colors
layer4-156
human annotations
- diagonal lines and tables
- roads
- long, thin features in them
layer4-217
human annotations
- birds, crowds and circular objects
- rounded objects and birds
- cooking utensils, hat, nail, person
layer4-988
human annotations
- objects that are white
- balls, grass and white objects
- round objects
layer4-1019
human annotations
- animals and the sky
- long, thin objects
- brown dogs
layer2-391
human annotations
- words and grids
- sharks
- parts of words or parallel lines
layer2-449
human annotations
- a fox in the grass, a cat with it's head in a food dish
- blue or peach in them
- living objects
layer3-807
human annotations
- animals and sticks
- faces of men
- the border of an animal
layer4-369
human annotations
- food items and white surfaces
- animals and vehicles
- hands and shoulders
layer4-833
human annotations
- a boy is cooking food in a drum barrel, a women tosses apples in a bowl, a mural, bottom of a statue
- animals, and circle objects
- human arms, animals and objects that resemble arms
layer4-1073
human annotations
- syringes, graphics on a page, necklace
- cases, appliances, electronics and syringes
- hinges and red objects
layer4-351
human annotations
- animals, pillows, and metal objects
- green plants
- rounded edges in pictures
layer4-707
human annotations
- musical instruments, buckles and food
- images containing several lines
- instruments
layer4-1059
human annotations
- fur of animals and triangles
- animals, fences and bridges
- textured objects and objects with lines
layer2-2
human annotations
- spots of the color white and text
- white spots
- blue sand white patterns
layer4-169
human annotations
- circular objects and animals
- black and white objects
- round objects
layer1-18
human annotations
- a guitar strummed
- white thin lines
- dashes are in each item that are long and narrow
layer2-7
human annotations
- white circular objects
- white and light colored areas
- white lettering
layer3-597
human annotations
- shiny metal objects
- the color white
- in the middle of objects
layer4-223
human annotations
- striped objects
- striped articles of clothing
- striped items
layer4-1235
human annotations
- grass areas with animals
- grass
- vegetation and other textured backgrounds
layer4-1454
human annotations
- group of friends, spider, plough, bed frame
- fur texture and wheels
- wheels
layer3-289
human annotations
- colorful ships
- window like items
- things with windows
layer2-135
human annotations
- the color white in small, circular spheres
- dots, animals, and pillows
- land animals
layer3-815
human annotations
- body parts of people playing musical instruments
- musical instruments
- things in peoples mouth
layer4-1150
human annotations
- birds on the water, air conditioner, fish
- water, counters, and striped objects
- water and other rippled patterned surfaces
layer4-657
human annotations
- objects that have red, white, green, black, purple, pink and orange in them
- column shapes
- clothing bottoms
layer4-1401
human annotations
- animals and circular objects
- people holding onto objects
- person, vehicle, nature
layer2-369
human annotations
- button's on a remote
- person, animal, remote, button
- rounded edges in pictures
layer1-224
human annotations
- illuminated areas
- buckets and mugs
- specific patterns
layer3-134
human annotations
- brown objects surrounded by a background
- eyes
- parts that are round
layer4-268
human annotations
- rectangular objects
- logos on objects
- logo, bird, text
layer4-989
human annotations
- animals, cases, and electronics
- objects with dark and pale features
- fur
layer4-1309
human annotations
- objects on the floor
- remotes, cars, dishes and bottles
- mugs and bottles
layer1-37
human annotations
- areas of light or reflection
- animal through a chainlink fence, guard rails on a ship, text on a bottle
- small dots and lines
layer2-378
human annotations
- tropical colors
- left of a dog
- animal, person, shark, water
layer3-802
human annotations
- stripes and animal parts
- lines and stripes
- striped objects
layer4-167
human annotations
- animals
- animals
- legs and hands
layer4-947
human annotations
- thee are animals, peoples and metal objects
- brown animals
- animals and furniture
layer4-893
human annotations
- right side of a baby, a satellite dish, people on the water, section of a magazine, a girl sitting on a bench, a natural water sunaina
- animals, vehicles and reflective surfaces
- brown dogs
layer4-1937
human annotations
- a brown chihuahua dog laying in a red bed, a beetle on a green shirt, a black dog laying on the ground, a drill, a tan perfume bottle, a brown and black lizard eye, white handsome dispenser, a purple handsome dispenser, a silver handsome dispenser, wedding rings on hands, a silver microphone, a brown spider, a green leaf necklace, a black horned beetle, a doctors listening device
- items on other items
- rounded edges in pictures
layer2-332
human annotations
- sharks in the sea, a helmet, a bird on a stick
- animal, shark
- small text and fine details
layer3-248
human annotations
- bird on a branch, a person lifts weights
- dogs
- the space below animal
layer3-546
human annotations
- stick shaped things pointing up
- antenna
- antennae of bugs
layer4-77
human annotations
- animals and plants
- animals
- oval shaped things
layer4-1648
human annotations
- board, water, bench in the park, right side of a women's shoulder
- animals, circles and bricks
- objects with straight features
layer4-684
human annotations
- erecting towers and structures
- lighthouse
- towers
layer2-437
human annotations
- a shark through the ocean
- sharks
- nature, people, structure, animal
layer2-141
human annotations
- the images are showing backgrounds, whether they be the ground, sky or backdrops
- foxes
- above animals
layer3-863
human annotations
- blue and white corners of images
- the corners
- animals with spikes
layer4-305
human annotations
- vehicles with wheels
- wheels for vehicles
- people, bike, logo
layer4-1948
human annotations
- a bird that is flying, two friends pose for a photo, a dog on the sidewalk, kid pointing down
- animals and eggs
- dark areas next to pale areas
layer4-1076
human annotations
- animals, furniture and windows
- red objects
- animal, nature, car
layer2-299
human annotations
- mainly white surfaces, sometimes including red or black
- space beneath words
- boat, animal
layer1-213
human annotations
- repeating lines
- it contains closely set black and white stripes
- these images all share lines and small detail patterns
layer3-104
human annotations
- stripes and clothes
- people and their body parts
- similar patterns
layer4-203
human annotations
- animals heads and circular objects
- the heads of the objects
- curved items
layer4-572
human annotations
- animals and chains
- snacks and spiral objects
- items that are connected
layer4-1391
human annotations
- animals
- brown and white dogs
- animal, nature
layer4-1520
human annotations
- text on a memorial, dog, a flag in the background, a dog
- animals and food
- objects on top of other objects
layer2-256
human annotations
- small white light colored spots of objects
- text, projector, person, ball, keyboard
- the balls and cups are all circular
layer4-651
human annotations
- objects with straight lines
- a truck on the road, a table where you sit, cup handles, a rotary telephone
- rounded edges in pictures
layer4-1779
human annotations
- pen, vegetables
- cylinder objects
- items with straight features
layer4-302
human annotations
- animals and small insects
- animals and noodles
- brown animals
layer4-880
human annotations
- people, animals, and circular objects
- red hued objects
- hands of humans
layer4-1071
human annotations
- statue on a roof, a boats front stern, a dog in a bathroom, bugs, a bird on the grass, a dog on the beach
- animals
- animal eyes and high contrast zones
layer4-1741
human annotations
- left side of a man and women, a bug, a horse going down the road, tree
- items with straight features
- rounded edges in pictures
layer2-359
human annotations
- space towards a dog's paw
- animal legs and flowers
- car, grass, animal
layer3-13
human annotations
- people wearing costume, space arond the text of a sign, fruits and vegetables, text around the letters of a sign
- thee are pink and white objects
- patterns
layer4-86
human annotations
- animals and produce
- animals that are brown
- objects with points in them
layer2-122
human annotations
- yellow dots
- the surface's are many different shapes and sizes
- events
layer3-411
human annotations
- tall grasses
- tall grass, mostly green, some dried and brown
- grassy areas
layer4-553
human annotations
- wooden objects and the sky as a background
- vehicles, palettes and buildings
- houses and animals and sky
layer4-985
human annotations
- arch shape on animals and things
- parachutes, animals and curved objects
- object against a background
layer4-1063
human annotations
- grid patterns on surfaces
- older buildings and alleyways
- building, person
layer2-399
human annotations
- a group of people viewing an aquarium, dogs or animals posing for photo, a snake in the grass
- green grass and dogs
- green
layer3-782
human annotations
- animals, vehicles and fences
- shaggy brown dogs
- the backs of animals
layer4-1031
human annotations
- bandaid, text on a package, microphone
- bandaids, furniture, birds and umbrellas
- angles
layer2-84
human annotations
- brown dogs
- fabrics, fur or light contents in an image
- front of objects
layer3-867
human annotations
- hair, feathers and fur
- eyes of different animals
- objects with a spray shape
layer4-1562
human annotations
- a chair in the grass, a whale in the water, a beetle, a grill on a porch
- vehicles, furniture and instruments
- this region has items with straight features
layer2-363
human annotations
- a pig in a toff, a bunch of animals outside in the snow
- white boarders of animal photos
- animal
layer2-177
human annotations
- symmetrical patterns
- repeating holes and gaps
- similar patterns
layer3-598
human annotations
- striped objects
- colored stripes
- striped pattern on objects
layer4-291
human annotations
- animals and towers
- black dogs
- two objects that have a connection
layer4-1279
human annotations
- animals, lamps, balls, and trains
- household objects
- rounded
layer4-1121
human annotations
- tennis racket, guitar, group of girls
- people, balls and pics
- rounded items
layer4-1881
human annotations
- faces of animals with fur
- a kid posing for a photo, a bear in the water, a dog smiling, a platypus, a bird
- items with items projecting from them
layer2-438
human annotations
- orange and yellow colors
- butterfly in a dish
- patterns
layer2-73
human annotations
- fences and poles
- red tips of objects
- brighter areas within objects
layer4-105
human annotations
- appliances, vests and dogs
- shaggy dogs that are brown
- animals and electronics
layer4-797
human annotations
- animals and buildings
- animal heads and buildings
- brown dogs
layer4-1548
human annotations
- people, dogs, vehicles and appliances
- eyes of humans
- ears
layer4-1484
human annotations
- a tick, food, a kid holding a cup, a spider on a log
- of the images presented contain green or tan colors in them
- green areas in picture
layer2-88
human annotations
- repeating parallel lines
- a bird in the jungle, a set of knives on a table, the top of a fire track, a group of clothes
- specific patterns
layer3-364
human annotations
- animals looking around in various directions in photos
- animal necks
- animal necks
layer3-872
human annotations
- yellow dots
- yellow dots and areas on objects
- toaster, re, bird, boar, logo, plane
layer3-749
human annotations
- jagged edges of objects
- areas with corners
- rectangular blue objects
layer4-1088
human annotations
- musician's up on stage, people in a suit or a white shirt, thumb on a camera
- people
- this region contains body parts
layer4-1428
human annotations
- buildings, bridges and appliances
- items with straight features
- structure, vehicle
layer2-487
human annotations
- spots of the color white and red
- lizard's face
- land animals
layer1-240
human annotations
- white outlines of objects
- black and white stripes
- similar patterns
layer4-360
human annotations
- animals and electronics
- textured area
- screens of devices
layer4-299
human annotations
- animals and orange objects
- land animals and produce
- insect, animal, food
layer4-1411
human annotations
- black and white birds
- sports related
- balls that are used for different sports
layer4-1039
human annotations
- animals with spotted patterns
- animals and circular objects
- spotted animals
layer2-502
human annotations
- a horizontal line formed by light and dark areas
- a person looking off in the distance, a dog poses for a photo, a hummingbird takes a drink of a flower, a shark in the water
- dogs
layer2-482
human annotations
- spots of different colors
- are bottom outlines of objects
- lighter areas
layer3-859
human annotations
- hands and cylinders
- features composed of curved lines
- bottles that are colorful
layer3-720
human annotations
- animals, poles, and clothes
- lines found on objects
- dark bugs
layer4-1631
human annotations
- buildings, wall, and grass
- areas with grid patterns
- backgrounds in pictures
layer4-1098
human annotations
- animals and statues
- textured surfaces
- brown animals
layer3-164
human annotations
- striped and scaled animals
- patterns on animals bodies
- a shell like pattern
layer2-38
human annotations
- spots of the color white and gray in animals
- animal, person, fence, my player
- lighter areas
layer4-835
human annotations
- food, a dog playing wiht his toy, a water bottle on the rocks ,a baseball players glove
- hands and things they hold
- items with straight, long features
layer4-1261
human annotations
- a dog holding a toy, a bird moving through the water, a front of a school bus, a dog walking down a bridge, right side of a dog, a dress someone is wearing
- animals, people and grates
- front of objects
layer3-63
human annotations
- blue ocean water
- the blue/green ocean water, sandy ocean shore & a jagged rock cliff with a person standing on the edge
- blue areas in pictures
layer2-65
human annotations
- blue objects
- yellow and brown animals
- contain half of two colors
layer4-326
human annotations
- animals, trees and water
- animals and furry or textured objects
- two items that are connected
layer4-794
human annotations
- stone structures
- animals, doors, buildings and rocks
- red and brown areas
layer4-1680
human annotations
- fruit from a tree, person lifting weights
- two items connected
- similar color patterns
layer4-1114
human annotations
- animals, trains, electronics, and ceramics
- white objects
- subway, led, barrel, animal
layer2-17
human annotations
- blue border of images
- brown animals
- above the subject
layer2-407
human annotations
- bottom of a printer tray, side of a car
- red objects
- orange areas in picture
layer3-668
human annotations
- animals, electronics and cars
- long and skinny objects
- lines and edges and borders
layer3-822
human annotations
- towers and tails
- tops of towers
- things that are pointed; more specifically, pointed things where the sharp end is pointed upward
layer4-1468
human annotations
- animals, buttons, colors and buckles
- brown animals and salamanders
- striped in a curved or coil pattern
layer4-919
human annotations
- these re people
- white and pink shirts
- human faces
layer4-65
human annotations
- dog and human faces
- area where mouth is
- animals and people
layer4-1234
human annotations
- animals, vehicles and water
- bugs and vehicles
- people and trees and bugs
layer4-330
human annotations
- a curved line
- objects with holes in the middle or noses
- a circle in them
layer4-1722
human annotations
- faces, balls and round objects
- rounded
- black on white
layer1-217
human annotations
- sharks in the water, dogs posing for a photo, flocks of birds in the sky. text of a syringe
- the lines around the edges are not strait
- under dark colors
layer2-496
human annotations
- black dots surrounded by a single color
- dots and holes
- patterns
layer4-245
human annotations
- animals, socks, and poles
- socks
- living objects sitting on objects
layer3-869
human annotations
- animals and shiny metal objects
- heads of furry animals
- include the tops of areas
layer4-1038
human annotations
- buckles, windows and animals
- metal objects and animals
- metal objects
layer4-1950
human annotations
- people
- human hands
- babies and other small animals
layer3-277
human annotations
- food, people, or animals, or objects in a collage of photos
- an area where several different types of food are touching
- groups of things
layer1-185
human annotations
- objects bordering blue
- outlines of part blue areas
- brighter areas in objects
layer3-604
human annotations
- animal noses and beaks
- bird beaks
- beaks of birds and light green objects
layer4-75
human annotations
- animals, frosting and buildings
- snouts of dogs and other animals
- animals
layer4-917
human annotations
- animal
- animals and circular objects
- animals, people
layer4-1395
human annotations
- dogs, buildings, vehicles and wheels
- animals, people, vehicles, and consumer products
- areas with openings
layer2-473
human annotations
- spots of the color white
- keys of a keyboard
- bugs and birds
layer3-15
human annotations
- the corners of the background
- monkeys
- area above objects
layer3-816
human annotations
- animals
- faces of different animals
- the sides and cheeks of animals
layer4-1160
human annotations
- animals, armor, smoke and violins
- older armor
- curved things
layer4-1117
human annotations
- mouse trap, a person holding a bird
- hands
- rounded edges in pictures
layer4-1104
human annotations
- a basket of fruit, a scarecrow outside, a man with a red shirt, a man on a boat
- red objects
- produce and flowers
layer1-179
human annotations
- whale in some water
- words, baskets and sticks
- sharks and the ocean
layer2-18
human annotations
- spots of the color white
- white outs between stripes
- dogs
layer4-638
human annotations
- these white objects
- corners of white objects
- rounded edges in pictures
layer3-871
human annotations
- food
- tan food
- a variety of tasty looking food
layer4-1822
human annotations
- baskets, animals, toys and furniture
- squared items
- edges of objects
layer4-1067
human annotations
- water and chickens
- water
- landscapes
layer3-291
human annotations
- tops of a mushroom, fur of a dog, a snake charmer, a sign on these of a wall, text on the side of a boat, a person playing a flute
- the tops of the object or sign
- dogs and wood instruments
layer2-181
human annotations
- blue and green objects
- blue green in color
- blue areas in pictures
layer4-410
human annotations
layer4-1060
human annotations
- a flag ole, a bell tower, a thing of wash, a fax an printer, a bunny in a measuring cup
- objects with horizontal lines
- multiple items that are similar
layer4-1122
human annotations
- corners of a pan, person on a web page, dog on the carpet
- dogs and tan food
- animal, food
layer2-401
human annotations
- animals galore outside!
- the sky
- monkeys
layer2-39
human annotations
- red objects
- articles of red clothing
- red objects
layer3-812
human annotations
- faces and purple objects
- human faces
- people, ceiling, wall, animal
layer3-900
human annotations
- books and striped objects
- cylinders and similar shapes
- metal drums
layer4-653
human annotations
- balls, animals, and electronics
- dogs and balls
- things with names on it
layer4-1991
human annotations
- bird, cloud in the sky, monkey, crab
- animals, parachutes and eggs
- living creatures
layer3-18
human annotations
- heads
- faces of people
- faces of people
layer2-158
human annotations
- pale spots
- two colors in them
- specific patterns
layer4-460
human annotations
- fabric and other textured surfaces
- clothes
- similar patterns
layer4-562
human annotations
- bugs and birds
- include an animal or plant
- arms of people
layer4-1642
human annotations
- a women's shorts, a dog a women is holding, a alligator in the water
- underneath objects
- clothing, animal
conv1-37
human annotations
- white backgrounds
- space above a double decker bus, logo
- logo, bus
layer1-35
human annotations
- these images all share black outlines in common
- gauge, clock
- blue things
layer4-12
human annotations
- clocks and wooden structures
- clocks and industrial roofing
- structures or faces
layer3-534
human annotations
- numbers, dots and keys
- squiggles
- instrument, numbers, animal
layer4-495
human annotations
- city buildings with , right top side of a computer desk, a musician on stage. a water tower, a menu of food
- walls, buildings, vehicles and people
- musicians
layer4-696
human annotations
- shirts, bandaids, vehicles and pots
- fabric
- people, clothing
layer4-1807
human annotations
- tie, armor, insects
- below the objects
- similar color patterns
conv1-32
human annotations
- a roller with a zoomed in view, a boat on the water with a rock clif in the background
- the white edges along things
- pattern shaped objects
layer3-425
human annotations
- yellow spots and repeating colors
- red areas on animals and objects
- orange areas in picture
layer2-276
human annotations
- spots of white on objects
- a rounded shape in them
- rounded edges in pictures
layer4-462
human annotations
- animals and tents
- two items that are connected
- rounded edges in pictures
layer4-1167
human annotations
- black animals and birds
- animals and wooden poles
- birds and a dog
layer4-1607
human annotations
- musicians up on stage, the waist of a person, a person with a meaning cup. food on a plate
- reflective objects
- multiple items that are similar
layer4-1727
human annotations
- a blimp, lengthy objects including spoon handles, paintbrush, magnifying glass handle, wooden stool legs, plane arm, pens, candles, flute and tailpipes
- a woman holding a flute, blimp in the air, pen, left side of a sign
- long and thin
layer2-504
human annotations
- pigs on the ground, plant life, cows in a pasture
- land animals
- light colored areas on the side
layer4-341
human annotations
- boat's haul, design on a shirt, vaccum, a turtle
- vehicles, birds and cups
- the front of boats
layer4-1597
human annotations
- dogs and balls
- white dogs
- person, nature, ball, animal
layer3-980
human annotations
- edges and boundaries with grass
- black patterned fabric
- lime green
layer4-622
human annotations
- animals and dots
- animals
- dogs
layer4-1684
human annotations
- dogs, screens, and trucks
- heads of animals, a microwave door and a longed truck
- two items that are alike
layer2-124
human annotations
- spots of the color white
- rows of shoes
- brighter areas in objects
layer2-81
human annotations
- a ferry wheel, a race car going down thatjack, a tripod lense, a tank, a my player
- pale spots next to dark areas
- white dots
layer4-454
human annotations
- bottles
- items that are on other objects
- person, leash
layer3-727
human annotations
- outlines of objects and animals
- areas with whiskers and strings
- regions are on the sides of objects
layer4-1118
human annotations
- coffee cup, bowl's handle, bench
- handles and saws
- two items that are connected
layer4-743
human annotations
- circular, gray objects
- circular objects and animals
- round objects
layer3-359
human annotations
- thorns and pricks
- a heart made from glow sticks, a speedometer, a ferris wheel, a hot airball, left and right side of a dog
- stems and legs
layer2-54
human annotations
- white and black edges
- necks of birds
- brighter areas in objects
layer4-252
human annotations
- animals and bullets
- green grass
- animals
layer4-310
human annotations
- wheels, shelves and people
- objects with steps or different levels
- squared areas
layer4-1580
human annotations
- structures, vehicles and objects
- ocean water
- animals, tank, car, person
layer4-1094
human annotations
- text on a wallet, fruit, a mouse trap, hands, a bird
- fingers, boards, and bricks
- human hands
layer1-254
human annotations
- horizontal white lines
- lettering and oceans
- specific patterns
layer4-411
human annotations
- back of a laptop, a front side of a book, a keyboard on a laptop clock on the face of a wall, a music book someone is looking at, a
- hinges of objects
- men and women's are watching laptop
layer4-940
human annotations
- square objects with text
- electronics, watches and plaques
- cameras and watches
layer1-231
human annotations
- spots of animals and the color white
- sharks
- the images have white in them
layer3-413
human annotations
- small colorful balls
- the things that look like chains or thighs
- things that are lined
layer4-238
human annotations
- corners of furniture, walls, food and animals
- dogs and pizzas
- objects with corners
layer4-712
human annotations
- objects with swirls and lines
- animals, cords, and ornate designs
- yellow objects and snakes
layer4-1425
human annotations
- lower part of human bodies
- torsos of several different people
- the joints of people
layer2-297
human annotations
- bird, dress, computer screen
- textured areas
- snake in the places
layer3-1007
human annotations
- feet and pendants
- hands of animals
- jewelry and the paws of animals
layer3-92
human annotations
- shiny areas of wood and animals
- wooden flooring
- wood or feather
layer4-977
human annotations
- objects made up of multiple holes
- things with dots
- items with perforations
layer4-1496
human annotations
- wheels
- people and vehicles
- two items that are connected
layer4-1797
human annotations
- face of a women, womens shoulder, deer, bear
- living things
- people
layer2-330
human annotations
- a dog stand by a chair, space on the lobster attend
- tips, ends and edges of things or parts of circles
- nature, people, structure
layer4-6
human annotations
- older castles that are european
- brick towers that are on buildings
- front of objects
layer3-105
human annotations
- curbed objects like bowls and wheels
- wheels of vehicles
- things touching each other
layer4-744
human annotations
- animals, electronics and signs
- dogs
- rounded items
layer4-858
human annotations
- animals, furniture, hats and tools
- human hands
- rounded edges in pictures
layer4-1803
human annotations
- rope, knife, food in market, ducks in a pond
- items with designs
- animals, people
layer2-360
human annotations
- yellow produce
- grated patterned areas or orange things
- animal, corn, pumpkin, tire
layer3-314
human annotations
- plants in a flowerpot
- flowers and other plant life
- shrubbery with colorful flowers
layer2-250
human annotations
- diagonal lines, sticks and flower petals
- pink flowers
- area in between patterns
layer4-391
human annotations
- animals, birds and cookware
- green
- green areas in picture
layer4-949
human annotations
- corner of a maze, a guy holding up large crabs, a man cooking food outside, left side of monitor
- things with 90 degree angles
- edges of objects
layer4-1958
human annotations
- people, vehicles and poles
- objects or surfaces with lines
- metal poles and instruments
layer4-1909
human annotations
- dogs, food
- animals, food and bottles
- items that are connected
layer1-16
human annotations
- a dog on sand
- legs and wheels
- the insects and animals have angles and curves outlining their body
layer3-176
human annotations
- a snake in the grass, a person riding a moped
- stripes of different colors
- lines and stripes on animals and people
layer3-783
human annotations
- tiles and bricks
- shaped like bricks
- repeating grid-like patterns
layer4-15
human annotations
- insects and animals
- bugs
- pictures of animals
layer4-832
human annotations
- birds and hands of people
- animals, sticks and handles
- people holding up objects
layer4-1264
human annotations
- poles and animals
- objects with red and brown hues
- skinny wooden poles
layer4-1868
human annotations
- parking meter, boots, dog
- people, dogs, and poles
- peoples hands
layer3-276
human annotations
- birds on a branch, insects, a blimp, a quill pen
- cone and beaked objects
- have a pointed tip
layer2-211
human annotations
- lines that diverge and make a gap
- red articles of clothing
- edges of objects
layer4-122
human annotations
- bowties and cameras
- chins of humans
- things that tie together
layer4-336
human annotations
- animals, food and cups
- hands of people
- include objects with curved areas
layer4-1252
human annotations
- animals, mail boxes, shoes and bottles
- dogs
- rounded edges in pictures
layer4-1656
human annotations
- coils, stripes, and steps
- stripes
- spiral objects
layer1-153
human annotations
- a group of people playing drugs, animals posing for a photo, a bird, a meerkat, mouse, a dog looking out into the street
- tiny bits of color
- green tree
layer3-49
human annotations
- man made structures and vehicles
- hot air balloons
- spotted areas in pictures
layer3-609
human annotations
- drawings, people and pedometers
- areas separated by dark lines
- cartoon decorations
layer4-643
human annotations
- animals, fruit and legs
- shaggy dogs
- these objects have rounded bodies
layer4-1236
human annotations
- animals and curved lines
- boats, cars, roads, shoes and swings
- boats on the water
layer4-1487
human annotations
- dogs running in the snow, a bug walking alog a tree, a lizard on a branch, a dog on the pavement, a bird in the snow, a man wearing a green shirt, a person holding a fish
- animals
- living things
layer2-357
human annotations
- outlines of items
- nothing highlighted
- person, car, window, animal
layer1-42
human annotations
- a cat with its tail wrapped around
- dots around words and corners
- small white dots
layer3-111
human annotations
- objects with gaps and holes
- parts of signs, furniture and electronics
- green cabinets
layer4-180
human annotations
- animals and circular objects
- white shirts
- center area of a body
layer4-1226
human annotations
- musicians up on stage, a air dryer, a football helmet, sides of a light, front of a car, a cat on the counter
- ties, light sources and circular objects
- household objects
layer4-711
human annotations
- dogs and humans standing
- dogs and people
- brown dogs
layer4-1908
human annotations
- colorful objects that are red green pink or orange and an animal
- items with lines
- similar color patterns
layer2-130
human annotations
- pale or lightest areas on objects
- dark colored shirts
- certain patterns
layer3-921
human annotations
- sloped roofs and dishes
- hooves
- rooftops of buildings
layer4-380
human annotations
- trucks and buses
- vehicles and robots
- areas with straight lines
layer4-1048
human annotations
- people, animals, and metal objects
- shirts on people
- animal, nature
layer4-1110
human annotations
- a satellite dish, a person in a tent, a baby eating food, a crane, a mountain range
- curved creatures
- curved items
conv1-51
human annotations
- parts on a speedometer
- white outlines of objects
- gauge, animal, ball, stripes
layer1-196
human annotations
- apples on a cloth
- patterned clothing
- patterns
layer3-163
human annotations
- green and white areas
- items that all have a rounded surface to them
- green, cream, and white
layer3-829
human annotations
- metal objects
- skinny rods
- ling items with lines across like bamboo
layer4-813
human annotations
- cylindrical objects
- human hands
- vertical line patterns
layer4-864
human annotations
- animals and triangular objects
- triangular objects
- dogs and sailboats
layer3-225
human annotations
- poles, leashes and other vertical lines
- perforated metal poles
- person, clothing, sign
layer1-49
human annotations
- areas of light, or reflected light
- letters of a clock
- black numbers and letters
layer3-146
human annotations
- the corners of cylinders
- metal household objects
- parts of rounded things
layer3-558
human annotations
- light reflection
- sources of light
- circles around an object
layer4-910
human annotations
- people holding things near their face
- towers, animals and food
- people holding something to their mouths
layer4-1493
human annotations
- text on a sign, sky, dog, drill, person sitting on a bench
- people and circular objects
- backgrounds